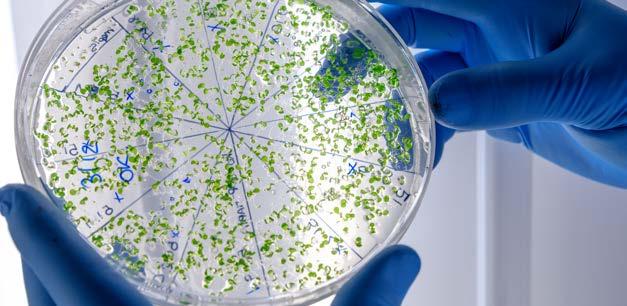

SPECTRUM

Ar įmanoma prognozuoti savižudybės riziką?
![]()

Ar įmanoma prognozuoti savižudybės riziką?
2
8
14
20
26
32
Miego paralyžius – traumuojanti patirtis ar tiltas į sąmoningą sapnavimą?
Asteroidų medžiotojas dr. Kazimieras Černis: vardo suteikimo asteroidui procesas gali trukti ir dešimtmečius
Kaip atpažinti imituojamą tvarumą?
Mokslininkų tiriami biožymenys gali padėti prognozuoti savižudybės riziką
Pagal naują metodiką matematikos mokytis gali dar nė neskaitantys darželinukai
Kodėl svarbu kalbėti apie tai, kas neįvyko?
Naujas Vilniaus veidas: humoro akcentai kuriant miesto įvaizdį 38
Nedidelių pelyčių smegenys gelbsti didelius homo sapiens protus
58
Galingos Saulės audros gali padovanoti gražiausias Šiaurės pašvaistes, bet ir palikti mėnesiui be elektros
Labai reti žodžiai – ką jie sako apie mūsų kalbą?
Dirbtinio intelekto vaidmenys mene – įkvėpėjas, vykdytojas ir kūrybinis partneris
Vilniaus regiono „proveržiui“ įtakos turėjo estų patirti dideli ekonominiai sunkumai 70
Cheminės reakcijos valdymas ląstelėje: kodėl „click“ technologija nusipelnė Nobelio premijos? 76
Kaip mikromobilumo sprendimai keičia miestus ir jų ekonomiką? 82
Mikrobiotos tyrimai ateityje gali padėti įveikti kvėpavimo sistemos ligas 88
Naujausias reikalavimas dirbtiniam intelektui – gerbti žmogaus teises
Liudmila Januškevičienė Vilniaus universitetas
„Nubudau vidurnaktį iš paniškos baimės, kuri persmelkė visą kūną, pamačiau juodą per langą lipančios būtybės siluetą, kuris artėjo prie manęs. Bandžiau rėkti, bet nepavyko išleisti nė garso, kūnas buvo visiškai paralyžiuotas. Apėmė panika, nes nieko negalėjau padaryti: nei piršto pajudinti, nei rėkti. Jausmas toks, lyg miršti.“ Tokią būseną, vadinamą miego paralyžiumi, bent kartą savo gyvenime patiria nuo 7,6 iki 30 proc. žmonių visame pasaulyje, priklausomai nuo kultūrinio, aplinkos ar asmenybinio konteksto, tvirtina psichologas, sapnų tyrėjas, Vilniaus universiteto Filosofijos fakulteto docentas Tadas Stumbrys ir gydytoja neurologė, Medicinos fakulteto profesorė Rūta Mameniškienė.

Baisi, bet gyvybei nepavojinga patirtis
Pirmieji miego paralyžiaus epizodai dažnai žmones ištinka dar vaikystėje.
Paauglystėje ir sulaukus 20–30 metų jie gali pasikartoti dažniau.
„Miego paralyžiaus epizodo metu žmogus aiškiai suvokia aplinką, bet negali judėti ir kalbėti. Gali tik judinti akis ir kvėpuoti. Daugelis žmonių girdi arba mato dalykus, kurių nėra – haliucinacijas, todėl epizodai tampa dar baisesni. Epizodas trunka nuo kelių sekundžių iki kelių minučių“, – apie potyrius miego paralyžiaus metu pasakoja prof. R. Mameniškienė.
Mokslininkai aiškina, kad miego paralyžius, dar vadinamas viena iš greitų akių judesių (rapid eye movement –REM) miego parasomnijų, žmogų ištinka iš dalies sutapus REM miego ir būdravimo būsenoms, kada smegenys yra aktyvios, o viso kūno raumenys (išskyrus akis) būna atoniški (be tonuso) – tarsi paralyžiuoti, nejudrūs. Šis laikinas raumenų paralyžius REM miego metu yra normalus ir natūralus, nes apsaugo mus nuo aktyvaus dalyvavimo sapne, o kartu ir nuo susižalojimo, bet tuo metu nubudus smarkiai sutrikdo.
„Miego paralyžiaus metu mes esame tarsi tarpinės būsenos tarp REM miego
ir būdravimo. Prieš kelerius metus tyrėjai miego laboratorijoje užfiksavo keletą tokios būsenos epizodų ir nutarė pagal smegenų aktyvumą įvertinti, ką ši būsena labiau primena – ar būdravimą, ar REM miegą, kai mes ryškiausiai sapnuojame. Būsena pasirodė artimesnė REM miegui nei būdravimui. Tai reiškia, kad tokių epizodų metu žmogus labiau sapnuoja, nei yra pabudęs. Jam atrodo, kad jis yra pabudęs, guli savo miegamajame ir yra apimtas siaubo, bet iš tiesų ta erdvė būna susipynusi su sapnu“, –tikina psichologas doc. T. Stumbrys. Neuromokslininkė patikslina, kad miego paralyžius ištinka, kai atgauname sąmoningumą pereidami į REM miego fazę arba iš jos išeidami. Todėl miego paralyžių patiriantieji nurodo, kad šie baisūs epizodai jiems pasireiškia užmiegant arba prieš nubundant. Nepaisant miego paralyžiaus metu patiriamos stingdančios baimės ir minčių, kad miršti, ši pavienė patirtis, pasak pašnekovų, yra visiškai nepavojinga nei sveikatai, nei gyvybei. Tačiau, kaip tvirtina gydytoja neurologė prof. R. Mameniškienė, kai kuriais atvejais miego paralyžius gali signalizuoti apie tam tikras ligas: „Pavyzdžiui, jeigu miego paralyžiaus epizodai kartojasi ir yra kitų simptomų (nenu-

Daugelis žmonių girdi arba mato dalykus, kurių nėra –haliucinacijas, todėl epizodai tampa dar baisesni.
Įsibrovėlio haliucinacijos
Inkubo haliucinacijos
Neįprastos kūno patirtys
Jaučiamas pavojus arba svetimo asmens buvimas patalpoje
Dūstama, spaudžia krūtinę ir neįstengiama kalbėti
1 pav. Haliucinacijų miego paralyžiaus metu tipai
Miego paralyžius gali signalizuoti apie tam tikras ligas.
maldomi miego priepuoliai dienos metu, staigus galūnių ar viso kūno raumenų silpnumas veikiant emocijoms, garsus knarkimas su kvėpavimo sustojimu), žmogui galima įtarti tokias ligas kaip narkolepsija ar obstrukcinė miego apnėja.“
Kaip nesupainioti su kita būsena?
Miego paralyžių sunku supainioti su kitu miego sutrikimu ar sapnavimu, nes maždaug 75 proc. šių epizodų metu būna patiriamos haliucinacijos, kurios skiriasi nuo įprastų sapnų. Jos pasireiškia kaip hipnagoginės (užmiegant) arba hipnopompinės (pabundant) haliucinacijos.
„Miego paralyžiaus metu žmogus galvoja, kad jis yra pabudęs, bet fiziologiškai veikia REM miego etapui būdingas raumenų paralyžius ir žmogus patiria haliucinacinius vaizdinius. Paprastai išskiriami trys haliucinacijų, kurias žmonės patiria ištikus miego paralyžiui, tipai“, – pasakoja doc. T. Stumbrys.
Įsibrovėlio haliucinacijos metu žmogus jaučia pavojingo ar tiesiog svetimo asmens buvimą kambaryje. Jis gali girdėti balsus, matyti judesius (1 pav.).
Kitas vaizdinys, būdingas miego paralyžiui, yra inkubo (lot. incubus – „gultis ant viršaus“) haliucinacija , arba
Jaučiama, kaip kūnas atsiskiria ir pakyla
dusimo jausmas. Psichologas pasakoja, kad tuo metu atrodo, jog demonas ar kažkas kitas spaudžia krūtinę, bando pasmaugti, žmogus negali kvėpuoti, negali išleisti nė garso.
Trečias haliucinacijų tipas yra neįprastos kūno patirtys. Žmogus gali jausti, kaip jo kūnas atsiskiria ir pakyla (vadinamosios išėjimo iš kūno patirtys), jį gali tarsi purtyti elektra ir pan.
Pasak sapnų tyrėjo doc. T. Stumbrio, kai žmonės susiduria su tuo pirmą kartą ir nelabai žino, kas su jais vyksta, tai iš tiesų gali atrodyti grėsmingai, nes šios patirtys yra labai stiprios ir atrodo labai realios – po jų žmonės gali net bijoti eiti miegoti.
„Tačiau įdomu, kad tam tikras, nors ir labai mažas, procentas miego paralyžiaus patirčių gali būti ir malonios. Asmuo gali jausti, kad kažkokia patraukli priešingos lyties būtybė yra šalia, ir jam tai yra maloni patirtis. Tai gali būti susiję ir su REM fazės metu natūraliai patiriamu seksualiniu susijaudinimu“, – sako psichologas.
Dvi strategijos išeiti iš miego paralyžiaus
Paklausus, kaip padėti sau išeiti iš dažniausiai nemalonaus ir bauginančio miego paralyžiaus epizodo, medikė sako, kad nėra gydymo būdų, galinčių
greitai ir efektyviai sustabdyti tokias patirtis, tačiau dauguma jas patyrusių žmonių teigia, jog susitelkimas į mažus kūno judesius (pvz., vieno piršto judinimą, paskui kito) padeda greičiau atsigauti: „Šalia esančio asmens prisilietimas ar apkabinimas taip pat gali padėti greičiau atgauti motorinį raumenų aktyvumą, todėl galima paprašyti, kad lovos draugas apkabintų tiek prieš užmiegant, tiek iškart pabudęs.“
Doc. T. Stumbrio teigimu, yra du keliai, kuriais mes galime išeiti iš miego paralyžiaus būsenos. Dažniausiai žmonės, ypač su tuo susiduriantys pirmą kartą, bando pajudinti save, prabudinti.
Tam tikras, nors ir labai mažas, procentas miego paralyžiaus patirčių gali būti ir malonios.
„Bet yra ir kitas kelias – pamėginti eiti į kitą pusę: nebandyti savęs pažadinti, o atsipalaiduoti ir keliauti atgal į REM miegą. Šitaip, nepraradę sąmoningumo, mes atsidursime sapne. Taigi miego paralyžius gali būti tiltas į sąmoningą sapnavimą – yra žmonių, praktikuojančių šį metodą, kad patirtų sąmoningo sapnavimo būseną“, –atskleidžia sapnų tyrėjas.
Jis priduria, kad tam nereikia nieko žinoti ar aktyviai praktikuoti sąmoningo sapnavimo technikų. Tereikia suprasti ir atpažinti, kad dabar yra ištikęs miego paralyžiaus epizodas, kad patiriami baisūs dalykai yra tik haliucinacijos ir kad jei nebandysi
savęs pažadinti, o pasistengsi maksimaliai atsipalaiduoti, galėsi pereiti į sapną išlaikydamas sąmoningumą.
Kas dažniausiai patiria miego paralyžių?
Doc. T. Stumbrys sako, kad žmonės, praktikuojantys sąmoningą sapnavimą, dažniau gali išgyventi miego paralyžiaus epizodus. Kaip ir tie, kurie linkę patirti miego paralyžių, turi daugiau galimybių pereiti į kitas tarp sapno ir būdravimo esančias būsenas, tokias kaip sąmoningas sapnavimas, išėjimas iš kūno ar klaidingas atsibudimas.

Žmonės, miegantys ant nugaros, net keletą kartų dažniau patiria miego paralyžių nei miegantys kitomis pozomis.

Nors tiesioginio priežastinio ryšio tarp tam tikrų rizikos veiksnių ir miego paralyžiaus tyrimais nenustatyta, tačiau dirbdama su pacientais gydytoja neurologė prof. R. Mameniškienė yra pastebėjusi, kad su miego paralyžiumi susiję įvairūs nerimo sutrikimai, prasta miego kokybė, miego trūkumas, pamaininis darbas, alkoholio vartojimas, traumuojantys įvykiai ir miego paralyžiaus šeimoje atvejai. „Yra nustatytas šeiminis ryšys, o tai rodo genetinį polinkį į šią ligą. Miego paralyžius dažnai lydi miego ligas –narkolepsiją (liga, pasižyminti staigiais miego priepuoliais) ir obstrukcinę miego apnėją (pasikartojantys kvėpavimo sustojimai miegant). Didelė dalis pacientų sako, kad prieš epizodus jų gyvenime būna stresinių įvykių, pasikeičia gyvenimo ir darbo grafikas arba jie patiria emocinių išgyvenimų. Vyrus šis reiškinys ištinka šiek tiek rečiau nei moteris“, – paaiškina gydytoja.
Psichologas doc. T. Stumbrys priduria, kad net miego poza gali lemti miego paralyžiaus epizodų dažnį. „Žmonės, miegantys ant nugaros, net keletą
kartų dažniau patiria miego paralyžių nei miegantys kitomis pozomis. Be to, šie epizodai dažniau ištinka žmones, kurie miega fragmentiškai, t. y. naktį dažnai prabunda. Pavyzdžiui, miego paralyžių galima sukelti miego laboratorijoje, jei tiriamas žmogus dažnai žadinamas. Be to, kaip ir dauguma miego sutrikimų, šis irgi susijęs su emocine būsena ir jai pablogėjus gali suintensyvėti.“
Gydytoja neurologė tvirtina, kad vienas iš veiksmingiausių būdų išvengti miego paralyžiaus – pagerinti miego kokybę: „Tai galima padaryti nusistačius reguliarų miego grafiką su konkrečiu laiku, kada einama miegoti ir kada atsibundama. Rekomenduojama susikurti patogią miego aplinką, kurioje būtų tamsu ir ramu. Prieš miegą geriau nesinaudoti telefonu, planšete, elektroninėmis skaityklėmis ir kompiuteriu, o atsipalaiduoti maudantis vonioje, skaitant knygą ar klausantis ramios muzikos. Taip pat reikėtų nevartoti alkoholio ir narkotinių medžiagų.“
ASTEROIDŲ VARDAI
Benita Kaselytė Vilniaus universitetas
„Siekiame, kad kosmose būtų kuo daugiau lietuviškų pavadinimų“, – sako Vilniaus universiteto Fizikos fakulteto mokslininkas dr. Kazimieras Černis –daugiausia asteroidų ir kometų atradęs Lietuvos astronomas. Naujõs mažosios planetos – asteroido atradėjas turi galimybę dangaus kūnui suteikti vardą. Dr. K. Černis yra pavadinęs apie 200 asteroidų.
Visiems savo atrastiems dangaus kūnams mokslininkas stengiasi suteikti lietuviškus vardus, todėl lietuviškų asteroidų pavadinimų kosmose vis daugėja. Mažosioms planetoms dr. K. Černis jau yra suteikęs Lietuvos kunigaikščių, miestų ir istorinių asmenybių vardus.

Kas yra asteroidai?
Asteroidai, arba mažosios planetos –tai mažieji dangaus kūnai, skriejantys elipsine orbita aplink Saulę. Šie dangaus kūnai kosmose juda įspūdingu 20–30 kilometrų per sekundę greičiu ir Saulę apskrieja per 4–5 metus. Saulės sistemoje atrasta daugiau kaip trys šimtai tūkstančių asteroidų. Jie yra uolingos, metalinės ar mišrios sudėties, daug mažesni už planetas. Asteroidų skersmuo gali varijuoti nuo kelių metrų iki kelių šimtų kilometrų.
Manoma, kad asteroidai yra liekanos iš tų laikų, kai Saulės sistema dar tik formavosi. Jie nesudarė planetų, nes jų masė – per maža. Didžioji dalis asteroidų yra susitelkusi pagrindinėje asteroidų juostoje, esančioje
tarp Marso ir Jupiterio orbitų. Tačiau yra ir kitų asteroidų grupių, tokių kaip Trojos asteroidai, kurie dalijasi Jupiterio orbita, ar Apolono grupės asteroidai, kurie gali kirsti ir Žemės orbitą. Asteroidų tyrinėjimas yra svarbus dėl kelių priežasčių: juos tyrinėjant, galima geriau suprasti pradines medžiagas, iš kurių susiformavo Saulės sistema, o stebint potencialiai pavojingus asteroidus – geriau apskaičiuoti jų trajektorijas bei galimus smūgius į Žemę ir planuoti apsaugos priemones.
Kaip ieškoma asteroidų?
2022 m. Vilniaus universiteto Teorinės fizikos ir astronomijos instituto Molėtų astronomijos observatori -
joje buvo atrasti 22 nauji asteroidai, o 2023 m. – 25. Nuo 2001 m. Molėtų astronomijos observatorijoje atrastų mažųjų planetų – asteroidų skaičius viršija 700.
Asteroidų paieška yra kruopštus ir sudėtingas procesas, reikalaujantis ne tik techninių įgūdžių, bet ir kantrybės. „Giedromis naktimis Molėtų observatorijoje nukreipiame teleskopą į vieną iš dangaus plotų, nustatome 15 minučių išlaikymą ir darome dangaus sklypo nuotraukas. Dauguma asteroidų yra juodos, pilkos ar tamsiai raudonos spalvos, dėl to reikia surinkti itin daug šviesos, kad būtų galima juos pastebėti“, – apie asteroidų paiešką pasakoja dr. K. Černis.
Mokslininkas sako, kad vieną asteroidą jis stebi bent kelias naktis:

Molėtų astronomijos observatorijoje
atrastų mažųjų planetų – asteroidų skaičius viršija 700.

„Speciali kompiuterio programa siunčia signalus varikliams, kad šie suktų teleskopą priešinga kryptimi, nei sukasi Žemė, tad per penkiolika minučių pajuda ir asteroidas. Pirmosiose nuotraukose matomas pailgas asteroido vaizdinys, kitose nuotraukose asteroidas jau matomas kitoje vietoje. Taip, sudėję kelias nuotraukas, galime pastebėti judančius asteroidus. Vieną asteroidą stebime mažiausiai kelias naktis, kadangi reikia labai tiksliai išmatuoti jo padėtį erdvėje.“
Pasak astrofiziko, asteroido atradimas užtrunka ilgai: „Jei kyla įtarimas, kad galbūt atradome nežinomą asteroidą, siunčiame užklausą Mažųjų planetų centrui, esančiam Jungtinėse Amerikos Valstijose, Kembridže. Centras patikrina savo turimą informaciją apie orbitos elementus, bet šis procesas užtrunka, nes kartais nutinka taip, kad seniai atrastas asteroidas būna pametamas. Tad kai asteroidas atrandamas, jis ilgą laiką būna stebimas, atliekama orbitos analizė, dėl to kartais tik po kelerių metų sužinome, kad atrastasis asteroidas yra
priskirtas mūsų observatorijai ir kad jis nebuvo atrastas kieno nors kito. O jau tik po šio ilgo proceso mes dangaus kūnui galime suteikti vardą.“
Asteroidui vardą suteikti gali tik jį atradęs astronomas
Iš Saulės sistemoje atrastų daugiau nei trijų šimtų tūkstančių asteroidų šiuo metu vardai yra suteikti keliolikai tūkstančių, kiti turi tik numerius. Taip yra todėl, kad vardo suteikimo asteroidui procesas kai kuriais atvejais gali trukti dešimtmečius. Puikus to pavyzdys yra asteroidai „Poczobut“ ir „Dziewulski“, kurie buvo pavadinti Vilniaus universiteto rektorių ir astronomų Martyno Počobuto ir Vladislavo Dzievulskio garbei – šie asteroidai buvo atrasti 2004 ir 2006 m., o vardai jiems suteikti tik 2024-aisiais.
Dangaus kūnų vardus registruoja Tarptautinė astronomų sąjunga, kuri buria 74 valstybes nares. Ši organizacija vienintelė pasaulyje turi teisę dangaus kūnams suteikti oficialius pavadinimus. Tarptautinė astronomų
Iš Saulės sistemoje atrastų daugiau nei trijų šimtų tūkstančių asteroidų šiuo metu vardai yra suteikti keliolikai tūkstančių.

sąjunga pabrėžia, kad pavadinimai nėra parduodami, dangaus kūnui suteikti vardą gali tik jį atradęs astronomas.
Asteroidų pavadinimo procesą reglamentuoja tam tikros taisyklės, kurias nustato Tarptautinė astronomų sąjunga. Pavadinimo procedūra prasideda nuo asteroido atradimo ir laikino žymėjimo. Kiekvienam naujai atrastam asteroidui pirmiausia suteikiamas laikinas identifikacinis katalogo numeris, kuris susideda iš atradimo metų ir raidžių bei skaičių, nurodančių atradimo seką per tų metų laikotarpį. Pavyzdžiui, asteroido „Poczobut“ numeris yra 2004 TQ77. Kai asteroido orbita yra nustatyta pakankamai tiksliai, kad būtų galima patvirtinti jo egzistavimą, jam suteikiamas nuolatinis numeris. Šis numeris yra eilinis skaičius, priskiriamas pagal atradimo seką. Nuolatinis asteroido „Poczobut“ numeris yra 191775. Po to, kai asteroidas gauna nuolatinį numerį, jo atradėjas turi teisę pasiūlyti jam pavadinimą. Pavadinimo pasiū-
lymas siunčiamas Mažųjų planetų centrui, kuris yra atsakingas už asteroidų ir kometų duomenų rinkimą ir administravimą. Šis centras pateikia pasiūlymą Tarptautinės astronomų sąjungos Mažųjų kūnų pavadinimų komitetui, kuris nagrinėja pasiūlymus ir užtikrina, kad jie atitiktų nustatytas taisykles ir kriterijus. Asteroidų pavadinimams galioja kelios pagrindinės taisyklės. Pavadinimai negali būti užgaulūs, neturi būti pernelyg panašūs į jau esamus asteroidų ar kitų astronominių objektų pavadinimus, kad būtų išvengta painiavos. Tarptautinė astronomų sąjunga taip pat vengia pavadinimų, kurie atspindėtų politines, karines ar religinės reikšmės figūras, ypač jei šie asmenys tuo metu dar yra gyvi. Be to, asteroidų pavadinimai negali būti reklaminio pobūdžio, t. y. jie negali reklamuoti komercinių produktų ar paslaugų. Dažnai asteroidams suteikiami žymių mokslininkų, kultūros veikėjų, mitologinių būtybių vardai arba reikšmingų vietų pavadinimai.
Dangaus kūnui suteikti vardą gali tik jį atradęs astronomas.
Tarptautinė astronomų sąjunga vengia pavadinimų, kurie atspindėtų politines, karines ar religinės reikšmės figūras, ypač jei šie asmenys dar yra gyvi.
Lietuviški pavadinimai kosmose
Pirmasis lietuviškas kosminio objekto pavadinimas susijęs su dar 1980 m. astronomų dr. K. Černio ir Jovaro Petrausko pirmą kartą pasaulyje pastebėta kometa. Ji ir buvo pavadinta šių dviejų atradėjų vardu –Černio–Petrausko kometa. Pirmasis asteroidas Vilniaus universiteto Molėtų astronomijos observatorijoje buvo atrastas 2001 m. „Jis buvo pavadintas šio miesto garbei – jam suteiktas vardas „Molėtai“, – prisimena dr. K. Černis.
„Dažniausiai asteroidams duodame vardus norėdami atminti žinomus astronomus, poetus ar dailininkus. Renkamės reikšmingus Lietuvai pavadinimus“, – sako tyrėjas.
Šiuo metu kosmose yra daugiau lietuviškų pavadinimų nei lenkiškų. Dr. K. Černis lietuviškus vardus jau yra suteikęs apie 200 asteroidų. Tarp jų – ir Lietuvos valdovų vardai: „Mindaugas“, „Gediminas“, „Kęstutis“, „Algirdas“, „Jogaila“, „Vytautas“. Astronomas mažąsias planetas yra pavadinęs ne tik Molėtų, bet ir kitų Lietuvos miestų vardais: „Rietavas“, „Birštonas“, „Ukmergė“, „Klaipėda“, „Šiauliai“ ir kt.
Dr. K. Černis asteroidų pavadinimais yra pagerbęs ir daug istorinių Lietuvos asmenybių. Tarp jų – ne tik Vilniaus universiteto rektoriai, bet ir rašytoja Žemaitė, vyskupas Motiejus Valančius, „Tautiškos giesmės“ autorius Vincas Kudirka, pirmosios lietuviškos
knygos autorius Martynas Mažvydas, poetas Maironis ir daugelis kitų.
„Ypač įdomus 2012 m. kartu su Vatikano observatorijos astronomais atrastas asteroidas „Praamžius“, kuris priklauso transneptūniniams objektams ir išsiskiria savo dydžiu. Jo skersmuo – 350 kilometrų, – apie išskirtinį asteroidą, kuriam suteiktas baltų dievo vardas, pasakoja astrofizikas. – Tokie asteroidai juda už Neptūno planetos orbitos. Kitas panašus asteroidas – apie 300 kilometrų skersmens – atrastas 2021 m. ir dar laukia eilėje gauti lietuvišką pavadinimą, kadangi reikia patikslinti jo orbitos parametrus.“

Vilniaus universiteto
Verslo mokykla
Visuomenės susidomėjimas tvarumu, didėjantis sąmoningumas ir nauji Europos Sąjungos (ES) teisės aktai skatina įmones ieškoti tvaresnių verslo sprendimų, kurti tvarius produktus, tenkinančius naujosios kartos „žaliųjų“ vartotojų poreikius.
Augant tvarių produktų paklausai, verslo komunikacijoje vis dažniau naudojamos priemonės, kuriomis siekiama pabrėžti produkto ar įmonių veiklos draugiškumą aplinkai. Verslas supranta, kad tokio pobūdžio komunikacija gali padėti pritraukti daugiau vartotojų, besidominčių tvarumu, padidinti pardavimą, pelną, padėti įgyti konkurencinį pranašumą tarptautinėse rinkose. Tačiau pastaruoju metu daugėja verslų, kurie imituoja tvarumą, nors nei jų veikla, nei kuriami produktai nėra tvarūs. Europos aplinkos apsaugos biuro duomenimis, šiuo metu 75 proc. ES rinkoje esančių produktų pristatomi pasitelkiant tiesioginius arba netiesioginius teiginius apie ekologiją, tačiau daugiau nei pusė jų yra neaiškūs, klaidinantys arba nepagrįsti.


Labiausiai klaidinantys teiginiai –apie klimato neutralumą
Didėjanti painiava dėl įmonių teiginių apie poveikį aplinkai patikimumo silpnina vartotojų pasitikėjimą, jiems darosi vis sunkiau priimti sprendimą dėl prekės ar paslaugos įsigijimo. Vieni labiausiai klaidinančių teiginių yra apie klimato neutralumą.
Europos Komisijos duomenimis, beveik pusė iš 230 ES taikomų ekologinių ženklų turi labai silpnas tikrinimo procedūras arba jų visai neturi. Dėl to 2023 m. Europos Komisija pateikė pasiūlymą dėl Žaliųjų teiginių direktyvos, kuria siekiama užkirsti kelią bendrovėms skleisti neaiškius ar nepagrįstus teiginius apie aplinkosaugą ir naudoti nepatikimas etiketes. Šia direktyva bandoma apriboti įvairias nesąžiningas bendrovių taktikas ir suteikti vartotojams galimybę rinktis tvarius produktus. Nauji reikalavimai bus taikomi daugiau nei 10 darbuotojų turinčioms įmonėms, kurių produktai skirti ES vartotojams ir kurių metinė apyvarta viršija 2 mln. eurų.
Tvarumą imituojančius teiginius pirmasis sukritikavo Jay Westerveldas 1986 m., kai viešbučiai pradėjo prašyti savo svečių rankšluosčius naudoti pakartotinai, taip neva tausojant
aplinką ir taupant vandenį. Jis teigė, kad tokio pobūdžio teiginiai neturi nieko bendra su tvarumu, o tėra būdas verslui siekti didesnio pelno.
Tvarumas dažniau imituojamas, nei įgyvendinamas
Reaguodamos į vartotojų elgsenos pokyčius ir augančius aplinkosaugos iššūkius, įmonės stengiasi susikurti gerą įvaizdį ir žada daugiau naudos aplinkai, nei iš tikrųjų gali pasiūlyti aplinką tausojantiems vartotojams. Tvarumo imitavimas yra procesas, kai įmonės išleidžia daugiau pinigų ir skiria laiko siekdamos reklamuoti save kaip ekologiškas, o ne realiai sumažinti poveikį aplinkai. Tai reiškia, kad įmonės yra labiau linkusios investuoti į savęs kaip „žaliosios įmonės“ pristatymą nei šiuos išteklius paskirti aplinkosaugai.
Kodėl įmonės taip elgiasi? Tyrėjai išskiria keletą priežasčių. Pirmoji – kai įmonės (dažniausiai didelės korporacijos) bando nuslėpti savo menkus ar neegzistuojančius aplinkosaugos „pasiekimus“ didingais žaliaisiais gestais, o antroji – kai įmonės, norėdamos patraukti vartotojų dėmesį, pasitelkia tam tikrus žodžius: „žalias“, „tvarus“, „ekologiškas“ arba „veganiš-
kas“, „vegetariškas“, per daug nesigilindamos į šių žodžių reikšmę. Visi šie veiksmai rodo įmonių abejingumą, nenorą gilintis į realias aplinkosaugos problemas, nenorą keisti savo veiklos procesų ir iš tikrųjų prisidėti prie aplinkosaugos problemų sprendimo.
Mažinamas pasitikėjimas tikromis iniciatyvomis
Tvarumo imitavimas yra ir tam tikras komunikacijos būdas, kurio tikslas –suklaidinti vartotojus, suteikiant jiems netikslią, neteisingą, apgaulingą, nepagrįstą informaciją apie įmonės veiklą, paslaugas ar produktus. Vadinasi, tai yra sąmoningas įmonių veiksmas, o ne netyčinė klaida – pateikdamos tam tikrą informaciją, šios įmonės suteikia vartotojams iliuziją, kad jų veikla, produktas ar paslauga yra tvari. Suklaidinti vartotojai gali priimti sprendimus, kurie neatitinka jų vertybių, kenkia pasitikėjimui tikromis aplinkosaugos iniciatyvomis. Tai gali trukdyti ir pažangai sprendžiant klimato kaitos ir biologinės įvairovės nykimo problemas. Han Chen, Shaniel Bernard, Imrano Rahmano teigimu (2019), jeigu tvarumo teiginiai per daug prisotins rinką, jie tiesiog nebeturės jokios įtakos pasirinkimui ir
Daugėja verslų, kurie imituoja
tvarumą, nors nei jų veikla, nei kuriami produktai nėra tvarūs.
visuomenė darysis abejinga tvarumo klausimams.
Be to, dėl didelės konkurencijos tvarumą imituojantys teiginiai gali turėti neigiamą įtaką bendrai verslo etikai ir skatins lenktynes ne dėl aplinkos išsaugojimo, o dėl produktų pardavimo didinimo. Pavojinga ir tai, kad įmonės gali vis labiau slėpti tikrąją žalą, kurią daro aplinkai, ir neprisiimti už tai atsakomybės. Tokio pobūdžio veikla gali pakenkti visuomenės pasitikėjimui įmonių aplinkosauginiu veiksmingumu ar net kelti skeptišką požiūrį į tvarumą apskritai.
Mokslinės literatūros ir atliktų tyrimų apžvalga leidžia teigti, kad tvarumą imituojantys teiginiai daro vartotojams neigiamą poveikį. Vartotojas sutrinka, nes įmonės dažnai pasitelkia neaiškius, abstrakčius teiginius arba priešingai – labai išsamius su sudėtingais terminais, todėl jis nesupranta, ar prekė yra tvari ir ar jis nori ją įsigyti. Jis taip pat susiduria su didesne įsisąmoninta rizika, o didelė rizika stabdo norą įsigyti prekę. Vartotojas pradeda jausti nepasitikėjimą įmone, preke ar paslauga, ir šis nepasitikėjimas ilgainiui gali peraugti į skepticizmą ir nenorą prisidėti prie tvaraus vartojimo apskritai. Tvarumą imituojantys teiginiai lemia vartotojų lojalumo sumažėjimą dėl atsirandančios priešpriešos tarp vartotojo ir įmonės, o kartu
ir sumažėjusį vartotojo polinkį pirkti prekes ar paslaugas (1 pav.).
Kokie teiginiai klaidina?
Vartotojai imituojamą tvarumą gali suvokti keliais būdais – nuo produkto lygmens teiginių, pavyzdžiui, jų aplinkosauginio ženklinimo, iki organizacijos lygmens teiginių tvarumo ataskaitose. Organizacijos lygmens teiginiai padeda verslui sukurti tvarios įmonės įvaizdį, kad būtų sulaukta vartotojų palankumo neinvestuojant į realių aplinkosaugos problemų sprendimą ar savo veiklos poveikio aplinkai mažinimą. Kitaip tariant, tai apgaulinga rinkodaros strategija, kurią organizacijos taiko siekdamos pavaizduoti save kaip aplinką tausojančias ir socialiai atsakingas įmones, nors iš tikrųjų jų veikla neatitinka šių teiginių. Pavyzdžiui, didžiulės naftos korporacijos reklamuojasi kaip prisidedančios prie atsinaujinančių energijos šaltinių plėtros, tuo tarpu iš tikrųjų aktyviai investuoja į naujų naftos gręžinių paieškas, naikindamos natūralias gyvūnų buveines.
Produkto lygmens teiginiai yra orientuoti į prekės ar paslaugos tvarumo išryškinimą, nuslepiant žalingas savybes, perdedant ar net meluojant apie prekės ekologiškumą. Pavyzdžiui, buteliukas „PlantBottle“ pristatomas
kaip alternatyva įprastiems plastikiniams buteliams, tačiau bioplastikas nėra tvari medžiaga apskritai.
Praktikoje dažniausiai aptinkami produkto lygmens teiginiai, kurie gali būti labai įvairūs: neaiškūs, dviprasmiški arba pernelyg migloti, platūs ir neturintys aiškios apibrėžties. Gali būti praleista tam tikra informacija, kuri yra būtina šių teiginių pagrįstumui įvertinti. Aptinkami ir atvirai melagingi teiginiai, kurie neatitinka tikrovės arba net yra išgalvoti. Pavyzdžiui, teiginiai „ekologiškos cigaretės“, „ekologiškas dyzelinas“, „taupiai degalus naudojantis sportinis automobilis“ neatitinka tikrovės dėl pačios gaminio kategorijos.
Tvarumą imituojančius teiginius galima suskirstyti į kelias kategorijas.
Į produktą orientuoti teiginiai perdėtai akcentuoja ekologiškas produkto savybes. Teiginiai, orientuoti į procesą, daugiausia dėmesio skiria ekologiško gamybos proceso technologijoms arba įvairiems atliekų mažinimo metodams. Į įvaizdį orientuotais teiginiais pabrėžiamas tvarios organizacijos įvaizdis, socialiai atsakingos veiklos, socialinės iniciatyvos, kurios sulaukia didelio visuomenės palaikymo. Tačiau kartais įmonės skelbiami tvarumo „pasiekimai“ iš tiesų nėra jos pasiekimai, o jau egzistuojantys reikalavimai, įtvirtinti galiojančiuose įstatymuose. Pavyzdžiui, freonų naudojimas gamyboje dėl reikšmingo poveikio klimato kaitai yra uždraustas įstatymo. Todėl užrašas ar ženklinimas „Gaminys be freonų“ (angl. CFC-free) yra teisingas, tačiau tai nėra įmonės nuopelnas.
Į aplinkosaugą orientuoti teiginiai apima informacijos, susijusios su poveikio aplinkai mažinimu ir aplinkos būklės gerinimu, viešinimą. Gali pasitaikyti ir teiginių deriniai, sudaryti iš dviejų ar daugiau minėtų kategorijų. Įvairūs šių teiginių deriniai labiausiai paplitę reklamose, todėl vartotojai turėtų būti itin atidūs, jei priima sprendimą pirkti remdamiesi reklamose pateikta informacija. Laikui bėgant įmonės darosi vis originalesnės ir pasitelkia įvairius būdus norėdamos įtikinti vartotoją, kad jos ar jų produktai yra draugiški gamtai, ir taip siekdamos pelnyti jų palankumą.
Vaizdu taip pat galima suklaidinti Analizuojant organizacijos lygmens teiginius atkreiptinas dėmesys į pateikiamas tvarumo ataskaitas.


Stiprėjantis teisinis reglamentavimas įpareigoja įmones atsiskaityti suinteresuotoms grupėms apie tvarias veiklas, tačiau dažniausiai ataskaitose dominuoja pozityvi informacija be tvarumą patvirtinančių duomenų ar įrodymų, vartojamos deklaratyvios frazės: tobulinsime, gerinsime, stiprinsime, sieksime nulinių CO2 emisijų ir pan. Pažymėtina, kad stiprėja ir verslo įtaka politinių sprendimų priėmėjams, siekiant gauti naudos ir netvarius veiksmus pateisinant sumokamų mokesčių dydžiu ar sukurtų darbo vietų skaičiumi. Dėmesys nukreipiamas nuo tvarumo problemų ir pasitelkiant reklamą, kuri aukština organizacijos pasiekimus, nieko bendra neturinčius su tvarumu.
Neetiškiems įmonių veiksmams pateisinti naudojami ne tik teiginiai, bet ir vaizdai, pavyzdžiui, tokie, kuriuose vyrauja žalia ar mėlyna spalva, girdėti jūros ošimas ar paukščių garsai, matyti įspūdingi kraštovaizdžiai (kalnai, miškai, vandenynai) arba nykstančių rūšių gyvūnai (pandos, delfinai), atsinaujinantys energijos šaltiniai (vėjas, kriokliai). Šie gražūs gamtos vaizdai vartotojams asoci -
juojasi su harmonija, tvarumu ir gali lemti klaidingą suvokimą apie prekės ženklo ar produkto tvarumą. Be to, gaminio etiketėje naudojant tam tikrą grafiką gali būti sukuriama iliuzija, kad jį patvirtino trečioji šalis arba kad jis buvo tinkamai sertifikuotas, nors iš tikrųjų taip nėra.
Dėl to, kad įmonių tvarumo imitavimas toks daugialypis, vartotojams sunku atpažinti jo apraiškas. Tačiau reikėtų ypač atkreipti dėmesį į tokius teiginius kaip „100 % ekologiškas“, „100 % natūralus“, „100 % perdirbtas“, „100 % veganiškas“. Be konkrečių įrodymų šie teiginiai dažniausiai neatitinka tikrovės ir yra tik tvarumo imitavimas. Norint įsitikinti, kad gaminys tikrai tvarus, būtina ieškoti tai patvirtinančių faktų, o ne vien žavėtis patraukliais vaizdais gaminio etiketėje ar skambiais žodžiais reklamose. Reikia tikėtis, kad įsigaliojantis ES reglamentas dėl tvarumą imituojančių teiginių veiks kaip įspėjamoji priemonė įmonėms dėl numatomų sankcijų, o vartotojai bus labiau apsaugoti nuo apgaulingos komunikacijos ir drąsiau rinksis tvarius produktus.
Norint įsitikinti, kad gaminys tikrai tvarus, būtina ieškoti tai patvirtinančių faktų.
Julija Šakytė-Sarapė
Vilniaus universitetas
Vilniaus universiteto Medicinos fakulteto tyrėjų komanda – medicinos genetikė prof. Laima Ambrozaitytė, Medicininės genetikos centro vadovas prof. Algirdas Utkus ir gydytojas psichiatras dokt. Robertas Strumila – šiuo metu atlieka tyrimą, kurio tikslas – atrasti kraujyje specifinius biožymenis, ateityje padėsiančius identifikuoti žmones, linkusius į savižudybę, kad būtų
galima jiems laiku suteikti reikiamą pagalbą. Tyrėjai pasakoja, kaip atrasti biožymenys gali prisidėti prie savižudybių prevencijos ir pagerinti psichikos sveikatos priežiūrą.


Ieškoma specifinių biožymenų
Atrasti biožymenys
gali prisidėti prie savižudybių prevencijos ir pagerinti psichikos sveikatos priežiūrą.
Nors savižudybių Lietuvoje per 13 metų sumažėjo beveik dvigubai (Higienos instituto duomenimis, 2010 m. užfiksuota 1018 savižudybių, 2023 m. –562), bet šis rodiklis lieka vienas prasčiausių Europoje. Vilniaus universiteto Medicinos fakulteto tyrėjų komanda iš Santaros klinikų, Vilniaus psichiatrijos centro ir Respublikinės Vilniaus universitetinės ligoninės ieško sprendimų, kurie galėtų būti taikomi kaip „ankstyvojo perspėjimo“ sistema, leidžianti imtis prevencinių priemonių dar iki pirmojo bandymo nusižudyti.
Su prof. L. Ambrozaityte susitinku Vilniaus universiteto Biomedicinos mokslų instituto Žmogaus ir medicininės genetikos katedroje, kur vyksta dalis tyrimo darbų. Prie pokalbio gydytojas psichiatras R. Strumila prisijungia nuotoliniu būdu – šiuo metu tyrėjas dirba Prancūzijoje.
Jie nuo 2020 m. kartu su kolegomis atlieka mokslinius tyrimus, skirtus specifiniams biožymenims, galbūt lemiantiems bandymo nusižudyti riziką, nustatyti. Taip pat siekiama nustatyti, kurie kraujo biožymenys ar jų kombinacija yra labiausiai susiję su vienkartiniu savižudybės bandymu ir ar kurie nors kraujo biožymenys yra
susiję su daugkartiniais bandymais nusižudyti.
„Tai labai kompleksiškas neurobiopsichologinis modelis. Jį kurdami daugiausia remiamės klinikiniais sociologiniais duomenimis. Tai reiškia, kad analizuojame asmens ligos istoriją, ligos simptomus. Biologinė informacija (kraujo mėginių tyrimas) naudojama kaip papildoma tyrimo medžiaga, siekiant įvertinti savižudiško elgesio riziką“, – patikslina R. Strumila.
Tirtos trys grupės žmonių
Medicinos fakulteto komanda tyrė tris grupes žmonių: bandžiusių nusižudyti, sergančių depresija, bet nebandžiusių nusižudyti ir psichikos ligomis nesergančių ir nebandžiusių nusižudyti (kontrolinė grupė). Iš viso tyrime dalyvavo 150 18–65 metų amžiaus žmonių. Tai – asmenys, gydęsi Vilniaus miesto Psichikos sveikatos centre, Santaros klinikų Šeimos medicinos centre arba Psichiatrijos skyriuje ir besigydantys po bandymo nusižudyti Respublikinėje Vilniaus universitetinėje ligoninėje. Jie buvo pakviesti ir sutiko dalyvauti tyrime.
„Nors tyrimas dar nėra galutinai baigtas, bet jau matome, kad trijų pasirinktų grupių tyrimo rezultatai yra
skirtingi. Tikėjomės ir radome biologinių skirtumų tarp kontrolinės grupės asmenų – žmonių, neturinčių diagnozuotų psichikos sutrikimų ir nebandžiusių nusižudyti – ir tarp žmonių, kurie kreipėsi į gydytojus dėl depresijos. Taip pat radome skirtumų tarp kitų dviejų grupių – žmonių, sergančių depresija, bet nebandžiusių nusižudyti, ir žmonių, kurie bandė nusižudyti, bet neturėjo diagnozuotos patologijos.
Tai parodo, kad nors depresija ir savižudybė yra susijusios, bet biologiniu požiūriu tai nėra tie patys procesai“, –aiškina psichiatras R. Strumila.
Jo teigimu, nors depresija sergantys asmenys pasižymi padidėjusia savižudybės rizika, tačiau nustatyta, kad apie 90 proc. žmonių, sergančių depresija ir turinčių suicidinių minčių, nebandys nusižudyti, o asmenys,
Nors depresija sergantys asmenys pasižymi padidėjusia savižudybės rizika, tačiau nustatyta, kad apie 90 proc.
žmonių,
sergančių depresija ir turinčių suicidinių minčių, nebandys nusižudyti.
išgyvenę suicidinį bandymą, nebūtinai sirgo depresija.
„Šio tyrimo metu ieškoma ir tokių biožymenų, kurie yra susiję su savižudišku elgesiu nepriklausomai nuo depresijos diagnozės. Tai yra ganėtinai subtilūs dalykai, todėl ir gydymas turėtų būti labiau personalizuotas, galvojant, kaip individualiai kiekvienam žmogui padėti pagal tai, kokius ligos simptomus jis patiria“, – aiškina doktorantas.
Rezultatai bus lyginami su Pietų Korėjos populiacijos tyrimo rezultatais
Pasak prof. L. Ambrozaitytės, šiuo metu vykdomi tyrimai ir jų analizė yra susiję su farmakogenetiniais, kitaip sakant, vaistų toleravimo, žymenimis. Tai yra tie genomo žymenys, kurie
leidžia atsakyti į klausimą, kaip asmuo metabolizuoja vieną ar kitą vaistą ar cheminę medžiagą.
„Mes tikimės ne tik palyginti tiriamųjų grupes, bet ir išsiaiškinti, kaip šį atradimą būtų galima pritaikyti personalizuotai medicinai, kad konkrečiam pacientui galėtume sudaryti gydymo planą ir pagal tai, kaip bus metabolizuojami vaistai, koreguoti šį planą ar jo sudarymą, – pasakoja genetikė. – Pradėjome nuo konkrečių vietų žmogaus genome, kurios jau ankstesniuose tyrimuose buvo susietos su vaistų toleravimo atsaku, todėl tai norime patikrinti ir dabar vykdomo tyrimo metu.“
Be to, šiuo metu vyksta ir dar vienas tyrimo etapas – lyginamoji Lietuvos ir Pietų Korėjos kraujo mėginių rezul-

tatų analizė. Nors etniškai ir genetiškai skirtinga, Pietų Korėjos populiacija taip pat pasižymi aukšta savižudybių statistika. Prof. L. Ambrozaitytės teigimu, pagrindinis šio etapo tikslas – nustatyti metilinimo profilį lietuvių tiriamųjų grupėje ir palyginti jį su pietų korėjiečių, ieškant skirtumų.
Metilinimas yra organizmo epigenetinis procesas, veikiantis genų raišką ir reguliuojantis daugybę biocheminių procesų. Jis vaidina labai svarbų vaidmenį nervų sistemos veikloje, todėl asmenys, turintys metilinimo sutrikimų, gali dažniau patirti psichikos sveikatos problemų.
„Analizė šiuo metu vis dar atliekama, bet tikimės, kad rezultatai bus įdomūs – atskleis skirtumus ir specifinį metilinimo profilį. Kita vertus, neigiamas mokslinių tyrimų rezultatas, t. y. netgi kokių nors didelių skirtumų nenustatymas, irgi yra reikšmingas, lyginant skirtingas populiacijas“, – sako profesorė.
Atrastas naujas svarbus biožymuo
Anksčiau publikuotame moksliniame straipsnyje tyrėjų komanda paskelbė
savo naują atradimą – smarkiai padidėjęs etanolio metabolizmo produktas fosfatidiletanolis (PEth) tiriamųjų kraujyje parodė trijų mėnesių lėtinį alkoholio vartojimą neseniai bandžiusiųjų nusižudyti asmenų grupėje, bet ne depresija sergančių asmenų ar kontrolinėje grupėse. Išvadoje teigiama, kad būtent PEth gali būti vienas iš tų biožymenų, kurie padės pritaikyti personalizuotą gydymą asmenims, esantiems savižudybės rizikos grupėje.
„Tai parodė, kad lėtinis alkoholio vartojimas pastaruosius tris mėnesius apie keturis kartus padidina savižudybių bandymų riziką jau bandžiusių nusižudyti asmenų grupėje, palyginti su žmonėmis, kurie kreipėsi dėl depresijos. Kaip tai galėtų būti panaudota medicininėje praktikoje? Žmonėms, kurie kreipiasi į gydytojus, galėtų būti atliktas PEth koncentracijos tyrimas. Pacientams būtų pasakoma, kad šio elemento koncentracija jų organizme yra smarkiai per didelė ir, jeigu jie toliau vartos alkoholį dideliais kiekiais, kaip buvo pastaruosius kelis mėnesius, susidurs su labai didele rizika patekti į priėmimo skyrių arba pasielgti neprognozuojamai. Tai gali suveikti kaip motyvacinė ir prevencinė priemonė“, – aiškina doktorantas.
Lėtinis alkoholio vartojimas pastaruosius tris mėnesius apie keturis kartus padidina savižudybių bandymų riziką jau bandžiusių nusižudyti asmenų grupėje, palyginti su žmonėmis, kurie kreipėsi dėl depresijos.



Genomo tyrimų lustas su milijonais pozicijų žmogaus genome, kurios ištiriamos kiekvienam tiriamajam.
Laimos Ambrozaitytės nuotr.
Bandžiusieji nusižudyti asmenys buvo linkę pateikti neteisingą informaciją apie alkoholio vartojimą, priešingai nei asmenys, kuriems buvo diagnozuota depresija.
Tyrimą papildė įdomūs rezultatai Atlikus PEth koncentracijos tyrimą buvo gautas dar vienas įdomus rezultatas – bandžiusieji nusižudyti asmenys buvo linkę pateikti neteisingą informaciją apie alkoholio vartojimą, priešingai nei asmenys, kuriems buvo diagnozuota depresija.
„Depresija sergančių asmenų grupėje daugelis pateikė tikslius atsakymus. Jie nurodė, kad pastarąjį laiką vartojo alkoholį – tai patvirtino ir mūsų objektyvus tyrimas. Tačiau bandžiusiųjų nusižudyti grupėje buvo labai ryškus neatitikimas. Žmonių, kurie teigė, kad nevartoja alkoholio arba vartoja labai mažai, tyrimai parodė, kad pastarųjų mėnesių PEth koncentracija – gana didelė, o tai reiškia lėtinį alkoholio vartojimą“, – teigia gydytojas psichiatras.
Naujausiame tyrime, kuriam vadovavo R. Strumila, nustatyta, kad, nepriklausomai nuo depresijos sunkumo, ja
sergantys asmenys turi mažiau suicidinių minčių, jei jų kraujyje yra didesnis adrenokortikotropinio hormono (AKTH) kiekis, palyginti su kontrolinės grupės ir nusižudyti bandžiusių asmenų tyrimo rezultatais. AKTH gaminamas smegenyse, priekinėje dalyje. Jo funkcija organizme – paveikti antinksčius, kurie yra labai svarbūs normaliam, sveikam žmogaus gyvenimui. Tiek šio hormono trūkumas, tiek jo perteklius gali sukelti rimtus organizmo sutrikimus arba būti tam tikrų ligų padarinys. Doktoranto teigimu, visi šie atlikti ir toliau vykdomi tyrimai gali turėti tiesioginį praktinį pritaikymą ir teigiamą poveikį savižudybių statistikai: „Lietuvoje savižudybių skaičius mažėja tiek vykdant informacines kampanijas, tiek gerinant specialistų darbą su žmonėmis, kurie jau yra rizikos grupėje. Matome labai reikšmingą sumažėjimą. Tikėtina, kad tai vyks ir toliau. Mūsų tikslas – prie to prisidėti.“
Sonata Sliekaitė
Vilniaus universitetas
Matematinis samprotavimas dažniausiai pradedamas ugdyti tik vyresnėse klasėse, tačiau nauji tyrimai rodo, kad jau ketverių metų vaikai gali spręsti matematikos uždavinius, jei jiems pateikiamos jų amžiui pritaikytos užduotys. Vilniaus universiteto Matematikos ir informatikos fakulteto doktorantė Ieva Kilienė tyrinėja, kaip tekstiniai matematikos uždaviniai gali būti pritaikyti vaikams, kurie dar nemoka skaityti. Savo tyrime mokslininkė analizuoja, ar mažamečiai vaikai geba spręsti uždavinius ir ugdytis matematinį samprotavimą naudodamiesi paveikslėliais ir žodine informacija.

Pirmi tiriamieji – keturmečiai
I. Kilienės tyrimas yra vienas iš nedaugelio Lietuvoje, kurie orientuoti į matematinio samprotavimo ugdymą nuo ankstyvojo amžiaus. „Matematikos mokymo tyrimų Lietuvoje daryta dar labai nedaug, todėl atrodo logiška pradėti nuo pačių mažiausių mūsų piliečių“, – sako Ieva. Ji pabrėžia, kad imti mokyti tik kalbėti pradėjusius vaikus yra labai svarbu, nes ankstyvame amžiuje vaikams dar nebūna įdiegta neteisingų mokymosi metodų, kurie gali turėti ilgalaikių neigiamų padarinių vėlesniame mokymosi etape. Pasak mokslininkės, laikui bėgant matematika sudėtingėja, tampa abstraktesnė ir mažiau intuityvi, atsiranda neteisingų žinių, kurios
Matematiniu nerimu gali užkrėsti tėvai ir mokytojai, jei turi neigiamų nuostatų, susijusių su matematika.
„neveikia“, ir mokinys pradeda nebesuprasti ir nebemėgti matematikos. Todėl svarbiausia ir yra klausti „kodėl“, o ne „kiek“. „Taip pat svarbus veiksnys nemėgti matematikos yra matematinis nerimas, kurį jaučia apie 20 proc. populiacijos. Žmogaus smegenys reaguoja neigiamai vien jam pamačius matematinius simbolius. Matematiniu nerimu gali užkrėsti tėvai ir mokytojai, jei turi neigiamų nuostatų, susijusių su matematika“, – aiškina I. Kilienė. Matematinis samprotavimas yra vienas svarbiausių matematikos mokymosi įgūdžių, kuris daro didelę įtaką tam, kaip matematika vaikams seksis vyresniame amžiuje. Tyrimo tikslas buvo išbandyti, ar galima pradėti kalbėti apie matematikos uždavinius su vaikais, kurie dar nėra mokiniai, net
nemoka skaityti, ir pasižiūrėti, kaip jie geba spręsti šiuos uždavinius naudodamiesi vaizdine ir žodine informacija.
Kodėl svarbu tikslūs paveikslėliai
Metų trukmės tyrimas, atliktas 2022-aisiais, buvo grindžiamas atvejo analizės (angl. case study) metodu. Uždavinys vaikams buvo pritaikytas pakeičiant skaičius paprastesniais, jiems artimais objektais ir įvedant veikėją – meškutį, kuris sprendžia, prie kurio stalo geriau atsisėsti, kad gautų daugiau keksiukų. „Mums buvo svarbu, kad uždavinys būtų patrauklus vaikui. Nei Lietuvoje, nei užsienio literatūroje nemačiau gražiai ir žaismingai iliustruotų matematikos uždavinių“, – sako I. Kilienė.

Uždaviniai buvo pritaikyti vaikams pakeičiant skaičius paprastesniais, jiems artimais objektais.
Jos nuomone, tai itin svarbu, kadangi vaikai yra ypač dėmesingi detalėms. Jaunoji tyrėja jau yra sukūrusi seriją įvairių kortelių, kurių tikslas – ugdyti matematinį samprotavimą vaikams nuo ketverių metų iki... tėvelių amžiaus. Tyrimas buvo atliekamas interviu būdu, kalbantis individualiai su kiekvienu vaiku, o vėliau analizuojant garso įrašą. Jis parodė, kad ketverių metų vaikai gali spręsti matematikos uždavinius naudodamiesi paveikslėliais ir žodine informacija, nors jie dažnai vartoja paprastus žodžius, kad išreikštų matematines sąvokas. Tyrimo metu ant stalo buvo padėtas paveiksliukas (1 pav.), o tyrėja I. Kilienė vedė pokalbį su vaiku. Pradėdamas spręsti uždavinį vaikas pasakė, kad prie pirmo stalo meškutis gautų vieną keksiuką. Tyrėjai paklausus, kiek meškučių sėdės prie šio stalo, jis atsakė, kad keturi, ir paaiškino, jog keksiukas turėtų būti perpjautas į dvi dalis, kad kiekvienas meškutis gautų po vieną dalį. Vaikas parodė pirštu į kėdes, kur sėdės meškučiai, ir paaiškino, kaip kiekvienas gaus savo dalį.
Toliau spręsdamas uždavinį, vaikas pasakė, kad kiekvienas meškutis gaus po keturias dalis. Kalbėdamas apie vidurinį stalą, jis nurodė, kad kiekvienas meškutis gaus po du keksiukus, nes prie šio stalo yra dvi kėdės ir trys
keksiukai. Vaikas suprato, kad abu meškučiai gaus po vieną keksiuką ir dar vieną dalį. Kai tyrėja paklausė apie trečią stalą, vaikas atsakė, kad ten kiekvienas meškutis gaus po vieną keksiuką. Galiausiai vaikas nusprendė, kad geriausia sėdėti prie vidurinio stalo, nes ten kiekvienas meškutis gaus po du keksiukus.
Atvejo analizė rodo, kad net neskaitantis vaikas geba teisingai pagrįsti uždavinio sprendimą, tik nežino tam reikalingų sąvokų. Jis negali suformuluoti minties, kad susidaro nepilni du vienetai, bet teigia, kad objektai (nors ir nepilni) yra du, be mokytojo pagalbos pats vartoja terminą „dalis“.
Pavyzdys liudija, kad tekstinį uždavinį skirtingu formatu galima pateikti skirtingo amžiaus vaikams ir iš jų tikėtis skirtingų, bet jų amžiui priimtinų ir teisingų sprendimo formų.
Vilniaus universiteto doktorantės su iliustratore kuriamos matematikos uždavinių kortelės yra labai svarbi matematinio samprotavimo ugdymo dalis. „Moksliniai tyrimai rodo, kad mokiniams yra naudingos tos iliustracijos, kurios tikrai atspindi realią situaciją“, – aiškina I. Kilienė. Ji pabrėžia, kad iliustracijos turi būti itin tikslios, nes netikslūs paveikslėliai gali trukdyti spręsti uždavinius ne tik patiems mažiausiems vaikams, bet ir pradinių

1 pav. Uždavinio kortelė, naudota tyrimo metu su keturmečiais (iliustracijos autorė – Eidvilė Varnaitė)
Matematinio samprotavimo ugdymas

klasių mokiniams. Keturmečiai labiau kreipia dėmesį į detales iliustracijose nei vyresni vaikai, o tai gali turėti įtakos jų gebėjimui spręsti matematikos uždavinius.
Patarimas – netrukdyti vaikams mąstyti
I. Kilienė rekomenduoja pedagogams ir tėvams skatinti vaikus mąstyti klausiant jų „kodėl?“ ir leidžiant jiems patiems sugalvoti sprendimus. „Dar mokyklos nelankančius vaikus svarbu ugdyti, o gal tiksliau būtų pasakyti –netrukdyti jiems mąstyti, nesiūlyti savo sprendimo būdų, bet leisti jiems patiems sugalvoti ir paaiškinti, net jei tai bus neteisinga“, – pataria tyrėja. Ji pabrėžia, kad svarbu ne tik skaičiuoti objektus, bet ir mokytis mąstymo meno sprendžiant matematikos uždavinius.
Iliustruoti uždaviniai gali būti puiki priemonė ikimokyklinio amžiaus vaikams, ir I. Kilienė mano, kad jie
turėtų būti integruoti ne tik į ikimokyklinio ugdymo programas, bet ir į priešmokyklines grupes: „Matematikos neturėtume padaryti nuobodžios, nes vien to paties veiksmo kartojimas ją tokią ir padaro. Todėl pirmiausia labai svarbu ir mokytojams matematiką suprasti kaip mąstymo meną ir kuo įdomiau ją pateikti vaikams.“
Doktorantė planuoja tęsti tyrimus. Šiuo metu ji analizuoja 1–4 klasių vadovėliuose esančius tekstinius matematikos uždavinius ir svarsto apie ilgalaikius tyrimus, kurie leistų stebėti vaikų požiūrio į uždavinius ir vartojamų sąvokų kaitą laikui bėgant. „Norėtųsi sukurti arba panaudoti jau esamas tyrimuose aprašytas priemones ir stebėti ilgalaikį procesą“, – sako ji. Be to, mokslininkei būtų įdomūs tyrimai su vaikų grupėmis, nes jie galėtų suteikti dar daugiau naudingos informacijos apie vaikų matematinio samprotavimo ugdymą vyresniame amžiuje.
Mokiniams yra naudingos tos iliustracijos, kurios tikrai atspindi realią situaciją.
Tirti ir pradinukai, ir studentai
I. Kilienė yra atlikusi tyrimų ir su pradinių klasių mokiniais, ir su studentais, stebėjusi jų matematinio samprotavimo įgūdžius. Jos tyrimai sulaukė dėmesio ir tarptautiniu mastu: „Šį tyrimą pristačiau Europos matematikos mokymo kongrese. Daugumoje Europos šalių, kaip ir Lietuvoje, nėra skiriama dėmesio jaunesnių vaikų matematinio samprotavimo ugdymui. Europos tyrėjai sutinka, kad ši sritis labai svarbi ir būtina daugiau dėmesio skirti panašiems tyrimams.“
Paklausta, kaip tėvai reaguoja į galimybę ugdyti vaikų matematinius gebėjimus tokiame amžiuje, tyrėja sako, kad
reakcija dažnai priklauso nuo jų pačių santykio su matematika: „Jei tėvai nejaučia matematinio nerimo ir vertina matematiką kaip nesudėtingą mokslą, labai džiaugiasi galėdami juo dalintis su vaikais.“ Tačiau jei tėvai patys nemėgo matematikos, dažnai savo nerimu užkrečia ir vaikus. Vis dėlto, pabrėžia mokslininkė, dalintis savo nerimu nereikėtų, nes matematika gali būti įtrauki ir įdomi visiems, nepriklausomai nuo sudėtingų formulių ar teoremų.
I. Kilienės tyrimas parodė, kad ketverių metų vaikai gali spręsti matematikos uždavinius, jei jie pateikiami tinkama forma, naudojant iliustracijas ir paprastus žodžius. Tai atveria gali-
mybes tobulinti mokymo metodikas ir ugdymo programas, siekiant geriau paruošti vaikus žengti į matematikos pasaulį nuo ankstyviausio amžiaus. Tyrimo rezultatai skatina peržiūrėti ir pritaikyti ikimokyklinio ugdymo programas, kad vaikai nuo mažens būtų skatinami mąstyti matematiškai ir spręsti problemas kūrybiškai. Ir – kas ne mažiau svarbu – klausti „kodėl?“.

Vilniaus universiteto Istorijos fakultetas
Asmeniniame gyvenime mes nuolatos analizuojame praeities įvykius savęs klausdami: „Kas būtų buvę, jeigu...?“ Tačiau akademiniuose baruose šio klausimo beveik negirdime.
Lietuvos tyrėjai galėtų dažniau prisiminti ir savo moksliniuose darbuose pritaikyti šį paprastų mirtingųjų kasdienybėje naudojamą metodą, nes, pavyzdžiui, bet koks alternatyvų svarstymas istorijos moksle padeda iš arčiau pamatyti istorinių asmenybių dramas, sprendimus ar jų nebuvimą ir leidžia mums geriau suvokti istorinių pasiekimų svarbą šiandien.

Istorijoje atsitiktinumams nelieka vietos
Galime prisiminti ne vieną tokį klausimą, kurį sau kėlėme ir svarstėme asmeniniame kontekste. Kas būtų buvę, jei aš būčiau lankęs kitą mokyklą? O kas būtų atsitikę, jei aukštojoje mokykloje būčiau pasirinkęs studijuoti kitą programą? Ar mano gyvenimas būtų pasikeitęs, jei būčiau sutikęs ne šiuos, o kitus draugus, dėstytojus, kolegas? Kaip atrodytų mano dabartis, jei viename ar kitame praeities etape būčiau labiau pasistengęs, o gal atvirkščiai, atsipalaidavęs ir nieko pernelyg nedaręs? Ar mano finansinė situacija būtų kitokia, jei būčiau pasirašęs vieną ar kitą sutartį su kitokiais reikalavimais, investavęs į kitą sritį, priėmęs vieną ar kitą darbo pasiūlymą arba atvirkščiai – jų nepriėmęs? Apskritai, kiek mano gyvenime lemia apgalvoti ir valingi sprendimai, o kiek plaukimas pasroviui, pernelyg nesigilinant į konkrečią situaciją? Tai tik keletas iš šimtų galimų klausimų, kuriuos rečiau ar dažniau bendraudami su aplinkiniais ar susimąstydami pavieniui keliame sau (ir kitiems) kone kiekvieną dieną.
Ką jie rodo? Pirmiausia bendražmogišką prigimtį, o kalbant konkrečiau – kad beveik visomis gyvenimo akimirkomis, net ir specialiai nesusimąstydami, mes darome sprendimus, kurie daugiau ar mažiau lemia mūsų labai artimą, o gal ir tolimesnę ateitį. Apsvarstydami savo praeities pasirinkimus, mes juos analizuojame, vertiname, o kartais tiesiog prisimename ar jaučiame nostalgiją. Savo asmeninę praeitį mes neretai analizuojame gana lanksčiai, leidžiame sau
Patys mes kone kiekvieną
apsisprendžiame ir renkamės, o praeities žmogui to daryti neleidžiame.
net pasvarstyti apie tai, kas mums būtų nutikę, jei konkrečioje situacijoje būtume priėmęs kitokius sprendimus. Tačiau mąstydami apie platesnę istoriją, mes ją suvokiame gana schemiškai, alternatyvų jos veikėjams nesuteikiame. Rodosi, kad praeities politiniai lyderiai, mokslininkai ar menininkai ir net paprasti žmonės veikė pagal iš anksto nulemtas schemas, kurias istorijoje gana tiesmukai įvardijame kaip įvykių (procesų) priežastis ir pasekmes. Neretai istorijos vadovėliai, enciklopedijos ir populiarioji kino dokumentika praeities herojų gyvenimus taip pat įstato į šiuos rėmus. Faktiniu požiūriu tai yra konkreti ir teisinga informacija, tačiau joje pasimeta žmogaus sprendimai, abejonės, tinginystė, valia ar, priešingai, bėgimas nuo atsakomybės. Net atsitiktinumams, kurių pilnas mūsų gyvenimas, įvykio priežasties –įvykio – įvykio pasekmių linijoje nebelieka vietos. Taip istorijoje pametame žmogų ir jo unikalią (ne)apsisprendimų visumą. Patys mes kone kiekvieną akimirką apsisprendžiame ir renkamės, o praeities žmogui to daryti neleidžiame.
Antrasis pasaulinis karas galėjo baigtis liūdniau
Apie neįvykusią, alternatyvią ar kontrafaktinę istoriją yra parašyta šimtai grožinės literatūros kūrinių, kurie mums leidžia ne tik pajusti žmogiškosios vaizduotės galią, bet ir svarstyti tam tikrus istorinius-egzistencinius klausimus. Pavyzdžiui, 1992 m. rašytojo ir žurnalisto Roberto Harriso knygoje „Faterlandas“ („Fatherland“; lietuviškai ši knyga pasirodė 2005 m.) vaizduojama Vokietija ir Europa, kurioje Antrąjį pasaulinį
karą laimėjo ne sąjungininkų pajėgos, o naciai. Versdamas knygos puslapius esi priverstas susimąstyti apie blogio ašis, kurios be ryžtingo pasipriešinimo galėjo ir vis dar gali įsigalėti planetoje. Jei ne atskirų lyderių ar šimtų didvyrių ryžtas, Antrasis pasaulinis karas iš tikro galėjo pasibaigti kitaip. Alternatyvioji istorija „Faterlande“ žadina mūsų atsakomybę grėsmių akivaizdoje šiandieniniame pasaulyje – ar padarėme viską, kad alternatyvūs ir liūdni istorijos scenarijai neišsipildytų netolimoje ateityje?
2019 m. prancūzų rašytojas Laurent'as Binet išleido romaną „Civilizacijos“ („Civilizations“), kuriame plėtoja alternatyviosios istorijos scenarijų pasakodamas apie „atvirkštinę kolonizaciją“. XVI a. įspūdingą naujų pasaulių kolonizaciją ima vykdyti ne ispanai ar portugalai, o inkai, kurie atplaukia į Europą ir ją po truputį užvaldo. Skaitant romaną galima matyti tam tikrą veidrodinį principą – daugelis procesų, kurie vyko ispanų kolonizuojamoje Centrinėje ir Pietų Amerikoje, alternatyviame siužete vyksta Europoje, o tai romano puslapiuose smarkiai keičia Senojo žemyno istoriją. Kokią žinią galėtų siųsti šis, atrodytų, išties beprotiškas pasakojimas? Akivaizdu, kad jis verčia susimąstyti apie europocentrizmo ir kolonializmo patirtis ir pasekmes XX–XXI a. istorijai ir mūsų dabarčiai.
Prie alternatyviosios istorijos žanro ar net tyrimų yra prisidėję ir patys istorikai. Vadovaudamiesi tam tikrų istorinių analogijų principu, nagrinėdami parengtus, tačiau dėl įvairių priežasčių (pavyzdžiui, dėl okupacijos) nutrauktus politinius, ekonominius, architektūrinius planus, programas, koncepcijas, vizijas ar net remdamiesi

dalis. Nuotraukoje vaizduojamos Vytauto Didžiojo mirties 500 metų minėjimo iškilmės Panevėžyje, Laisvės aikštėje, 1930 m. rugsėjo 8 d. Nuotrauka saugoma Panevėžio kraštotyros muziejuje
griežtai ekonominiais skaičiavimais, mokslininkai gali sudėlioti tam tikras alternatyvas iš tikro nutikusiems įvykiams. Akivaizdu, kad tai nėra ir nebus esminis istorijos tyrimų objektas, tačiau numoti į tai ranka taip pat nereikėtų. Taikliai yra pasakęs kultūros istorikas Aurimas Švedas: „Istorija yra neišsipildžiusių alternatyvų seka. Dėl to praeities tyrinėtojas negalėtų paaiškinti, kaip ir kodėl nutiko tam tikri dalykai, jeigu nemokėtų operuoti alternatyvomis. Kitaip sakant, tam, kad suprastume, kaip buvo iš tikrųjų, mes visų pirma turime suprasti, kaip nenutiko.“
Jei Vytautas būtų tapęs karaliumi?
Gali pasirodyti netikėta, tačiau neįvykusi istorija yra labai svarbi XX–XXI a. Lietuvos atminties kultūrai. Pavyzdžiui, tarpukariu viena svarbiausių valstybinių šalies švenčių buvo rugsėjo 8-oji – Vytauto Didžiojo neįvykusio karūnavimo diena (sutapusi su Švč. Mergelės Marijos gimimo diena).
Pagreitį šios dienos minėjimo tradicija įgavo 1930 m., kai buvo minima 500 metų sukaktis nuo tos dienos, kada turėjo būti vainikuotas didysis Lietuvos kunigaikštis Vytautas. Yra
Ar padarėme viską, kad alternatyvūs ir liūdni istorijos scenarijai neišsipildytų netolimoje ateityje?
žinoma, kad 1430 m. rugsėjo 8 d. buvo planuojamas Vytauto Didžiojo karūnavimas, tačiau šis epochinis įvykis buvo sužlugdytas politinių intrigų, o netrukus, spalio pabaigoje, nesulaukęs karūnos valdovas mirė. Neįvykęs karūnavimas, lenkų ponų pagrobta karūna žadino ne tik pasididžiavimą senąja valstybe, Vilniaus netekimo kontekste stiprino antilenkiškas nuotaikas, bet ir kėlė visuotinius jausmus, kurie buvo pagrįsti alternatyviai susiklosčiusios istorijos scenarijais. Ne vienas to meto Lietuvos visuomenės narys pasvajodavo: o jei Vytautas būtų tapęs karaliumi, kaip būtų pasikeitusi
Lietuva, galbūt ji būtų ilgiau išlaikiusi savo didybę, tariamą lietuviškumą ir nepriklausomumą nuo Lenkijos? Gal ją būtų aplenkusios vėlesnės geopolitinės negandos? Taigi dalis to meto patriotinės savivokos buvo pagrįsta ne tik realia, bet ir neįvykusia istorija. Tai nėra vienintelis atvejis, kai alternatyvi istorija tampa svarbia mūsų kultūrinės savasties dalimi. 1940-ųjų ginkluoto nepasipriešinimo sovietams istorija tapo akstinu aštrioms diskusijoms išeivijoje – garsūs lietuvių emigrantai ginčijosi, kas kaltas dėl „neiššauto šūvio“, aptarinėjo alternatyvas, svarstė, kas būtų pasikeitę, jei sovietams būtų buvę pasipriešinta ginklu. Panašios diskusijos persikėlė ir į 1944–1953 m. partizanų karo gretas ir ypač į viešąją erdvę po Kovo 11-osios. Ne itin pagrįsta savigrauža ir alternatyvų 1940-ųjų vasaros įvykiams paieškos aktyviai tęsiasi iki šiandien. Apmąstant Antrąjį pasaulinį karą ir Lietuvos situaciją kartais svarstomas (net profesionalių tyrėjų) klausimas, ar nederėjo Lietuvai atsiliepti į Vokietijos kvietimą ir 1939 m. rugsėjį prisidėti prie Lenkijos kampanijos mėginant ginkluota jėga atsiimti Vilnių. Gal
tuomet per karą Lietuva būtų išvengusi savo likimo ir galiausiai tapusi ne SSRS, o bent socialistinio bloko dalimi? Šiose diskusijose apie galimas alternatyvas istorikai gana vieningai sako, kad toks žingsnis būtų buvęs neapgalvotas ir klaidingas, jis ne tik nebūtų pagerinęs istorinės eigos, bet ir dar labiau ją komplikavęs. Šis klausimas svarbus ir moraliniu aspektu: ar moralu yra plėtoti neįvykusios istorijos faktą, kuris reiškia kaimyninės valstybės užpuolimą ir prisidėjimą prie Antrojo pasaulinio karo sukėlėjų? Taigi alternatyva praeities tyrėjų neatleidžia nuo atsakomybės vertinant praeitį bendražmogiškųjų vertybių kontekste.
Geriau suvokiame istorinių pasiekimų svarbą
Kasmet minint Sausio 13-ąją iškyla šiurpulį keliantis klausimas: o kas būtų nutikę, jei 1991 m. pradžioje sovietų pajėgos būtų šturmavusios parlamentą? Ar Lietuva ir jos žmonės būtų atsilaikę? Kaip būtų susiklostęs mūsų likimas šiandien, parlamentui kritus? Šiais metais minint Lietuvos įstojimo į ES ir NATO dvidešimtmetį, be kita ko,
Kartais tik matydami šiurpias alternatyvas mes geriau suvokiame padarytų darbų svarbą.

kairės į dešinę: Antanas Gabrys-Klajūnas, Vytautas Balčikonis-Gražukas, Žaliosios rinktinės partizanai.
Stanislovo Bagdonavičiaus kolekcijos

1991 m. sausio 13-osios reikšmę savo valstybingumui galime išryškinti keldami pagrįstą klausimą: kas būtų nutikę, jei anuomet sovietai būtų puolę ir užgrobę Lietuvos parlamentą? Romualdo Požerskio nuotr.
Tarpukariu viena svarbiausių valstybinių šalies švenčių buvo rugsėjo 8-oji –Vytauto Didžiojo neįvykusio karūnavimo diena.
buvo keliamas klausimas: o kas būtų atsitikę, jei mūsų valstybė būtų pavėlavusi į euroatlantinius integracijos procesus, juk sėkmė stojant į šias organizacijas toli gražu nebuvo užprogramuota? Alternatyvių scenarijų svarstymas ar bent jau paminėjimas Sausio 13-osios ir euroatlantinės integracijos atveju ne tik tenkina tam tikrą mūsų smalsumą ar kelia pagrįstą šiurpą, kad viskas galėjo susiklostyti ir kitaip, bet ir, svarbiausia, sureikšmina pačius Lietuvos valstybės ir visuomenės pasiekimus. Taigi alternatyvioji istorija mums leidžia ne tik intelektualiai pramogauti, bet ir labiau sureikšminti konkrečius istorinius pasiekimus, įvertinti atskirų politikų, diplomatų ar visuomenininkų darbą. Kartais tik matydami šiurpias alternatyvas mes geriau suvokiame padarytų darbų svarbą.
Iš pateiktų ar numanomų pavyzdžių galime matyti, kad alternatyvioji istorija yra ne tik vaizduotę žadinantis bei mankštinantis žanras – ji atlieka nepaprastai svarbią funkciją ir istorinės kultūros požiūriu, ir vertinant isto-
rinių asmenybių sprendimus, ir apskritai kalbant apie laisvos valios principą, kuris išlieka svarbiu vakarietiškos kultūrinės tapatybės dėmeniu. Be to, praeities alternatyvų svarstymas nėra tik rašytojų ar istorikų profesinio lauko sudedamoji dalis. Juk nuo profesionalių karininkų rengimo iki finansinio investavimo pradmenų mokymo praeities sprendimų ir jų alternatyvų analizė sudaro esminę dalį specializuoto žinojimo apie dabartį ir net ateitį. Tačiau svarbiausia, kad profesionalus kalbėjimas apie tai, kas neįvyko, ugdo mūsų istorinę vaizduotę, kurios, skirtingai nei istorinių žinių, vis dar stokojame. Taigi mąstymas apie neįvykusią istoriją tiek asmeniniame, tiek platesniame kontekste stiprina mūsų intelektinę sveikatą. Mankštintis profesionaliomis literatūrinėmis ar istorinėmis alternatyvomis – sveika ir naudinga ne tik bręstančiam organizmui.

Mantas Vaišvilas
Vilniaus universiteto Medicinos fakultetas
Neurologinės ligos, pradedant migrena ir baigiant sunkesnėmis ligomis, tokiomis kaip Parkinsono liga, Alzheimerio demencija, išsėtinė sklerozė, kelia vis daugiau problemų visame pasaulyje, nes didžioji jų dalis yra greitai progresuojančios ir nepagydomos. Tačiau tarp šių nepagydomų ligų yra ir tokių, kurias pagydyti įmanoma, tik sunku diagnozuoti ir laiku suteikti pagalbą, nes jų simptomai labai panašūs į kitų minėtų nervų sistemos ligų simptomus. Viena tokių pagydomų ligų yra autoimuninis encefalitas, kurį sukelia antikūnai, nukreipti prieš žmogaus nervų sistemos struktūras. Siekdami pagerinti autoimuninio encefalito diagnostikos galimybes, Vilniaus universiteto medikai tiria pelių smegenis, kad surastų šios ligos priežastį – antikūną, sukeliantį nervų sistemos pažeidimą.


Ilgai nepavyko nustatyti nervų sistemos ligų priežasčių
Diagnozuoti tiek nepagydomas, tiek retas pagydomas nervų sistemos ligas iš dalies yra sudėtinga dėl to, kad įžvalgas apie nervų sistemos struktūrą, jos normalią ir anomalią veiklą neurologijos praktikoje galima daryti tik makroskopiniu lygmeniu. Mikroskopinė ir molekulinė nervų sistemos struktūros, jų pokyčiai ir molekuliniai ligų mechanizmai tam tikrų neurologinių ligų kontekste lieka terra incognita. Vienos pirmųjų molekulinių ligos išsivystymo hipotezių neurologijos ir psichiatrijos moksle teigė, kad neurologines, ypač psichiatrines, ligas sukelia imuninės sistemos gaminami baltymai – antikūnai. Šios hipotezės kilo psichiatrams diskutuojant apie galimą šizofrenijos kilmę. Galvota, kad antikūnai, kurie normaliomis aplinkybėmis kovoja su infekcijomis, susidarius tam tikroms sąlygoms pradeda kovoti su sveikais šeimininko organizmo audiniais, sukeldami šių audinių uždegimą ir ligos simptomus. Tai – ligų, vadinamų autoimuninėmis, koncepcija. Nors diskusijų, genetinių ir epidemiologinių tyrimų šiai hipotezei patvirtinti būta daug, konkrečių antikūnų,
sukeliančių šizofreniją, kitas psichiatrines ar daugelį lėtinių degeneracinių nervų sistemos ligų, ilgą laiką nustatyti nepavyko.
Viskas iš esmės pasikeitė XXI a. pradžioje, kai gydytojai Vakarų Europoje ir Jungtinėse Amerikos Valstijose tyrė ir gydė jaunas moteris, kurios neturėjo jokių kitų susirgimų iki nežinomos ligos pradžios. Visoms joms pasireiškė labai panašūs simptomai ir analogiška ligos eiga. Susirgimo pradžioje labai greitai išsivystydavo į šizofreniją panašūs simptomai, kuriuos lydėdavo sąmonės sutrikimas, kvėpavimo sustojimas, epilepsija, trumpalaikės atminties sutrikimai ir pan. Pacientės būdavo labai sunkios būklės, gydomos intensyviosios terapijos skyriuose, naudojant pagalbines priemones gyvybinėms funkcijoms palaikyti. Liga apibūdinta kaip nežinomos kilmės smegenų uždegimas, arba encefalitas. Nepaisant tuo metu prieinamų išsamių tyrimų, nei liga, nei ligos priežastis nebuvo išaiškinta. Grįžta prie molekulinės antikūnų sukeliamų ligų hipotezės, todėl dauguma prieš tai sunkiai sirgusių moterų, turėjusių šizofrenijos, demencijos, epilepsijos ir kitų simptomų, pasveiko taikant imunitetą ir antikūnų gamybą slopi-
Nedidelė dalis pacientų iš plataus nepagydomų neurodegeneracinių ligų spektro serga potencialiai pagydoma liga.
nantį gydymą, tokį, koks buvo taikomas ir gydant kitas autoimunines ligas. Pristačius šių atvejų simptomus ir gydymo rezultatus tarptautinėje erdvėje, paaiškėjo, kad su nežinoma sunkios eigos liga, besirenkančia moteriškąją lytį, yra susidūrę gydytojai ir tyrėjai iš daugelio pasaulio valstybių. Surinktus sergančių žmonių mėginius mokslininkai ištyrė panaudodami specialiai paruoštus pelių smegenų pjūvius, dėl cheminių reakcijų pritaikytus antikūnams pamatyti.
Pirmą kartą tiek plika akimi, tiek pro mikroskopą buvo galima įžiūrėti graužikų smegenų struktūras, su kuriomis antikūnai reaguodavo. Tolesni, pomirtiniai, nežinomos kilmės encefalitu sirgusių pacienčių tyrimai parodė, kad uždegimo paveiktos žmogaus smegenų sritys beveik identiškai
atitinka paveiktas graužiko smegenų struktūras, matomas pro mikroskopą. Pasidarė aišku, kad antikūnai turi molekulinį taikinį.
Kaip atskirti pagydomas nervų sistemos ligas?
Dabar ši liga žinoma kaip NMDA receptorių encefalitas. Tai viena iš keliolikos labai retų žmogaus sveikatos būklių, vadinamų autoimuniniais encefalitais, kurias sukelia antikūnai, kovojantys prieš žmogaus nervų sistemos struktūras. Autoimuninius encefalitus sukeliančių antikūnų nustatymas mokslo laboratorijose atvėrė duris naujai mokslinei ir praktinei medicinos krypčiai, vadinamai neuroimunologija.
Ilgainiui, plėtojantis neuroimunologijai, pavyko suprasti, kad nors ir nedidelei, tačiau reikšmingai daliai pacientų, kuriems atsirado į Alzheimerio ar Parkinsono ligas, šizofreniją ar epilepsiją panašūs simptomai, galima nustatyti simptomus sukeliančius antikūnus ir sėkmingai taikyti gydymą, tikintis, kad žmogus iš dalies ar visiškai pasveiks. Kitaip sakant, nedidelė dalis pacientų iš plataus nepagydomų neurodegeneracinių ligų spektro serga potencialiai pagydoma liga – autoimuniniu encefalitu, savo simptomais primenančiu minėtas nervų sistemos ligas. Gali kilti klausimas – kaip iš daugybės nepagydomomis neurologinėmis ligomis sergančių pacientų atrinkti tuos, kurių liga yra pagydoma?

NMDA receptorių encefalito vaizdas ant graužiko audinio. Atvaizduota švytinti smegenų struktūra vadinama hipokampu. Jo pažeidimas sukelia pagrindinius NMDA encefalito simptomus – psichozę, atminties sutrikimus ir traukulius. Manto Vaišvilo nuotr.
Šis
tyrimas gali
būti svarbus vėžiu sergantiems asmenims parenkant gydymą.
Klinikinėje praktikoje pradėti vykdyti tyrimai, leidžiantys nustatyti dalį antikūnų, galinčių sukelti autoimuninį encefalitą. Imtos taikyti kiek kitokios nei įprastai, daug paprastesnės metodikos šiems antikūnams nustatyti, siekiant pagerinti ir pagreitinti šių ligų diagnostiką. Nors tai buvo savotiškas medicinos mokslo perversmas, greitai suprasta, kad esamų tyrimų nepakanka, nes jie leidžia nustatyti tik labai ribotą antikūnų skaičių, o dalis tyrimų yra tokie netikslūs, kad apskritai neatskiria sveiko asmens nuo sergančio.
Pirmieji Baltijos šalyse pritaikėme patobulintą metodiką
Graužiko smegenų audinio tyrimai, skirti antikūnams nustatyti, yra laikomi aukso standartu diagnozuojant NMDA receptorių encefalitą, tačiau klinikinėje praktikoje nėra taikomi, nes paruošti smegenų audinį ir gauti patikimus rezultatus yra labai sudėtinga. Tačiau su šioje srityje dirbančiais kolegomis greitai supratome, kad kai kuriais atvejais ši metodika yra vienintelė, ir ėmėmės ją tobulinti.
Maždaug prieš metus pirmieji Baltijos šalyse pradėjome pelių smegenų audinio tyrimus taikydami tik keliolikoje pasaulio šalių naudojamą graužikų smegenų paruošimo metodiką. Paprastai sakant, paruoštus labai plonus graužiko smegenų pjūvius, naudodami daugybę cheminių reak-
cijų, sujungiame paciento, kuriam įtariamas autoimuninis encefalitas, biologine medžiaga, dažniausiai smegenų skysčiu. Jeigu biologinėje medžiagoje yra antikūnas, graužiko smegenyse jis randa savo taikinį, kurį vadiname antigenu ir kuris sudaro antikūno ir antigeno kompleksą. Kiekvienas toks kompleksas unikalus, t. y. vienas konkretus antikūnas reaguoja su vienu konkrečiu antigenu „rakto ir spynos“ principu. Kad pamatytume, ar tariama „rakto ir spynos“ reakcija įvyko, prijungiame papildomą antikūną, kuris atpažįsta žmogaus antikūnus. Šis antikūnas, vadinamas antriniu, paprastai turi fluorescencinių savybių, o tai reiškia, kad, apšvietę tam tikro šviesos spektro spinduliais tokį antigeno, antikūno ir antrinio antikūno kompleksą, matysime šio komplekso švytėjimą. Iš to, kókios struktūros graužiko smegenyse švyti, galime spręsti apie tai, koks antikūnas yra biologinėje medžiagoje.
Pirmą kartą Lietuvoje diagnozuota reta liga
Pradiniai graužikų smegenų audinio tyrimų rezultatai buvo džiuginantys. Vienas pirmųjų mėginių, kurie tirti šia metodika, buvo paimtas iš paciento, sergančio nežinomos kilmės labai greitai progresuojančiu koordinacijos sutrikimu. Visi įmanomi antikūnų ir vaizdiniai tyrimai susirgimo priežas-


Graužiko smegenų vaizdas pro plataus lauko mikroskopą. Viktorijos Kralikienės ir Manto Vaišvilo nuotr.

ties nepadėjo nustatyti, o prieš kelias savaites buvusio sveiko, darbingo amžiaus paciento būklė staigiai blogėjo – dėl smarkiai sutrikusios koordinacijos jis nebegalėjo savarankiškai atsikelti iš lovos ir vaikščioti.
Tik pritaikę graužiko smegenų antikūnų nustatymo metodiką pamatėme susirgimo priežastį – antikūną, sukeliantį nervų sistemos pažeidimą. Svarbu pažymėti, kad kai kurie antikūnai žmogaus organizme formuojasi kaip imuninės sistemos atsakas į onkologinę ligą. Vėžinės ląstelės tokiais atvejais savo paviršiuje turi identiškus nervų sistemai antigenus, todėl susiformavę antikūnai paskatina kovą ne tik su navikiniu, bet ir su sveiku žmogaus nervų sistemos audiniu. Tokias klinikines situacijas vadiname paraneoplastiniais neurologiniais sindromais. Tai reiškia, kad tam tikrų antikūnų nustatymas gydytojams yra labai stiprus indikatorius ieškoti galimos onkologinės ligos. Taip nutiko ir šio paciento atveju. Atradę antikūną, žinojome, ko tiksliai ieškoti ir kur. Taigi šis vienas tyrimas padėjo nustatyti dvi ligas – autoimuninį encefalitą ir jo atsiradimo priežastį – onkologinę ligą, kuri buvo diagnozuota laiku ir pacien-
tas sėkmingai išgydytas. Negana to, toks antikūnas neabejotinai nustatytas pirmą kartą Lietuvoje, tikėtina, ir Baltijos šalyse, o pasaulyje tokių atvejų aprašyta mažiau nei 100. Taigi galima sakyti, kad dėl šių tyrimų Lietuvoje buvo diagnozuota nauja liga.
Pacientas metus laukė diagnozės, kuri buvo nustatyta per dvi dienas
Kitas pacientas, kuriam buvo pritaikyta graužiko smegenų antikūnų nustatymo metodika, buvo tiriamas metus laiko, bet net po daugybės kartotinių tyrimų, taikyto įvairaus pobūdžio gydymo ir mėnesių, praleistų ligoninės stacionaruose ir reabilitacijos skyriuose, nepavyko nustatyti ligos diagnozės. Pacientas diagnozės laukė daugiau nei metus, o tikslią ligos priežastį nustatėme per dvi dienas – tiek trunka paruošti mėginį iki jo peržiūros mikroskopu.
Iš pateiktų pavyzdžių aišku, kad naudojama metodika, nors ir turi daug potencialo, dar yra labiau mokslo objektas nei kasdienė medicininė praktika. Tačiau tikimasi, kad ši metodika bus tobulinama ir ateityje ją bus galima taikyti praktikoje plačiau.
Didelė dalis neurologinio ir psichiatrinio profilio ligų, tokių kaip epilepsija, demencija, judėjimo sutrikimai ar psichozės, yra progresuojančios ir nepagydomos, tačiau nedidelei daliai pacientų šias lėtines ligas primenančius simptomus sukelia jų pačių imuninės sistemos gaminami antikūnai. Atrandame daugiau galimybių ir tyrimo metodikų šiems antikūnams nustatyti, o tai padeda nors nedidelei, bet reikšmingai daliai pacientų kardinaliai keisti gydymą ir suteikia vilties pasveikti.
Svarbiausia, kad, panaudoję šią metodiką ir nustatę antikūną, veikiantį prieš žmogaus nervų sistemos struktūras, galime numatyti, ar autoimuninį encefalitą sukėlė vėžys, ir jeigu taip – kur jo ieškoti, kol jis dar labai ankstyvos stadijos. Šis tyrimas gali būti svarbus vėžiu sergantiems asmenims parenkant gydymą. Dalis preparatų nuo vėžio veikia skatindami žmogaus imuninę sistemą vėžį naikinti. Retos, bet galimos tokio gydymo komplikacijos yra autoimuniniai encefalitai. Tokiais atvejais galima metodiką naudoti antikūno tipui tikslinti ir gydymui koreguoti.

Kauno hipiai. Tapatybės paieškos 1966–1972
Egidija Ramanauskaitė
Monografijoje analizuojami sovietmečio Kauno hipių grupės „Company“ atsiradimo ir tapatybės formavimosi veiksniai, atskleidę platesnius alternatyviosios to laikotarpio kultūros procesus. Tie, kurie domisi sovietmečio jaunimo kultūros procesais, knygoje ras faktų apie socialinį sovietmečio kontekstą, paskatinusį naujų jaunimo kultūros formų atsiradimą ir veikusį jų kaitą. Pedagogai ir socialiniai darbuotojai knygoje gali aptikti įžvalgų apie jaunimo poreikį burtis į alternatyvias grupes ir formuoti savo, skirtingą nuo aplinkos, tapatybę.

Nėra to blogo, kas neišeitų į gera?
Reikšmingų įvykių įtaka viešosios politikos kaitai Lietuvoje 2004–2020 m.
Rasa Bortkevičiūtė, Vitalis Nakrošis, Inga Patkauskaitė-Tiuchtienė, Ramūnas Vilpišauskas Kodėl kartais net didžiulę žalą sukėlę reikšmingi įvykiai nesulaukia didesnio visuomenės, žiniasklaidos ar politikų dėmesio, o nedidelio masto ar keletą kartų pasikartojančios nelaimės išprovokuoja esminius viešosios politikos pokyčius? Remdamiesi originaliu teoriniu požiūriu, monografijos autoriai siekia atskleisti vis aktualesniu tampantį reikšmingų įvykių ir jų paskatintos viešosios politikos kaitos ryšį. Monografijoje pristatomas unikalus duomenų apie Lietuvoje 2004–2020 m. vykusius reikšmingus įvykius rinkinys ir pateikiamos išvados dėl atsparumo ateities sisteminėms grėsmėms didinimo.

Žurnalistų laisvė, saugumas ir įtakos
Deimantas Jastramskis, Giedrė
Plepytė-Davidavičienė, Rūta Kupetytė, Ingrida Gečienė-Janulionė
Mokslininkų komanda nagrinėja Lietuvos žurnalistikos situaciją politinių, ekonominių ir socialinių rizikų kontekste. Remdamiesi nacionalinės žurnalistų apklausos duomenimis, knygos autoriai išsamiai analizuoja žurnalistų suvokimą apie darbo sąlygas, įvairaus pobūdžio įtakas, redakcinę autonomiją, žurnalistinius vaidmenis, profesinę etiką ir veiklos saugumą.

Giedrė Piličiauskienė, Povilas Blaževičius, Toma Zarankaitė-Margienė
Skaitant šią knygą galima sužinoti, kuo skyrėsi viduramžiais ir naujaisiais laikais auginti šunys. Mokslininkai pateikia atsakymą, kodėl maždaug nuo XVIII a. nebeaptinkame didžiausiųjų šunų, kurių buvo gausu viduramžiais, kaip skyrėsi pilyse ir miestuose gyvenusių keturkojų sveikata, mityba ir gyvenimo sąlygos. Išsamūs tyrimų rezultatai leidžia pažinti šunų laidojimo tradicijas, sužinoti, kaip vykdavo medžioklės, kaip atrodė ir kokiomis savybėmis pasižymėjo medžiokliniai šunys, kodėl jų buvo nevalia pardavinėti.

Vietos visuomenė ir valdžia. Tarpusavio sąveikos. Šiaulių ekonomijos atvejis. XVII–XVIII a. pradžia
Rita Regina Trimonienė
Monografijoje autorė daugiausia dėmesio skiria teisiškai fiksuotai ir geografinėmis ribomis apibrėžtai karališkosios Šiaulių ekonomijos mikrobendruomenei. Jos valdiniai turėjo daug daugiau galimybių artikuliuotai išreikšti ir ginti savo interesus negu privačių dvarų valstiečiai ir miestelėnai. Gausūs išlikę šaltiniai (inventoriai, dvaro teismo knygos, įvairūs dvaro valdytojų dokumentai, bažnytiniai metrikai, to meto literatūros kūriniai ir kt.), esantys Lietuvos ir užsienio archyvuose, pasirinktos socialinės antropologijos, naujos politinės istorijos ir mikroistorijos prieigos leido įsigilinti ir išanalizuoti daugiasluoksnę bendruomenę, jos tarpusavio ryšius, saviidentifikaciją.

Thomas D. Wilson
Ši knyga yra įvadas į žmogaus informacinės elgsenos tyrimus, o kartu – jos autoriaus, vieno įtakingiausių pasaulyje informacinės elgsenos tyrėjų, Jungtinės Karalystės Šefildo universiteto profesoriaus emerito Thomo Wilsono asmeniškas pasakojimas apie savo teorinius svarstymus, atliktus tyrimus ir diskusijas su kolegomis iš viso pasaulio. Autorius yra ne kartą lankęsis Lietuvoje, Vilniaus universiteto Komunikacijos fakultete atliko bendrus tyrimus ir skaitė paskaitas studentams. Knyga skiriama jauniesiems tyrėjams, taip pat visiems, kuriuos domina žmogaus elgsena skaitmenizuotame informacijos pasaulyje.

Pirmiausia aš buvau mokytojas...
Sudarė ir redagavo Regina Venckutė
Knyga skiriama Vilniaus universiteto docento Jono Zemvaldo Balkevičiaus (1923–2000) atminimui. Į ją sudėti periodinėje spaudoje skelbti pokalbiai, šeimos narių, bičiulių, buvusių kolegų ir studentų atsiminimai, draugams rašytų ir oficialių laiškų pluoštas atskleidžia J. Balkevičiaus gyvenimo faktus ir įvairialypę kūrybinę veiklą: puikus pedagogas, įžvalgus lietuvių kalbos sintaksės tyrėjas, lietuvių ir latvių kalbų žodynų autorius, idėjų kupinas organizatorius, nepamirštamas filologų prodekanas ir dekanas, iki sielos gelmių universitetui atsidavęs žmogus.

modeliai. Grimzdimas
Irina Melnikova, Jurgita Katkuvienė, Silvi Salupere
Autorės konstruoja skaitymo logiką aiškinančius – Charleso S. Peirce’o, Jurijaus Lotmano ir Algirdo Juliaus Greimo semiotikų idėjomis grįstus – teorinius modelius ir modeliuoja tris Gyčio Norvilo poezijos rinkinio „Grimzdimas“ (2017) skaitymo variantus. Knygoje aptariama, kaip skirtingų semiotikų požiūriu gali būti suvokiamas skaitymas, kuo pasižymi skirtingos semiotinės prieigos, kaip prieigų ypatumai kreipia „Grimzdimo“ skaitymą, leidžiantį atverti poezijos rinkinio (reikšmių) gelmes ir nubrėžti semiotinių teorijų susitikimo ir išsiskyrimo trajektorijas.

Sudarė Eugenijus Saviščevas Ši knyga – tai mokslinių straipsnių rinkinys, skirtas profesorės Irenos Valikonytės 75 metų jubiliejui. Rinkinyje skelbiama 18 straipsnių, parašytų 19 autorių iš Lietuvos, Lenkijos ir Ukrainos. Juose tyrinėjami įvairūs Lietuvos Didžiosios Kunigaikštystės istorijos objektai. Šalia tyrimų pateikiamas interviu, kuriame prof. I. Valikonytė pasakoja apie savo asmeninį ir mokslinį kelią.

Lilija Duoblienė, Jogaila Vaitekaitis, Simona Kontrimienė, Justina Garbauskaitė-Jakimovska, Sandra Kairė
Knygoje, apžvelgiant bendrojo lavinimo mokyklos kaitą, siekiama projektuoti ateitį, o ne diagnozuoti praeities ir dabarties pokyčius. Norima užčiuopti jau potencialiai ar kol kas tik virtualiai švietimo lauke išskirtinas ateities įžvalgas –sąmoningas ir pasąmoningas, keliant klausimus: kur link pasuks Lietuvos bendrojo ugdymo mokykla, kiek ji seks esamomis kitų šalių trajektorijomis, o kiek rinksis savitą būdą, priklausomą nuo šalies sociokultūrinio konteksto ir globalių iššūkių gyventi antropocene? Pateikiami Lietuvos mokyklos ateities scenarijai, atskleidžiamas Lietuvos švietimo ekspertų samprotavimų, požiūrių, vertybių paveikslas.
Dr. Lina Bivainienė
Doc. Miglė Eleonora Černikovaitė
Vilniaus universiteto Komunikacijos fakultetas
Kaip paversti miestą iš nieko nesakančios vietovės į patrauklią ir noriai lankomą vietą? Ne vienas pasaulio miestas šito siekia kurdamas savo prekių ženklą. Stiprus miesto identitetas stiprina bendruomenes, didina turistų srautus ir skatina ekonomiką. Vilnius – ne išimtis. Kviečiame panagrinėti, kada humoru paremtos kampanijos pasiteisina, o kada – ne.


Humoras kaip universali prekių ženklo kūrimo strategija
Humoras gali padėti išlaikyti vartotojų lojalumą ir sustiprinti prekių ženklo reputaciją.
Humoras kuriant prekių ženklus, reklamas ar identitetą padeda užmegzti emocinį ryšį su vartotojais ir padidina prekių ženklo įsimenamumą. Miestą su visa jo istorija ir infrastruktūra dažnai suvokiame kaip gyvą organizmą, priskiriame jam žmogiškų savybių – personifikuojame. Automatiškai priskiriame ir emocijas. Jos susijusios su mūsų žmogiškąja patirtimi, o tikslas – duoti toną, kokias emocijas miesto prekių ženklu norime perteikti savo auditorijai.
Kadangi besišypsantis ar juokaujantis žmogus mums visada yra patrauklesnis negu niūrus, pernelyg rimtas ir solidus, panašių emocijų ieškome ir miestui. Juk daug lengviau yra tapatintis su teigiama emocija. Tokia reklama a priori turi didelį potencialą, ją labiau norėsis žiūrėti, ja dalintis ir didžiuotis – juk smagu būti iš miesto, kuris šypsosi.
Humoras taip pat gali padėti išlaikyti vartotojų lojalumą ir sustiprinti prekių ženklo reputaciją. Kompanijos, kurios naudoja humoro elementus savo reklaminėse kampanijose ar prekių dizaine, dažnai yra suvokiamos kaip artimesnės vartotojams ir geriau įsimenamos. Be to, tai pritraukia daugiau socialinės žiniasklaidos dėmesio, nes vartotojai dažnai dalinasi juokingomis reklamomis su draugais.
Humoras kaip įrankis kuriant prekių ženklus ir reklamą – jokia naujiena. Pasaulyje pilna sėkmingų kampanijų, puikiai integruojančių humorą. Pavyzdžiui, 2016 m. po Donaldo Trumpo reklaminės kampanijos „America First“ po pasaulį nuvilnijo parodijuojantys vaizdo klipai, kuriuose su humoru, ironiškai vaizduojama šalių konkurencija dėl pasaulinio dominavimo. Humoras juose pasitelkiamas parodyti, kad šūkis „America First“ gali būti suvokiamas kaip nepagrįstas ar
absurdiškas, ir kartu drąsiai pristatyti savo šalį, nebijant stereotipų ir saviironijos. Tačiau čia priartėjame prie Vilniaus dilemos.
Naujoji Vilniaus kampanija – kas ir kaip suprato humorą?
Šį pavasarį Vilniaus verslo plėtros ir turizmo agentūros „Go Vilnius“ pristatyta Vilniaus reklaminė kampanija turėjo didinti miesto žinomumą tikslinėse turizmo rinkose – Didžiojoje Britanijoje ir Vokietijoje, tačiau sukėlė pasipiktinimo bangą tarp vietinės auditorijos.
Atstovai teigė, kad ši kampanija meta iššūkį įsisenėjusiems stereotipams
ne tik apie Vilnių, bet ir apie visą Rytų Europos regioną. Tačiau vietiniame kontekste su šiuo sarkazmu buvo sunku tapatintis. O teiginys, kad reklama skirta ne vietinei auditorijai – vargiai įtikina, nes viskas vyksta ne vakuume ir tą, kas skirta vienai auditorijai, mato ir kita.
Teoriniu požiūriu tai pavyzdys, kaip į miesto rinkodarą žvelgiama per prekių ženklą. Išgrynintos tikslinės auditorijos ir orientuotasi būtent į tikslines grupes – britus, vokiečius. Be to, pasiremta populiaria tendencija – 90-inių stilistika, pridedant humoro ir per daug nemąstant. Vis dėlto komunikaciniu požiūriu kuriant miesto įvaizdį svarbu, kad būtų pažvelgta iš įvairių
suinteresuotų grupių perspektyvos: tiek turistų, tiek vietos bendruomenių, verslininkų, galiausiai – pačios savivaldos atstovų. Svarbu, kokias emocijas ir kam sukelia su humoru sukurta reklaminė kampanija.
Naudoti humorą miesto reklaminei kampanijai gali būti rizikinga, nes ne visi gali gerai priimti tam tikrus juokelius ar ant absurdo ribos balansuojančias reklamas. Todėl svarbu atidžiai apsvarstyti humoro elementų įtraukimą kuriant prekių ženklą ir užtikrinti, kad šie elementai atspindėtų miesto vertybes ir tikslus.
Miesto prekių ženklas turėtų būti įtraukiantis ir įdomus visiems, ne vien tikslinei auditorijai. Tačiau dažnai į miestą


žiūrima per siaurai – tik kaip į prekę. Užtai ir kyla nesusipratimų – vieni tokį humorą suprato, kiti ne. Vis dėlto humoras turi tikti visoms auditorijoms. Šiuo atveju neatrodė nei juokinga, nei linksma, o daugeliui net ir sudėtinga kalbėti apie praeitį, kuria nesididžiuojame.
Humoras turėtų vienyti
Kita problema – ar tikrai galima griežtai diferencijuoti tikslines auditorijas. Šiais globalizacijos laikais ribos tarp užsienio ir vietinių grupių yra gerokai nusitrynusios. Tiesa, užsienio rinka gal ir turi savo specifiką, tačiau ir vietiniai žmonės gali laisvai judėti, bendrauti, dirbti tarptautinėse kompanijose. Dalis Vokietijos ar Jungtinės Karalystės gyventojų – imigrantai iš tos pačios Rytų Europos. Arba – ką apie reklamą mano Vokietijos ginkluotųjų pajėgų brigada?
Socialiniai tinklai niveliuoja visas šias grupes. Tačiau svarbu, kaip Vilnius
matomas platesniame kontekste. Tokį turinį paprastai išvystame socialiniuose tinkluose, o jų vartotojai dažniausiai dėmesį išlaiko labai trumpai. Kyla klausimas: kas iš vartotojų apskritai pažiūrėjo visą vaizdo klipą, kad pamatytų pozityvią jo pabaigą ir suprastų pagrindinę kampanijos idėją – mitų apie Rytų Europą paneigimą?
Galiausiai – ar vilniečiai labai norės dalintis šia reklama su savo draugais užsienyje? Ar vykstant į oficialius renginius užsienyje norėsis šį turinį rodyti kaip reprezentuojantį mūsų sostinę? Miestas – didžiulė bendruomenė, joje yra gausu vadinamųjų suinteresuotųjų šalių ir tos suinteresuotosios šalys daug ką mato šiek tiek skirtingai. Humoras turėtų tapti šias grupes vienijančiu veiksniu.
Reikalinga ilgalaikė strategija
Retrospektyviai žiūrint į Vilniaus įvaizdžio kūrimą, matyti, kad kampanijų koncepcijos buvo labai skirtingos –
Kol kas Vilnius buvo tarytum neapsisprendęs: kasdien atsidaręs drabužių spintą galvodavo, koks gi jis galėtų būti šiandien.
ir „Vilnius kaip G taškas“, ir „Nuostabus, kad ir kur būtum“, ir „Vilnius: 700 metų jaunas“, ir „Nereikia naviguoti Vilniuje“, ir „Vilnius: netikėtai nuostabus“, ir t. t. Visas kampanijas vienijo humoras, bet apskritai aiškiõs ir nuoseklios strategijos, koks tas miesto identitetas, kurį parduodame, trūko. Gana fragmentiškai kalbėjome apie 700 metų sulaukusį miestą, kuris vakar buvo vienoks, šiandien – kitoks, o ryt – dar kitoks. Galiausiai – visoks, o tai vargu ar užsiliks tikslinių auditorijų atmintyje.
Teoriniu požiūriu miesto rinkodaros strategija turėtų būti kuriama pirmiausia atsižvelgiant į miesto vertybes ir kampanijos tikslus, paskui įvardijant tikslines grupes ir strategiją: ar su visomis grupėmis bus kalbama vienu balsu, ar strategija bus diferencijuota. Todėl miestas gali būti visoks – tai diferencijuotos strategijos padarinys. Paprastai tokiu atveju sukuriama viena ar kelios įvaizdinės ir kelios rėmimo kampanijos. Pastarosios pasiteisina tada, kai didelė grupė reaguoja į rinkodaros veiksmus.
Miesto – ne produkto, ne komercijos – atveju geriausia įvaizdžio kūrimą
palikti BTL rinkodarai (angl. below the line – pardavimų skatinimo priemonių grupė: veiksmai pardavimo vietoje, nematomi veiksmai, į konkrečias auditorijas nukreipti veiksmai) socialiniuose tinkluose. Tai dažnai daroma dirbant su skirtingomis auditorijomis, kad bendras įvaizdis nesifragmentuotų, tačiau turint nuoseklią strategiją.
Kol kas Vilnius buvo tarytum neapsisprendęs: kasdien atsidaręs drabužių spintą galvodavo, koks gi jis galėtų būti šiandien. Iš dalies tai yra susiję su cikliškumu – periodiškai renkama savivaldybe ir miesto taryba, kurią po penkerių metų keičia kiti. Tačiau sėkmingi užsienio pavyzdžiai rodo, kad reikėtų nuosekliau plėtoti tą pačią komunikacinę liniją.
Vilniaus pozicionavimo užduotis
Grįžtame prie klasikinio klausimo: koks Vilnius turi būti kaip žmogus, kad atitiktų įvairių grupių lūkesčius? Taigi pagrindinis miesto namų darbas – pozicionavimas. O pasiūlyti sostinė tikrai turi ką. Tai – ir baroko architektūros, ir šiuolaikinės gastronomijos miestas. Žinoma, šiuos priva-
lumus pabrėžia ir kiti, gerokai didesni bei turtingesni, miestai, su kuriais konkuruoti sunku.
Tačiau yra ir mažiau išnaudotų požiūrio kampų. Pirma, tai Vilniaus kinematografinis potencialas. Lietuvos sostinėje vyksta ypač daug filmavimų, kurių metu ji gali tapti ir Viena, ir Roma, ir Oslu, Čikaga ar distopine vieta. Antra, Vilnius vis dar yra žalioji sostinė, kur sunku suprasti, ar gamta terpiasi į miestą, ar architektūra papildo miesto žaliąsias zonas.
Galiausiai visa tai turi būti vientisas pasakojimas apie miestą, įtraukiantis ir vienijantis įvairias suinteresuotas grupes ir net skirtingų politinių pažiūrų žmones. Ši Vilniaus legenda turėtų nesutrūkinėti keičiantis valdžiai, kuri savo ruožtu galėtų emocijas versti realiais infrastruktūriniais sprendimais, kad mieste būtų gera visiems. Pasakojimas apie miestą turėtų būti kaip tarpusavio supratimo tiltas, skatinantis dialogą ir bendradarbiavimą siekiant bendro tikslo – padaryti Vilnių dar gražesnį ir patrauklesnį visiems jo gyventojams ir svečiams.

Gretė Gerulaitytė
Vilniaus universitetas
Dar neseniai Lietuvos dangų papuošusi Šiaurės pašvaistė paskatino
šalies gyventojus ne tik fiksuoti retus reiškinius mūsų platumose, bet ir diskutuoti, ar tai globalinio atšilimo, o gal kitų veiksnių rezultatas. Vilniaus universiteto Fizikos fakulteto mokslininkas dr. Kęstutis Ikamas patikina, kad šiuos reiškinius sukelia Saulės audros, o Šiaurės pašvaistė – bene vienintelis pozityvus jų padarinys. Sulaukę Saulės audrų aktyvumo piko galime tikėtis kur kas liūdnesnių pasekmių – nuo stringančių telekomunikacijų, sutrikusio palydovų ir interneto ryšio iki mėnesiams dingusios elektros.

Gyvename Saulės audrų piko laikotarpiu
Pasak fiziko dr. K. Ikamo, Saulės audros yra įprastas reiškinys ir vyksta nuolat. Audros metu iš Saulės į erdvę dideliu greičiu išmetamos didelės energijos dalelės (plazma). Kai tų dalelių debesis nuskrieja iki Žemės, jas sustabdo viršutiniai atmosferos sluoksniai ir mūsų planetos paviršiaus jos nepasiekia, bet tuo metu danguje matome Šiaurės pašvaistę. Tačiau jei Saulės audra būna labai stipri, jos poveikis Žemei gali būti didesnis.
„Saulės plazmos srautas paveikia Žemės magnetinį lauką ir jis pakinta. Atsiranda neįprastų magnetinio lauko trikdžių, kuriuos vadiname geomagnetine audra. Kadangi Saulė, kaip ir Žemė, turi sau būdingus gyvavimo ciklus, galima sakyti, sezonus, tam tikru metu yra fiksuojamas audrų suaktyvėjimas“, – sako dr. K. Ikamas.
Saulės aktyvumo cikle, vidutiniškai trunkančiame 11,2 metų, maksimalaus aktyvumo laikotarpiu galima tikėtis intensyviausių audrų ar net superaudrų. Mokslininkų skaičiavimu,
būtent 2023–2025-ieji turėtų būti
Saulės audrų piko sezonas. Vieną tokių intensyvesnių audrų matėme 2024 m. gegužės mėnesį, kai Lietuvoje stebėjome Šiaurės pašvaistę. Pasak Vilniaus universiteto mokslininko, tai bene vienintelis pozityvus Saulės audros padarinys be liūdnesnių pasekmių, kokių yra pasitaikę dar 2022 m.
„Dėl tuo metu kilusios audros net 40 iš 49 „SpaceX“ programos palydovų nepasiekė numatytos orbitos ir nukrito arba sudegė atmosferoje. Tai Elonui Muskui kainavo nuo 50 iki 100 mln. dolerių. Dar anksčiau vykusios Saulės audros, pavyzdžiui, 2015-aisiais, sukėlė nesklandumų telekomunikacijos tinklams Norvegijoje. Tačiau stipriausia užfiksuota Saulės audra įvyko 1859 m. Jei tokia kiltų šiandien, padariniai galėtų būti tragiški“, – sako mokslininkas.
1859 m. geomagnetinė audra, vadinama Karingtono įvykiu, sutrikdė telegrafo ryšį JAV ir dalyje Europos. Užfiksuota, kad telegrafo linijomis elektra tekėjo be jokio elektros šaltinio, kai kurie telegrafo aparatai užsi-
degė, o kai kurie leido operatoriams siųsti žinutes be išorinių maitinimo šaltinių. Vis dėlto, pasak dr. K. Ikamo, kadangi tuo metu telekomunikacijos dar nebuvo tokios išvystytos, kaip yra dabar, tai ir atkūrimo darbai nebuvo tokie sudėtingi.
Superaudra galėtų sukelti humanitarinę krizę
Mokslininkas atkreipia dėmesį, kad dabartiniame pasaulyje dauguma mums įprastų kasdienių procesų, tokių kaip vandentiekio, šildymo sistemų, degalų įpylimo kolonėlių veikla, yra automatizuoti ir priklausomi nuo elektros energijos bei telekomunikacijų.
Būtent dėl sudėtingesnės komunikacijų infrastruktūros dabar kilusi stipri geomagnetinė audra turėtų rimtesnių padarinių.
„Didžiausią geomagnetinės audros žalą patirtų elektros ir telekomunikacijų perdavimu besirūpinančios įmonės, centrai. Šios audros veikia infrastruktūrų branduolį, gali sugadinti elektros perdavimo įrangą, paveikti transformatorius – jų viduje esančios


dalys gali tiesiog sudegti, išsilydyti. Nors eilinis gyventojas didesnės audros atveju patirtų nebent menkus elektroninės įrangos sutrikimus, superaudros padarinius pajustų ne tiesiogiai, bet dėl dingusios elektros ar interneto ryšio“, –pasakoja fizikas.
Kad įvyko itin stipri geomagnetinė audra, galinti pažeisti mūsų naudojamas elektros sistemas, pirmiausia pastebėtume dėl dingusio mobiliojo ryšio. Dingtų ir internetas, neveiktų televizija ir elektroniniai mokėjimai, nebūtų šviesos. Kokio masto ši problema būtų, priklausytų nuo audros paveikto regiono dydžio – jei jis itin didelis, pavyzdžiui, visas Europos žemynas, elektros tiekimo atnaujinimas galėtų užtrukti ir iki keleto mėnesių. Visą šį laiką tektų praleisti be elektros ir ja valdomų sistemų bei prietaisų.
„Ilgesniam laikui dingus elektrai imtų streikuoti vandentiekis, būtų sudėtinga įsipilti degalų, nes jų įpylimo kolonėlių veikla yra automatizuota ir priklauso nuo elektros. Ypač problemiška būtų žiemą, nes sutriktų ir šildymo infrastruktūra. Savotiškos karo sąlygos, apie kurias dabar galėtų papasakoti Ukrainos gyventojai, dažnai patiriantys sunkumų, kai raketos pataiko į generatorius, transformatorines. Tad audrai paveikus mažą regioną keletą dienų be elektros ištvertume nesunkiai, tačiau keli mėnesiai be elektros galėtų sukelti net humanitarinę krizę“, – aiškina dr. K. Ikamas.
Vis dėlto dažniau pasitaikančios silpnesnės geomagnetinės audros tokio pavojaus nekelia.
Mokslininkų skaičiavimu, būtent 2023–2025-ieji turėtų būti Saulės audrų piko sezonas.
Stipresnės Saulės audros gali paveikti ir palydovus. Trikdžiai palydovų tinkluose savo ruožtu gali paveikti televizijos, mobiliojo ryšio, interneto tiekimą. Superaudrų atveju gali sutrikti ir plačiai naudojamos padėties nustatymo sistemos – GPS, „Gallileo“, tad atsirastų nesklandumų laivyboje, net karyboje, kur GPS naudojama raketoms valdyti. Kiltų problemų aviacijoje, pilotams tektų išjungti automatinį valdymą, nes sistemos neberodytų patikimos skrydžio trajektorijos.
Kai kurie mokslininkai tiki, kad geomagnetinės audros poveikį pajausti gali ir gyvūnai – paukščiai, delfinai reaguoja į pakitusį geomagnetinį lauką dėl jų kūnuose esančių paramagnetinių dalelių, vadinamų „vidiniu kompasu“, o tai gali turėti įtakos jų migracijai. Tokioms audroms

daug jautresni šiauriniai regionai, nes ten didesnė antrinės radiacijos ir jos sukeltų mutacijų rizika, tačiau labiausiai nukentėtų kosmoso stotyse reziduojantys astronautai, kurių nuo spinduliuotės nesaugo Žemės atmosfera ir magnetinis laukas.
Pasiruošti superaudrai turėsime tik keliolika valandų
Pasak dr. K. Ikamo, nors ir palydovai, ir telekomunikacijų, elektros perdavimo technika gaminama taip, kad apsaugotų nuo tokių nelaimių, itin stiprių geomagnetinių audrų atveju dabartinės apsaugos nepakanka, nes tai ir didelė investicija, ir mažai tikėtinas įvykis: „Statistiškai 4 audros per 11 metų yra normalus reiškinys, o kartą per šimtmetį galima tikėtis itin stiprios audros. Tokia jau buvo seniai – 1859 m., bet pasikliauti šia statistika sunku, nes Saulė dar nėra iki galo ištyrinėta, mažai apie ją žinome.
Tačiau papildomos investicijos į apsaugą nuo itin stiprios geomagnetinės audros yra labai didelės. Pavyzdžiui, „SpaceX“ kompanijai reikėtų iškelti palydovus į aukštesnę pradinę orbitą, kas kainuotų ir daugiau laiko, ir
papildomų išlaidų, dėl to vieno palydovo sąnaudos išaugtų 10–15 proc. Be to, sulėtėtų palydovų tinklo kūrimo tempas. Todėl dėmesys sutelkiamas į vidutiniškai stiprią apsaugą, nes tai labiau apsimoka.“
Labai galingos audros poveikio elektros tiekimo infrastruktūrai mastas priklauso nuo daugelio veiksnių. Vienas iš jų – šalies turimų perdavimo linijų ilgis. Pasak mokslininko, kuo ilgesni elektros laidai, tuo tokią sistemą stipriau gali paveikti geomagnetinė audra. Dėl šios priežasties didesnis pavojus gresia tokioms šalims kaip JAV, Kanada, Rusija. Vakarų Europos šalys yra mažesnės, tad jų elektros tinklus Saulės audros veikia silpniau. Kitas veiksnys – laikas, per kurį sureaguojama į artėjančią audrą. Blogiausiu atveju iki itin stiprios audros pradžios turėsime keliolika valandų pasiruošti ir imtis bent minimalių prevencinių priemonių.
„Saulę stebinčiose kosminėse stotyse esančiai įrangai užfiksavus Saulės audrą, kuri turi potencialo paveikti Žemę ir virsti itin stipria geomagnetine audra, apie tai būtų pranešta likus 19–72 val. iki jos pradžios mūsų plane -
Stipriausia
užfiksuota Saulės audra įvyko 1859 m. Jei tokia kiltų šiandien, padariniai galėtų būti tragiški.

toje. Valstybių valdymo institucijos ir didžiosios įmonės atitinkamu lygmeniu turėtų turėti specialų planą tokiems atvejams. Klausimas, ar turi. Iš esmės svarbiausia užduotis būtų kelioms paroms išjungti didelius ir svarbius infrastruktūrinius įrenginius. Nors tai skamba kaip paprasta užduotis, faktiškai yra sudėtinga“, –teigia dr. K. Ikamas.
Taip yra todėl, kad dauguma sistemų, pavyzdžiui, hidroelektrinės, šiluminės elektrinės ar elektros perdavimo tinklai, yra inertiškos, jas sunku be rimtesnių padarinių staigiai išjungti, kaip ir įjungti. Geomagnetinei audrai paveikus sistemų transformatorius ir nutrūkus elektros tiekimui, atkūrimo darbai taip pat būtų labai sudėtingi, nes sugadintoms brangioms ir techniškai sudėtingoms detalėms pagaminti taip pat reikėtų elektros energijos, kurios tuo metu gali ir nebūti.
„Nors Norvegijos mokslininkai jau teigia, kad turėtume daugiau investuoti ir geriau pasiruošti apsisaugoti nuo stiprių geomagnetinių audrų, dėl tokių įvykių retumo ir milžiniškų investicijų ruoštis neskubama. Pavyzdžiui, 2012 m. stiprios audros pavyko išvengti, nes fiziškai buvome ne poveikio zonoje – Saulės audros metu išmestas plazmos srautas gali pasiekti Žemę tik tada, kada mūsų planeta atsiduria dalelių skriejimo trajektorijoje. Bet jei superaudra būtų pasiekusi Žemę ir poveikio zonoje buvusią JAV, nuostolių valstijoms, kai kuriais skaičiavimais, būtų buvę padaryta už trilijonus dolerių. Tenka pripažinti, kad apsisaugoti nuo Saulės audrų kol kas esame per mažai pasiruošę. Nors gyventojams tiesiogiai šios audros nėra pavojingos nei fiziškai, nei sveikatos atžvilgiu, bet asmeninė telekomunikacijų ir elektros įranga nuo jų gali nukentėti. Todėl kiekvienas iš mūsų, pamatęs pranešimą apie galimą stiprią elektromagnetinę audrą, turėtume pasirūpinti savo įrenginiais – išjungti juos ir fiziškai atjungti nuo elektros tinklo“, – sako Fizikos fakulteto mokslininkas dr. K. Ikamas.
RETŲ ŽODŽIŲ SIGNALAI
Agnė Navickaitė-Klišauskienė Prof. Jurgis Pakerys
Vilniaus universiteto Filologijos fakultetas
Žodžių dažnis kalboje nevienodas – vienus ištariame ir išgirstame daugybę kartų per dieną, o kitų mums gali neprireikti ir visą gyvenimą. Patys dažniausi žodžiai yra abstraktūs ir trumpi – tai įvairūs įvardžiai, jungtukai, prielinksniai, pavyzdžiui: ji(s), ta(s), ši(s), ir, kad, į, iš ir pan. Tai suprantama – tokių žodžių reikia nuolat, jie net tame pačiame sakinyje gali pasikartoti.
Bet ką galėtume pasakyti apie labai retus lietuvių kalbos žodžius? Pirma – kad jų, kaip ir kitose kalbose, yra labai daug, jų sąrašas net į visą žurnalą netilptų.
Antra – kad reti žodžiai gali nemažai pasakyti apie tai, kokie procesai vyksta mūsų kalboje, pavyzdžiui, kaip pasidarome naujus žodžius.


Kur galima rasti rečiausius žodžius?
Pirminė aplinka, kurioje gyvena žodis, yra tekstas – nesvarbu, ar rašytinis, ar sakytinis, todėl mokslininkai kuria dideles elektroninių tekstų sankaupas – tekstynus (korpusus, angl. corpus). Į juos dedami tekstai yra patys įvairiausi – nuo sausų administracinių dokumentų iki labai gyvų internetinių komentarų. Kuo daugiau ir kuo įvairesnių tekstų sukaupsime, tuo geriau galėsime įvertinti, kiek ir kokių žodžių lietuvių kalboje yra, kas ir kokiose situacijose juos ištaria ar parašo. Kartu išsiaiškinsime, kokie žodžiai dažniausi, o kokie – rečiausi. Be to, tekstų sankaupos naudingos ir tuo, kad jas galima panaudoti kuriant automatinio vertimo įrankius ir didelius kalbos modelius (angl. large language model, LLM), kurių pagrindu veikia „ChatGPT“ ir kitos panašios dirbtinio intelekto sistemos.
Tekstyno dydį nusako jame esančių žodžių formų skaičius, kurį turime skirti nuo pačių žodžių (kaip žodyno vienetų) skaičiaus. Pavyzdžiui, noriu, norėjau, spurgos, spurgų yra žodžių norėti ir spurga gramatinės formos, todėl čia matome keturias formas ir du savarankiškus žodžius – žodyno vienetus, kuriems tos formos priklauso. Virginijaus Dadurkevičiaus pareng -
tuose Jungtinio lietuvių kalbos tekstyno žodžių ir jų formų sąrašuose yra maždaug 1,3 milijardo formų – tai šiuo metu didžiausia laisvai prieinama tokių duomenų sankaupa. Iš tų formų yra pavykę atpažinti maždaug 190 tūkstančių skirtingų žodžių, įskaitant ir tikrinius. Sakome „yra pavykę atpažinti“, nes tai nėra tokia jau paprasta užduotis – lygiai kaip žmogus ne visus žodžius bus girdėjęs ir supras, taip ir kompiuterinės programos ne visus juos geba atpažinti.
Šiuo metu lietuvių ir kitų kalbų tyrėjai dirba dviem kryptimis: stengiasi plėsti tekstynus, kad jie kuo geriau atspindėtų įvairių sričių kalbą, ir tobulina žodžių atpažinimo programas, kad jos pateiktų kuo išsamesnius žodžių sąrašus. Kuo geresnius tekstynus turėsime ir kuo tobuliau veiks žodžių atpažinimas, tuo tiksliau galėsime atsakyti į klausimą, kiek ir kokių žodžių dalyvauja lietuvių kalbos informacinėje apyvartoje.
Kaip atrodo priesagų varžybos?
Mes, šio teksto autoriai, bendradarbiaudami su Vytauto Didžiojo universiteto tyrėju V. Dadurkevičiumi, dabar analizuojame jau minėto Jungtinio lietuvių kalbos tekstyno duomenis. Vienas iš tyrimo aspektų – labai
Tekstų sankaupos naudingos ir tuo, kad jas galima panaudoti kuriant automatinio vertimo įrankius ir didelius kalbos modelius.
reti žodžiai, tekstyne aptinkami tik vieną kartą, dar vadinami hapaksais (senąja graikų kalba hapax legomenon reiškia ‘(tai, kas) vienąsyk pasakoma’). XX a. pabaigoje atliktuose inovatyviuose Haraldo Baayeno darbuose teigiama, kad atsižvelgiant į hapaksus galima įvertinti, kókios naujų žodžių sudarymo priemonės kalboje yra pačios aktyviausios. Tyrėjas atkreipė dėmesį į tai, kad pakankamai dideliuose tekstynuose reikšminga hapaksų dalis yra naujai pasidaryti žodžiai. Pavyzdžiui, jei rasime daug labai retų žodžių su ta pačia priesaga, tai bus signalas, kad ta priesaga laikytina produktyvia, nes ją žmonės dažnai pasitelkia kurdami naujus žodžius. Tačiau, kaip nurodo H. Baayenas ir kiti tyrėjai, visų hapaksų su naujais žodžiais jokiu būdu negalima tapatinti – tekstyne labai reti bus ir senstantys arba šiaip retai pasitaikantys žodžiai.
Kad suprastume, kaip veikia hapaksų signalas, panagrinėkime keletą pavyzdžių. Palyginti neseniai lietuvių kalboje atsirado skolinys kaituoti – ‘judėti vandens (ar kitu) paviršiumi naudo-
jantis jėgos aitvaru – kaitu’. Kai tik šis veiksmažodis atėjo į mūsų gyvenimą, netrukus prireikė pasidaryti žodžius, kurie įvardytų atitinkamą veiksmą ir jį atliekantį asmenį. Tam reikalui veiksmažodis buvo konvertuotas į daiktavardžius: kaitav-im-as ir kaituotoj-as, kaituo-toj-a. Sudarydami šiuos žodžius, žmonės pasitelkė modifikatorius – priesagas -im-as ir -toj-as, -a. Šiems modifikatoriams išsiaiškinti specialiai pasirinkome naują veiksmažodį – iš jo padarytų daiktavardžių lietuvių kalboje anksčiau nebuvo, todėl žmonės savo kalbinėje sąmonėje turėjo aktyvinti tam tikras priesagas, tikėtina, produktyvias – tokias, su kuriomis sudaromi nauji žodžiai. Dabar pažiūrėkime, ką apie šias priesagas sako jų hapaksų signalas, ir palyginkime su kitomis tą pačią funkciją atliekančiomis priesagomis (1 pav.).
Minėtosios priesagos – -im-as ir -tojas, -a – mūsų tekstyne turi daugiausia hapaksų ir akivaizdžiai lenkia artimiausias konkurentes – veiksmų priesagą -ym-as ir veikėjų priesagas -ėj-as, -a ir -ik-as, -ė. Hapaksų skaičiai šiuo atveju ne tik patvirtina mūsų

lingvistinę intuiciją ir gramatikų teiginius, kad tos priesagos produktyvios, bet ir – o tai labai svarbu – leidžia produktyvumą įvertinti kiekybiškai –kiek vienos priesagos produktyvesnės už kitas.
Kad įsitikintume hapaksų ypatingumu, pasižiūrėkime į keletą pavyzdžių iš tekstyno: [Valdovų rūmų] atstatymo sustabdymai ir vėl atstabd-ym-ai ; naujų indėlių nebedraud-im-as visai tikėtinas; inteligentiški zuokiniai besisavin-toj-ai susidūrė su tiesmukišku viktoro jamimu; Šie smulkūs atsivež-ėj-ai tikrai negali paveikti monopolisto; tiems buduliniams [kandidatūrų] atsiėm-ik-ams reikia uždrausti dalyvavimą rinkimuose. Visais atvejais matyti, kad žmogui reikėjo tam tikroje situacijoje šalia veiksmažodžio susikurti daiktavardį, kurio kalboje dar nebuvo, o tam buvo pasitelktos produktyvios žodžių sudarymo priemonės – mūsų ką tik minėtos priesagos.
Neplanuoti atradimai
Nagrinėdami hapaksus ir kitus retus žodžius galime ne tik gauti produktyvumo signalų, bet ir patvirtinti
retas kalbinių elementų kombinacijas. Pavyzdžiui, norėdami pasakyti, kad veiksmas tam tikru aspektu ribotas, prie veiksmažodžio lietuvių kalboje galime pridėti priešdėlį te-. Štai pora iliustracijų iš mūsų tekstyno: Vyrai mažai te-sirūpina sveikata; Va, opozicija tik savimi te-sirūpina. Bet pasvarstykime: ar priešdėlį te- galėtume rasti ir veiksmo pavadinime su priesaga -im-as?
Tokia tikimybė yra, nes gerai žinoma, kad produktyvūs veiksmų pavadinimai įvairiose kalbose savo struktūra ir funkcijomis priartėja prie veiksmažodžio formų, todėl nemaža dalis veiksmažodžio elementų (mūsų atveju –priešdėlis te-) galėtų pereiti ir į veiksmo pavadinimus. Šiuo atveju matome, kad lingvistikoje, panašiai kaip ir kituose moksluose, tam tikrus elementus ir jų kombinacijas galime nuspėti teoriškai, bet norėdami tą spėjimą patvirtinti turime remtis didelės apimties tekstynais arba kitais duomenų šaltiniais, pavyzdžiui, psicholingvistiniais eksperimentais.
Mūsų tyrimo atveju, tiesa, išankstinio spėjimo net nebuvo – tiesiog stengėmės surinkti kuo daugiau duomenų ir – vėlgi panašiai, kaip ir kitiems mokslininkams nutinka – atsi-
Jei rasime daug labai retų žodžių su ta pačia priesaga, tai bus signalas, kad ta priesaga laikytina produktyvia.
tiktinai radome minėtą kombinaciją patvirtinančios medžiagos – tris veiksmų pavadinimus su priešdėliu te-: tesirūpinimas, tepripažinimas, tesurinkimas. Paskutiniai du žodžiai yra hapaksai, o pirmojo daiktavardžio vartosenos pavyzdys į tekstyną pateko du kartus, štai jo fragmentas: protestas buvo prieš dabartinės valdžios politiką aplamai – didelę bedarbystę, pensijų mažinimus, aroganciją, tesirūpinimą tik biudžetininkų gerove.
Ar lengva pagauti retą žodį?
Kiek tekstyne rasime retų žodžių, priklauso nuo to, kaip sėkmingai juos atpažino specialios programos. Pirminį – visiškai žalią – tekstyną sudaro potencialios žodžių formos (raidžių sekos) ir įvairūs papildomi elementai – skaičiai, simbolių eilutės ir panašiai, todėl, norėdami gauti to tekstyno žodžių sąrašą (žodyną), turime jį specialiai paruošti. Tokius
sąrašus rengia kompiuterinės programos, sugebančios atpažinti, kokiam žodžiui priklauso tekstyne aptinkamos konkrečios gramatinės formos. Žodžių atpažinimas tekstyne vadinamas lemavimu, o jį atliekančios programos – lematizatoriais. Dažniausiai lematizatoriai gerai atpažįsta dažnesnius žodžius, o retesnieji gali būti netinkamai interpretuoti arba visai neatpažinti. Todėl tokiems tyrimams, kuriuos dabar atliekame, labai svarbi atviroji prieiga: turi būti pasiekiami ir tekstyno formų, ir lemų (atpažintų žodžių) sąrašai, taip pat turi būti kuo išsamiau aprašytas lematizatorius. Tik tada galėsime suprasti, kiek sėkmingas buvo tekstyno lemavimas, ir nuspręsti, kokius darbus reikia atlikti papildomai, kad retų žodžių signalas būtų kuo patikimesnis.
Pavyzdžiui, mūsų atveju pirminis automatinis lemavimas atpažino 583 potencialius hapaksus
su priesaga -im-as ir tik 22 hapaksus su priesagomis -toj-as, -toj-a .
Nujautėme, kad dideliam tekstynui šie skaičiai gerokai per maži, todėl atlikome papildomą pusiau rankinį lemavimą – automatiškai atrinkome visas mus dominančių galimų žodžių formas, jas jungėme į lemas, o vėliau patikrinome rankiniu būdu – atmetėme programos padarytas klaidas. Po papildomo lemavimo hapaksų skaičiai reikšmingai išaugo: priesagą -im-as turėjo jau 2855 hapaksai, o priesagas -toj-as ir -toj-a – iš viso 646 hapaksai.
Tikimės, kad artimiausiu metu savo darbus galėsime pratęsti ir pradėsime tirti būdvardinius hapaksus, o vėliau imsimės ir veiksmažodžių. Kartu stebėsime, kaip plėtojami lietuvių kalbos tekstynai ir lematizatoriai – kuo jie bus geresni, tuo daugiau galėsime pasakyti apie dabartinę lietuvių kalbos struktūrą ir jos artimiausią ateitį.

Dr. Dovilė Balevičienė
Vilniaus universiteto Kauno fakultetas
„Noriu, kad dirbtinis intelektas man plautų drabužius ir indus tam, kad galėčiau užsiimti menu ir rašymu, o ne kad kurtų už mane meną ir rašytų, o aš plaučiau drabužius ir indus“, – šių metų kovą socialiniame tinkle „X“ parašė lenkų rašytoja Joanna Maciejewska.
Vieni menininkai siekia dirbtinį intelektą (DI) paversti įrankiu, padedančiu sustiprinti jų kūrybiškumą, atrasti naujas meno formas ir idėjas, kiti naudoja kaip kūrybinio sumanymo vykdytoją, o treti pasitelkia kaip kūrybinį partnerį.
Tačiau tyrimai ir eksperimentai rodo, kad DI sugeneruoti kūriniai meno auditorijos laikomi mažiau vertingais nei sukurti žmonių, o robotai, patekę į muziejus ir galerijas, kelia neigiamas lankytojų reakcijas.

DI kuria pagal nustatytas taisykles
Dirbtinio intelekto terminas pirmą kartą buvo pavartotas 1956 m. Dartmuto koledže surengtoje konferencijoje. Į ją susirinkę mokslininkai aptarė galimybę sukurti mašinas, galinčias spręsti problemas, kurias tuo metu sprendė tik žmonės. DI yra mašinų gebėjimas imituoti žmogaus intelektą ir atlikti užduotis, reikalaujančias žmogaus intelektinių gebėjimų: problemų sprendimo, mokymosi, argumentavimo, suvokimo, kalbos atpažinimo, kalbos vertimo ir sprendimų priėmimo.
Šiuo metu yra dvi pagrindinės DI rūšys: silpnas ir stiprus. Silpnas DI sukurtas konkrečioms užduotims spręsti ir gali atlikti tik tas funkcijas, kurias atlikti yra apmokytas. Jame nesama žmonėms būdingo mąstymo principo. O stiprus DI gali suprasti, mokytis ir taikyti žinias įvairioms užduotims spręsti į žmogaus intelektą panašiu algoritmo taikymo būdu. Šiuo metu realių stipraus DI pavyzdžių nėra, jie aptinkami tik mokslinės fantastikos kūriniuose, tokiuose kaip „Her“, „Star Trek: The Next Generation“ ir „Wall-E“.
Tad ir kūrybinėse industrijose naudojamas DI yra laikomas silpnu, nes veikia pagal pateiktus duomenis ir kuria tik pagal nustatytas taisykles. Pavyzdžiui, algoritmas, skirtas tapybai, gali tik tapyti – jis negali kurti skulptūros ar muzikos.
Tačiau net ir silpnas DI daro didelę įtaką kūrybinėms industrijoms, kūrybiniam procesui ir meninei raiškai. Šiuo metu DI, kuriam pateikiami analizuoti dideli muzikos duomenų rinkiniai, naudojamas komponuoti muzikai, taip pat esama DI modelių, galinčių rašyti poeziją ir romanus. Menininkai pasitelkdami DI kuria interaktyvias, žiūrovus įtraukiančias instaliacijas, kurios reaguoja į auditorijos judesius, emocijas ar aplinkos pokyčius. DI algoritmai naudojami papildytosios realybės (AR) ir virtualiosios realybės (VR) programose, kuriant įtraukiąsias menines patirtis, pavyzdžiui, virtualiose meno galerijose.
Šiuo metu tiek menininkams, tiek plačiajai visuomenei yra prieinamos programos, kurios generuoja vaizdus („Midjourney“, „DALL-E“, „StarryAI“, „Gemini“, „Deep Dream Gene-

Algoritmas, skirtas tapybai, gali tik tapyti – jis negali kurti skulptūros ar muzikos.
DI kūrybinėse industrijose naudojamas dvejopai: kaip papildantis ir kaip pakeičiantis kūrėjo darbą.
rator“, „Runway M“, „Imagine AI Art Generator“ ir kt.), tekstus („ChatGPT“, „Google Bard“, „Jasper AI“, „RoBERTa“, „Rytr“, „T5“ ir kt.) ir muziką („Udio“, „Suno“, „Soundraw“, „Mubert“, „AVIVA“, „Jukedeck“ ir kt.).
DI praplės meninę raišką ar pakeis menininką?
DI kūrybinėse industrijose naudojamas dvejopai: kaip papildantis ir kaip pakeičiantis kūrėjo darbą. Pirmuoju atveju DI išplečia menininko galimybes, leidžia efektyviau įgyvendinti jo vizijas ir idėjas. Antruoju atveju DI visiškai pakeičia menininką: bet kuris žmogus gali pasitelkti algoritminę technologiją, kad ji kurtų vaizdus ar muziką pagal pateikiamus nurodymus. Tačiau žiūrovai teigiamai vertina tuos menininkus, kurie naudoja technologijas pirmuoju būdu – savo meninėms galimybėms papildyti ir išplėsti. Kūrybiniuose procesuose papildantysis DI gali padėti menininkams ieškoti įkvėpimo ir įgyvendinti kūrybinius sumanymus. Jis gali siūlyti idėjas kūriniams ar pateikti menininko darbą su įvairiais filtrais, atspindinčiais ankstesnių kūrėjų stilius. O pakeičiantysis DI gali kurti meninius kūrinius pagal
jį naudojančio kūrėjo mintis, pavyzdžiui, generuoti vaizdus pagal tekstą. Manasas Bhatia, Sofia Crespo, Scottas Eatonas, Georgia Perry, Jake'as Elwesas ir kiti menininkai pasitelkia DI kaip kūrybinį partnerį, kuris generuoja vaizdus pagal jų idėjas. Žmogaus kaip kūrėjo vaidmuo yra rasti naujų požiūrių ir įkvėpimą savo vizijoms.
Menininko ir DI bendradarbiavimo formos
DI gali būti pritaikytas kaip kūrybinio sumanymo vykdytojas (pvz., kurti dalį paveikslo) arba kaip bendrakūrėjis (pvz., reguliuoti vizualinius efektus spektaklio metu). Vokiečių menininko Mario Klingemanno instaliacijoje „Memories of Passerby“ DI nepaliaujamu srautu kuria neegzistuojančių žmonių portretus. Menininkas tris mėnesius treniravo neuroninį tinklą, kuris, remdamasis tūkstančiais XVII–XIX a. portretų, generuoja siurrealistinius vaizdus.
Lietuvoje naudojant DI atkurta opera „Andromeda“. Tarptautinė kūrėjų komanda (Mantautas Krukauskas, Māris Kupčs, Žilvinas Vingelis ir kt.), pasitelkusi DI modelį Martiną Malandro, pagal išlikusią Marco Scacchi ir jo


amžininkų kūrybą atkūrė operą, skambėjusią 1644 m. Vilniaus Žemutinėje pilyje. DI buvo panaudotas ir scenografijos vaizdo projekcijoms, kurias pagal ankstyvojo baroko paveikslus kūrė Rimas Sakalauskas.
Menininkė Sougwen Chung yra žinoma dėl robotikos ir DI integravimo į kūrybinį tapybos procesą, kurio metu ji bendradarbiauja su DI robotu. Per pastaruosius 20 metų savo pačios meno kūrinius Sougwen Chung panaudojo tam, kad apmokytų DI atpažinti ir imituoti jos stilių. Menininkė įtraukė neuroninį tinklą į savo kūrybos procesą kaip bendrakūrėjį – sukonstravo robotines rankas su dažais ir tapė kartu su juo.
Stephanie Dinkins interaktyvų kūrinį „Not The Only One“ („N'TOO“) galima laikyti nuolatiniu DI įtraukiančiu eksperimentu. Menininkė siekia sukurti DI pasakojamą knygą apie juodaodžių šeimos istoriją. Neuroniniam tinklui buvo pateikti žodiniai menininkės šeimos narių pasakojimai apie jų gyvenimą. „N'TOO“ bendrauja kaip unikalus personažas ir atsako į lankytojų klausimus remdamasis savo unikaliu požiūriu.
Galima paminėti ir interaktyvų spektaklį „I Am Echoborg“, kuriame aktorė Marie-Helene Boyd sąveikauja su auditorija kontroliuojama paslėp -
tos DI sistemos. Spektaklio scenarijų parašęs dramaturgas Rikas Landeris panaudojo „echoborgų“ konceptą, sukurtą socialinių psichologų Kevino Corti ir Alexo Gillespie. Kiekvienas pasirodymas yra skirtingas, o jo baigtis priklauso nuo aktorės ir auditorijos dialogo. Vis dėlto ši kūrybos forma dar nesulaukė visuotinio pripažinimo.
Dar 2018 m. Vilniaus universiteto Kauno fakulteto dėstytojas dr. Saulius Keturakis, pasivadinęs Tomu Maagi, naudodamas DI sugeneravo novelę. Skaitytojai tuomet nesuprato, kad neegzistuojančiam autoriui priskirti kūriniai yra parašyti ne žmogaus, o DI, ir tik 2020 m. vadovų konferencijoje „EBIT“ buvo atskleista tikroji autorystė. „Nėra pagrindo baimintis –dirbtinis intelektas nepakeis žmogaus kaip autoriaus, tik jo funkciją: užuot pradėjęs nuo tuščio popieriaus lapo, dabartinis autorius atrenka ir aprobuoja tai, ką jam pasiūlo dirbtinis intelektas, apibendrindamas apmokymui panaudotus duomenis“, – ramino dr. S. Keturakis.
Didžiausia problema – autorystės klausimas
Menininkai vis dar mokosi gyventi ir kurti naudodamiesi DI, todėl verta atkreipti dėmesį į keletą šiuo metu
kylančių iššūkių, susijusių su DI panaudojimu, jo galimu poveikiu žmogaus kūrybiškumui ir autonomiškumui, meninės vertės sukūrimui ir autorių teisėms.
Vienas iš didesnių iššūkių – šališkumas, kuris veda prie tam tikrų grupių ar rezultatų pirmenybės arba diskriminacijos. Šališkumas gali lemti iškreiptus ir etiškai abejotinus užduočių, reikalaujančių kūrybiškumo ir turinio kūrimo, rezultatus. Šališkumas gali būti reikšminga kliūtis menininkams, ieškantiems įkvėpimo, nes svarbi informacija, galinti praversti kaip kūrybinio proceso šaltinis, lieka užmiršta. Todėl gali susiformuoti „tunelio“ efektas, o menininkas gali įstrigti informacijos burbule, kuris riboja jo galimybes ir trukdo pasireikšti kūrybiniam potencialui.
Kitas iššūkis yra visuotinis nerimas dėl to, kad DI gali užgožti ar sumažinti žmogaus kūrybiškumą ir autonomiją meno kūrimo procese. Kai DI perima užduotis, tradiciškai atliekamas menininkų, kyla pavojus žmogiškajam kūrybiškumui nuslopti ir tapti nebevertinamam. Kūrėjai kelia klausimą apie emocinio ir asmeninio ryšio, būdingo žmogaus sukurtam menui, praradimą, kuris veda prie meno dehumanizavimo. Daugiausia diskusijų susilaukia autorystės klausimas. Įprastai autorystė
atpažinti ir imituoti jos stilių.
priklauso menininkui, kuris tiesiogiai dalyvauja kūrybiniame procese.
Tačiau DI sukurtų kūrinių atveju autorystės apibrėžimas tampa kur kas sudėtingesnis – kyla klausimas, kam priklauso autoriaus teisės: ar autorystė turėtų būti suteikta programai, algoritmui, duomenų rinkiniams, kurie įkvėpė ar padėjo sukurti kūrinį? Pavyzdžiui, jei algoritmas sukūrė paveikslą ar muzikinį kūrinį naudodamas duomenų rinkinį, sunku nustatyti, kam turėtų priklausyti kūrinio autorinės teises.
Apmokant DI modelius dažniausiai naudojami specifiniai duomenų rinkiniai, iš kurių algoritmas mokosi atpa-
žinti ir generuoti turinį. Pavyzdžiui, algoritmas gali būti mokomas atpažinti stilistines ypatybes, temines idėjas ar net konkretaus menininko kūrybinį stilių ir visa tai pritaikyti kuriant turinį. Tačiau iškyla klausimas: ar nepažeistos menininkų, kurių kūriniais buvo apmokomas DI, autorių teisės?
2023 m. Sarah Andersen, Kelly McKernan ir Karla Ortiz pateikė teisinį ieškinį prieš „Stability AI“, „Midjourney“ ir „DeviantArt“. Menininkų grupė teigė, kad šios įmonės be leidimo naudojo jų autorių teisių saugomus kūrinius DI modeliams apmokyti, taip pažeisdamos jų intelektinės nuosavybės teises.
Šiuo metu pasaulyje yra ir daugiau panašių teisminių procesų, tačiau dalis ieškinių buvo atmesti arba vis dar laukia nuosprendžio.
Susiduriama ir su iššūkiais dėl autorių teisių apsaugos principų taikymo DI, kuris tęsia ar atkuria žmogaus sukurtą turinį remdamasis knygos ar muzikos fragmentais. Pavyzdžiui, „The Next Rembrandt“ projekto metu DI buvo naudojamas naujam paveikslui, pagrįstam Rembrandto darbų analize, sukurti. Kilo daug diskusijų dėl šio projekto etiškumo, meninės vertės, požiūrio į kūrėjo darbą ir dėl to, kas turėtų būti laikomas jo autoriumi.

Doc. Algirdas Bartkus
Vilniaus universiteto
Ekonomikos ir verslo administravimo fakultetas
Pasitaiko, kad per rinkimus ar kitas politines batalijas šalies politikai, siekdami sukurti sėkmės ir užtikrintumo atmosferą, bando įvairiais būdais pagražinti esamą ekonominę padėtį – nutyli nesėkmes ar problemas ir pabrėžia proveržius bei pergales.
Dažnai apie tokias ekonomines pergales žino tik tariamas „nugalėtojas“, tad jos neminimos pasaulinėje žiniasklaidoje ir jų niekas neaptarinėja.
Viena tokių nesenų Lietuvos ekonominių pergalių, kuria gyrėsi kandidatai
į Europos Parlamentą, Prezidentus ir dalis žymių Lietuvos ekonomistų, buvo Sostinės regiono paskelbimas turtingiausiu Baltijos šalių regionu, pralenkusiu Europos Sąjungos (ES) vidurkį. Vieni gyrėsi, kad mūsų Sostinės regione bendrasis vidaus produktas (BVP), tenkantis vienam gyventojui, viršija ES vidurkį, o kiti – kad jis pralenkė Estijos Harju apskrities BVP, tenkantį vienam tos apskrities gyventojui. Šiame komentare bus nešališkai pažvelgta į šią ekonominę „pergalę“.

Sostinių regionų lyginimas nėra teisingas
Prieš imantis Lietuvos Sostinės regiono ir Estijos Harju apskrities palyginimo reikėtų suprasti, kad jie yra labai nevienodi. Lietuvos Sostinės regionas – tai ne Vilnius ir geriausios Vilniaus rajono zonos, tai yra Vilniaus apskritis, į kurią pakliūva ne tik geriausi Vilniaus miesto kvartalai, bet ir Taujėnai, kurie yra Ukmergės rajono pakraštyje. Harju apskritis, arba Harjuma (Harjumaa), yra viena iš penkiolikos Estiją sudarančių apskričių, kuri mūsų šalies mastu galėtų būti sulyginama su Vilniaus miesto, Vilniaus rajono, Trakų rajono ir Elektrėnų savivaldybėmis, tačiau jokiu būdu ne su visa Vilniaus apskritimi.
Tam, kad nelygintume itin apie centrą susikoncentravusio Estijos regiono su labai didele Lietuvos apskritimi, Vilniaus apskritį reikėtų lyginti su Šiaurės Estijos regionu, kurį sudaro ne tik Harjuma, bet ir Vakarų Viruma (Lääne-Virumaa) bei Rytų Viruma (Ida-Virumaa). Šiame regione, kuris nusidriekia per visą šiaurės Estiją, yra ne tik Talinas, bet ir Narva, Jehvis (Jõhvi), Rakverė ir Kohtla Jervė (Kohtla Järve). Taigi gana įvairiapusė Vilniaus apskritis, turinti per 800 tūkst. gyventojų, bus lyginama su Šiaurės Estijos regionu, turinčiu per 600 tūkst. gyventojų. Identiška parinktis iš Latvi-
jos būtų Rygos miestas, mūsų šiaurinių kaimynų išskirtas kaip atskiras administracinis-teritorinis vienetas, ir Parygės regionas, kurie kartu turi per 950 tūkst. gyventojų. Latvijos sostinės regionas yra kiek didokas, žinant, kad jam priskiriamos ir Tukumo bei Salacgryvos savivaldybės, tačiau toks yra jų administracinis suskirstymas ir agreguoti duomenys pateikiami būtent apie tokius administracinius vienetus. Atskirose šalyse egzistuojančių regioninių skirtumų ar regionų lyderystės neįmanoma traktuoti kaip vienareikšmiškai blogo ar gero reiškinio. Smarkiai iš kitų išsiskiriančio regiono buvimas signalizuoja apie netolygų sukurtos produkcijos, jos vertės ir pajamų pasiskirstymą šalyje. Toks regionas trauks darbo jėgą į save, jame esanti infrastruktūra nesuspės fiziškai patenkinti išaugusio vartotojų poreikio, o tai nulems daugybę socialinių regioninio lyderio problemų.
Siekdamos kaip galima tolygesnės ekonomikos plėtros geografiniu požiūriu, šalys imasi tikslingų skatinamųjų priemonių tam, kad itin stiprus augimas metropolijoje būtų perkeltas į periferiją. Naujas darbo vietas kuriant ne metropolijoje, o periferijoje, metropolijos augimas lėtėja, o periferijos spartėja. Šaliai visada svarbu, kad augtų bendra joje sukuriama vertė, o pats augimas teiktų kaip galima didesnę

tiesioginę ir netiesioginę naudą kaip galima didesniam šalies gyventojų skaičiui. Parankiausias ekonomikai variantas – tolygus visų šalies regionų augimas, kai tarp jų nėra per didelių skirtumų.
Itin didelis augimas metropolijoje ir menkesnis periferijoje nulemia pajamų atotrūkio tarp skirtingų regionų gilėjimą, finansines atskirų savivaldybių problemas, pernelyg didelę taršą metropolijoje ir visoje šalyje, transporto ir logistikos problemas, pernelyg spartų nekilnojamojo turto kainų augimą metropolijoje, turto nuvertėjimą periferijoje, viešų investicijų neatsipirkimą periferijoje, pernelyg aukštą jų kainą metropolijoje ir t. t. Siekiant kaip galima tolygesnės regionų raidos, dažnai stengiamasi naujas investicijas nukreipti į periferiją. Jeigu tokius sprendimus pavyksta įgyvendinti, metropolijos augimas pradeda lėtėti, o periferijos – spartėti, ir tai yra sėkmingai vykdomos regioninės politikos rezultatas. Norint tinkamai suvokti ir interpretuoti Baltijos šalių sostinių regionų ekonominio augimo rezultatus, būtina apžvelgti agreguotus, t. y. visos šalies būklę atspindinčius, Estijos, Lietuvos ir Latvijos ekonomikų augimo rodiklius.
Vilniaus apskrities BVP nesiekia ES vidurkio
Kartais dėl nežinojimo žmonės ekonomikos rezultatus yra linkę matuoti einamosiomis kainomis ir gauna iškreiptą situacijos vaizdą. Pagrindinė tokio matavimo problema yra ta, kad šie dydžiai neatspindi gyventojų perkamosios galios ir vartojimo galimybių. Einamosiomis kainomis išmatuoti dydžiai yra vadinami nominaliaisiais, o vieno pasirinkto laikotarpio kainomis išmatuoti dydžiai yra vadinami realiaisiais. Nominalusis BVP vienam ES gyventojui 2022 m. buvo 35,45 tūkst. eurų, o Vilniaus apskrities BVP vienam gyventojui buvo 35,3 tūkst. eurų, t. y. beveik sutapo su ES vidurkiu. Šis rodiklis, kuriuo labai didžiuojasi politikai ir ekspertai, sukuria klaidingą įspūdį, kad Vilniaus apskritis yra standartinio, „vidurkiui“ galinčio atstovauti
ES regiono pavyzdys. Klaida čia yra ta, kad lyginant naudojamas nominalusis, o ne realusis BVP. Perskaičiavus BVP palyginamosiomis 2010 m. kainomis, paaiškėja, kad realusis BVP vienam ES gyventojui 2022 m. buvo 28,94 tūkst. eurų, o realusis BVP vienam Vilniaus apskrities gyventojui – 22,39 tūkst. eurų, tad Vilniaus apskrities agreguotų pajamų lygis sudarė 77 proc. ES vidurkio. Matavimas nominaliaisiais dydžiais ignoruoja besikeičiančio kainų lygio poveikį perkamajai valiutos galiai skirtingose šalyse.
Žiūrint į nominaliuosius dydžius gali susidaryti įspūdis, kad Vilniaus apskritis yra standartinis, vidutinį lygį atspindintis ES regionas, tačiau, atsižvelgiant į tai, kad kainų augimo tempas Lietuvoje viršijo ES vidurkį, sukurta produkcija fizinėmis apimtimis sudaro 77 proc. ES vidurkio, tad Vilniaus apskritis iš tiesų yra žemiau vidutinio ES lygio esantis regionas. Naudoti nominaliuosius dydžius lyginant regionus yra ydinga, nes vienas
iš regionų gali turėti itin aukštą infliaciją ir jame perkamoji galia bus smarkiai erodavusi, o kitame infliacija gali būti labai nuosaiki ir tos pačios valiutos perkamoji galia ten bus aukšta.
Lietuva nuolat vijosi Estiją
Bet kuriais atskirais metais realusis BVP vienam gyventojui Estijoje buvo didesnis nei Lietuvoje ir Latvijoje, tačiau atotrūkis nebuvo visada vienodas. Nuo 1995 iki 2008 m., kai prasidėjo pasaulinė finansų krizė, atotrūkis tarp Estijos ir Lietuvos ar Latvijos BVP vienam gyventojui buvo gana pastovus (1 pav.). Prasidėjus finansų krizei situacija pasikeitė ir nuo to laiko Lietuvos BVP vienam gyventojui augo sparčiau nei tas pats Estijos rodiklis. Lietuva vis labiau tolo nuo Latvijos ir vis labiau artėjo link Estijos. 2021 m. pabaigoje, prasidėjus energijos išteklių krizei, Lietuvos ir Estijos ekonomikų augimas sustojo. 2021 m. realusis BVP vienam gyventojui Lietu-
voje ūgtelėjo 5,8 proc., Estijoje ir Latvijoje – atitinkamai 7,1 ir 7,8 proc., o 2022 m. Lietuvoje ūgtelėjo tik 1,5 proc., Estijoje smuko 0,6 proc. Latvijoje tais metais buvo fiksuotas 2,7 proc. augimas. 2023 m. Lietuvos ir Estijos realusis BVP vienam gyventojui smuko: Lietuvoje smukimas sudarė 1,7 proc., o Estijoje net 5,4 proc. Latvijoje šis rodiklis nepasikeitė. Dėl pasaulinės energijos išteklių krizės ir ilgai centrinių bankų vykdytos pigių pinigų politikos suintensyvėjusi infliacija Lietuvoje ir Latvijoje lėmė ekonomikos sąstingį, o Estijoje – nuosmukį.
Visiškai kitas dalykas yra tai, kad nuo 2011 m., kada pats sudėtingiausias finansų krizės etapas buvo įveiktas, iki 2019 m., t. y. iki COVID-19 pradžios, Lietuvos BVP vienam gyventojui augo vidutiniškai 5 proc. per metus, Latvijos – 4,1 proc., o Estijos – tik 3,8 proc. per metus. Baltijos šalių ekonomikos iki šiol taip ir nepasiekė ikikrizinių augimo tempų, o pokrizinis augimas Estijoje yra pats nuosaikiausias iš visų
2 pav. Realiojo BVP vienam gyventojui santykis su 12 pirmųjų euro zonos šalių vidurkiu (proc.)
Baltijos šalių. Šie pokrizinio augimo rodikliai yra gerokai mažesni už prieš finansų krizę fiksuotus augimo rodiklius. Nuo 2000 iki 2008 m. Estijos BVP vienam gyventojui augo vidutiniškai 6,8 proc., Lietuvos – 8,1 proc., o Latvijos – 8,3 proc. Tai, kad Lietuvos BVP vienam gyventojui artėja prie Estijos BVP vienam gyventojui, rodo, kad nors abi šios šalys patyrė didžiulių nuostolių dėl finansų krizės, Estijos nuostoliai buvo didesni nei Lietuvos.
Įstojusi į ES Lietuva sparčiau vijosi likusias šalis nei Estija
Tą patį patvirtina ir Estijos bei Lietuvos realiojo BVP vienam gyventojui palyginimas su 12 pirmųjų euro zonos šalių vidurkiu (2 pav.).
2004 m. Estijos BVP vienam gyventojui sudarė 35,3 proc. 12 euro zoną suformuosiančių šalių BVP vidurkio. Lietuvos BVP vienam gyventojui tuo metu sudarė 25,6 proc., o Latvijos – 25,8 proc. tų pačių 12 šalių vidur-
kio. Laikui bėgant Baltijos šalys vijosi ES šalis lyderes ir atotrūkį sumažino. 2021 m. Estijos BVP vienam gyventojui sudarė 51,6 proc., Lietuvos –46,9 proc., o Latvijos – 40,6 proc. minėtų šalių vidurkio. Energijos išteklių krizė, sudavusi stiprų smūgį Baltijos šalims, nulėmė tai, kad 2023 m. Estijoje šis rodiklis susitraukė net iki 47,2 proc., tuo tarpu Lietuvoje – tik iki 45,5 proc. vidurkio, o Latvijoje išliko toks pats. Apskritai narystės ES metu Lietuva sparčiau vijosi likusias šalis nei Estija, tačiau per pastaruosius metus abiejų šalių rodikliai, palyginti su 12 turtingiausių ES šalių rezultatais, suprastėjo, ir Estijoje šis suprastėjimas buvo didesnis nei Lietuvoje.
Lietuva Estiją pralenkė prieš dvejus metus
Žinant bendras Baltijos šalių ekonomikų raidos tendencijas bus galima tinkamai interpretuoti su jų sostinėmis siejamų regionų dinamiką.
Lietuvos Sostinės regionas – tai ne Vilnius ir geriausios Vilniaus rajono zonos.
3 pav. Nominalusis ir realusis BVP vienam gyventojui (2010 m. eurais) Talino, Vilniaus ir Rygos regionuose nuo 2000 iki 2022 m.
Žvelgiant į Baltijos šalių sostinių regionų BVP vienam gyventojui dinamiką, galima pastebėti, kad iki COVID-19 pandemijos BVP vienam gyventojui Rygoje ir Parygėje iš esmės niekuo nesiskyrė nuo BVP vienam Vilniaus apskrities gyventojui (3 pav.). 2007 m. Vilniaus apskrities BVP vienam gyventojui pralenkia vienam Rygos ir Parygės gyventojui tenkantį BVP ir su kiekvienais metais nuo jo vis labiau nutolsta. Atotrūkio pikas fiksuojamas 2021 m., kai vienam Vilniaus apskrities gyventojui tenkantis BVP 31,7 proc. viršija BVP vienam Rygos ir Parygės gyventojui.
Lyginant Vilniaus apskritį su Šiaurės
Estija galima pastebėti, kad iki finansų krizės Šiaurės Estijoje vienam gyventojui tenkančios agreguotos gamybos apimtys buvo didesnės nei Vilniaus apskrityje.
Vėlesniais laikotarpiais šis skirtumas sumažėjo, o nuo 2017 m. pradėjo nykti. 2021 m. Lietuvos Sostinės regiono realu-
sis BVP vienam gyventojui pralenkia Estijos sostinės regiono BVP vienam gyventojui. Nominalusis BVP vienam Vilniaus apskrities gyventojui pralenkia Šiaurės Estijos regiono rodiklį tik 2022 m. Tai, kad Estijos BVP vienam gyventojui augimo tempas nesmuko iki pat COVID-19 pandemijos pradžios, o Šiaurės Estijos regione BVP vienam gyventojui augimas sulėtėjo dar 2018 m., rodo, kad dalis ekonominių veiklų Estijoje iš šiaurinės dalies persikėlė kitur. Toks Estijoje įvykęs vidinis persiskirstymas tarp regionų nulėmė, kad Vilniaus apskrityje BVP vienam gyventojui tapo didesnis už BVP vienam Šiaurės Estijos gyventojui. Visos šalies mastu Estijos BVP vis dar yra didesnis už Lietuvos BVP, tenkantį vienam gyventojui. 2022 m. Vilniaus apskrities realusis BVP vienam gyventojui 6,1 proc. viršijo Šiaurės Estijos BVP vienam gyventojui, tačiau bendras visos šalies
BVP vienam gyventojui buvo 7 proc. mažesnis už Estijos rodiklį. Lietuvos realusis BVP vienam gyventojui 2022 m. sudarė 52 proc. ES vidurkio, 46 proc. pirmųjų 12 euro zonos narių vidurkio ir buvo 14 proc. didesnis už Latvijos rodiklį. Kad suvoktume, jog šie Baltijos šalių pasiekimai egzistuoja, bet nėra itin dideli, užteks vieno iškalbingo fakto: Latvijos realusis BVP vienam gyventojui 2022 m. buvo 1 proc. mažesnis už realųjį BVP vienam Turkijos gyventojui. Kiek laiko praeis, kol realusis Turkijos BVP, tenkantis vienam jos gyventojui, viršys realųjį Lietuvos BVP, tenkantį vienam mūsų šalies gyventojui?
Regiono lyderystę atskleidžia ne politikų deklaracijos, o faktai. Faktai parodo, kaip yra iš tiesų, ir jeigu susiklosčiusi padėtis mūsų netenkina, galime ją keisti.
Cheminės reakcijos
kodėl „click“ technologija nusipelnė Nobelio premijos?
Prof. Viktoras Masevičius
Vilniaus universiteto Chemijos ir geomokslų fakultetas
Prof. Giedrius Vilkaitis
Vilniaus universiteto Gyvybės mokslų centras
Biologiniai procesai, vykstantys įvairiuose – tiek bakterijų, tiek žmogaus –organizmuose, yra grindžiami daugybe cheminių reakcijų. Kad šios reakcijos vyktų efektyviai, reikiamu laiku ir reikiamoje vietoje, kiekvienoje ląstelėje triūsia tūkstančiai biologinių katalizatorių – fermentų.
Net nedideli vieno iš fermentų veikimo sutrikimai gali tapti ligos priežastimi, o jų katalizuojamų reakcijų ar veiklos produktų analizė sveikose ir sergančių organizmų ląstelėse leidžia diagnozuoti ligą ar parinkti terapijos būdą. Atlikdami tyrimus mokslininkai ir medikai susidūrė su problema, kad daugelis įprastų cheminių reakcijų, puikiai vykstančių laboratorinėmis sąlygomis, netinka daugialypėje ląstelės aplinkoje vykstantiems procesams tirti ar molekulėms, turinčioms naujų savybių, gaminti. Gyvuose organizmuose vykstančių „click“ cheminių reakcijų taikymas lemtingai pakeitė šią situaciją.

„Click“ technologija leidžia gaminti ląsteles, pasižyminčias naujomis funkcijomis
Vilniaus universiteto Gyvybės mokslų centro biotechnologai kartu su Chemijos ir geomokslų fakulteto chemikais taiko modifikuojančius fermentus metiltransferazes epigenetiniams, epitranskriptomo ar RNR sudėties tyrimams, taip pakeisdami jų vykdomas reakcijas, kad jos perneštų specifinių substratų chemines grandines su negamtinėmis „click“ cheminėms reakcijoms tinkamomis funkcinėmis grupėmis ant specifinių DNR ar RNR taikinių. „Click“ reakcijos leidžia efektyviai prijungti dominančias chemines grupes prie ląstelėje esančių biomolekulių ir taip analizuoti jų vietą ir kiekį, specifinių signalų pokyčius ar net gaminti cheminius junginius, vaistus ar ląsteles, pasižyminčias naujomis funkcijomis.
Kadangi šiai reakcijai reikalingų sudėtingų substratų cheminė sintezė dažnai yra brangi ar net neįmanoma, Vilniaus universiteto mokslininkai bando unikaliai sujungti cheminius ir biologinius metodus tokiems substratams gaminti.
Cheminiai procesai vyksta visur
Daugumai žmonių chemijos sąvoka asocijuojasi su valymo priemonėmis.
Dažnai netgi įvairius maisto produktų konservantus, įskaitant natūraliai aptinkamus gamtoje, tūlas pilietis irgi pavadina „chemija“.
Ar žinojote, kad visi gyvybiniai procesai, vykstantys mūsų kūne, yra cheminės reakcijos arba glaudžiai su jomis susiję? Būtent šios reakcijos organizmo ląstelėse palaiko ir užtikrina gyvybę. Pavyzdžiui, kvėpavimo metu išsiskiriantis CO2 susidaro organizme vykstant sudėtingoms cheminėms reakcijoms, kurios yra žmogaus metabolizmo dalis.
Dauguma vartojančiųjų vaistus net nesusimąsto, kaip jų organizmą veikia kas rytą ir vakarą geriama „chemija“ –svarbus tik rezultatas: mažesnis kraujo spaudimas, išnykęs galvos skausmas ar stabilizuotas gliukozės kiekis. O iš tiesų vaistinės medžiagos reguliuoja organizmo metabolizmą: vieni vaistai stabdo ar sulėtina vykstančias chemines reakcijas, kiti atvirkščiai – sudaro sąlygas joms vykti ar jas pagreitina, o treti, sąveikaudami su ląstelės receptoriais, keičia medžiagų įsisavinimą organizme.
Visiems gerai žinomas aspirinas modifikuoja tam tikrą fermentą ir sustabdo jo veikimą. Dėl to organizme gaminasi mažiau medžiagų, vadinamų prostaglandinais ir tromboksanais. Prostaglandinai yra atsakingi už uždegiminius procesus, o tromboksanai

Iš kairės į dešinę: prof. Giedrius Vilkaitis, dokt. Bernadeta Masiulionytė, dokt. Martynas Malikėnas, dr. Gražina Petraitytė, prof. Viktoras Masevičius. Tyrėjų asmeninio archyvo nuotr.
padeda kraujui krešėti. Štai kodėl aspirinas malšina skausmą, pasižymi uždegimą slopinančiomis savybėmis ir mažina kraujo krešėjimą.
Daugelis cheminių reakcijų netinka ląstelės procesų tyrimams
Sumaišę tinkamomis sąlygomis tarpusavyje sąveikaujančias medžiagas ir reakciją skatinančius katalizatorius cheminiams bandymams atlikti skirtame inde, galime gana tiksliai prognozuoti cheminės reakcijos eigą. Tačiau daug sunkiau manipuliuoti gyvų organizmų cheminėmis reakcijomis siekiant konkrečių tikslų ar ląstelėse vykdyti naujas chemines reakcijas, kurios nėra užprogramuotos mūsų genome – mūsų DNR. Taigi kaip galime paveikti ląstelėje vykstančias reakcijas ar net sukelti tokias, kurios ląstelei įprastai nebūdingos? Ląstelę galima palyginti su cheminiu indu, tik izoliuotu nuo aplinkos ne stiklo sienele, o ląstelės plazmine membrana. Tačiau natūraliai ląstelėje vyksta daugybė cheminių reakcijų ir joje gausu įvairių reaktyvių grupių. Įvedus į ląstelę papildomų reagentų, kad įvyktų dar viena reakcija, jie nebūtinai reaguos tik tarpusavyje, o gali sąveikauti su aibe junginių, jau esančių daugialypėje ląstelės aplinkoje.
Norint parinkti tinkamas chemines reakcijas, reikia atsižvelgti į veiksnius, lemiančius cheminės reakcijos tarp junginių vykimą. Atmetus sunkiai ląstelėje kontroliuojamas sąlygas, tokias kaip temperatūra ir slėgis, lieka junginio struktūra, kurią apibrėžia atomų išsidėstymo tvarka molekulėje. Ši tvarka lemia struktūrinių molekulės fragmentų – funkcinių grupių, kurioms reaguojant tarpusavyje vyksta reakcijos tarp molekulių, atsiradimą. Jei pasitelksime medžiagas, turinčias funkcines grupes, kurios natūraliai aptinkamos ląstelėje, nekontroliuojamos reakcijos gali įvykti ne tik tarp tikslinių molekulių, bet ir tarp kitų ląstelės komponentų. Tik tuo atveju, jei į ląstelę įvedamos medžiagos turės reaktyvias funkcines grupes, neap-
Biologinėms
tinkamas gyvojoje gamtoje ir nereaguojančias su ląstelėje esančiais junginiais, jos nedarys įtakos natūraliai ląstelėje vykstančioms reakcijoms. Tokios reakcijos yra vadinamos bioortogonaliomis ir leidžia suformuoti kovalentinį ryšį (cheminis ryšys, atsirandantis susidarant bendroms elektronų poroms) tarp dviejų junginių, iš kurių bent vienas gali būti ir modifikuota biomolekulė (1 pav.). Biologinėms sistemoms pritaikytų cheminių reakcijų atradimas atvėrė naujus taikymo horizontus daugelyje sričių, ne tik moksliniuose tyrimuose, bet ir medicinoje, diagnostikoje, medžiagų chemijoje ir biokatalizėje.
Reakcijos, įvertintos Nobelio premija
Funkcinių grupių, kurios gali dalyvauti bioortogonaliose reakcijose, pasirinkimas nėra gausus. Šiuo metu populiariausia bioortogonalių funkcinių grupių pora yra azido grupė, kurią sudaro trys linijiniu būdu tarpusavyje susijungę azoto atomai, ir alkino grupė, sudaryta iš dviejų anglies atomų, sujungtų trigubuoju ryšiu. Šios grupės reaguoja tarpusavyje, sudarydamos triazolo jungtuką (1B pav.).
Karlas Barry Sharplessas, vadovavęs chemikų grupei, kuri išplėtojo šią vienvalenčio vario druskų katalizuojamą reakciją, pavadino ją „click“ reakcija. Šis pavadinimas atspindi didelį reakcijos greitį ir efektyvumą – tik spragt (angl. click) ir viskas baigta. Tačiau reakcijai būtinos vario druskos biologinėje aplinkoje sąveikauja su baltymais ir taip keičia jų savybes, veikia nukleorūgštis – todėl ląstelėje pritaikyti šią reakciją būtų sunkiai išsprendžiama problema. Galvodama apie tai, Caro-
lyn Ruth Bertozzi su kolegomis pasiūlė vietoje įprasto trigubojo ryšio naudoti aktyvesnį jo analogą – įtemptą trigubąjį ryšį (1B pav.). Šioms azido-alkino reakcijoms vario druskos nėra būtinos, todėl jos geriau tinka dirbant su biomolekulėmis ar biologinėje terpėje. Taigi kur galime panaudoti „click“ reakcijas? Kolboje mes galime sujungti dvi ypač sudėtingas molekules su daugybe skirtingų funkcinių grupių tarpusavyje, jei vienoje yra azido grupė, o kitoje – trigubasis ryšys. O štai gyvuose organizmuose ar ląstelėse mes dėl šios reakcijos galime pažymėti norimus molekulinius taikinius. Įterpę į organizmą molekulę, turinčią azido grupę, o paskui į jį įvedę molekulę su trigubuoju ryšiu ir prijungta žyme, pavyzdžiui, fluorescenciniu dažu, pažymėsime organizme vietas, kuriose lokalizavosi azido grupę turinti molekulė. Tokiu būdu gali būti vizualizuojami ląstelės paviršiuje išsidėstę karbohidratai, kurie yra atsakingi už ląstelių tarpusavio sąveiką, be to, gali tarnauti žymenimis vėžinėse ląstelėse. Analogiškai galime pažymėti ląstelės branduolį, prieš tai funkcionalizavę DNR azido grupe. Pripažindama šio atradimo svarbą, Švedijos karališkoji mokslų akademija 2022 m. apdovanojo K. B. Sharplessą, Morteną Meldalį ir C. R. Bertozzi prestižine Nobelio premija už „click“ reakcijos sukūrimą ir jos pritaikymą biologinėse sistemose.
Kodėl organizmą sudarančios ląstelės skiriasi?
Visos žmogaus organizmą sudarančios ląstelės turi identišką genetinį kodą, tai yra iš cheminių raidžių –
DNR nukleotidų sudarytą vienodą tekstą, kuriame yra užkoduota paveldima informacija. Tačiau skirtingų audinių ar organų ląstelės nėra panašios – jos gali skirtis tiek morfologija, tai yra savo forma, tiek atliekamomis funkcijomis. Pavyzdžiui, odos ląstelės kaip skydas saugo organizmą, kad nepatektų mikroorganizmų, kad neatsirastų mechaninių ar cheminių pažeidimų, po jomis esantis melanocitų sluoksnis sintetina melaniną, kuris apsaugo nuo žalingo ultravioletinės spinduliuotės poveikio. Tuo tarpu kasos ląstelės atlieka daug funkcijų, iš kurių viena yra gliukozės koncentracijos kraujyje palaikymas.
Kyla klausimas: kodėl organizmo ląstelės skiriasi, jei visos jos vadovaujasi ta pačia instrukcijų knyga? Paaiškėjo, kad kiekvienas ląstelių tipas naudoja tik tam tikras genetinio kodo dalis, o svarbų vaidmenį paženklinant, kurių konkrečių instrukcijos knygos dalių – genų – nereikia skaityti, vaidina specialūs cheminiai ženklai – metilo grupės. Jie nekeičia genetinio teksto, todėl vadinami epigenetinėmis žymėmis. Nuskaitydama tik reikiamų genų koduojamą informaciją, kiekviena ląstelė gauna specifinį funkcinių RNR ir baltymų rinkinį, kuris ir nulemia jos savybes. Ypač svarbi baltymų grupė – fermentai, kurie atlieka lemiamą vaidmenį saugant ir perduodant genetinę informaciją, skaidant maisto medžiagas energijai gauti ir kuriant naujus ląstelių komponentus, reguliuojant molekulių judėjimą ląstelės viduje, reaguojant į aplinkos pokyčius ir stresą ar net sąveikaujant su kitomis ląstelėmis. Būtent genomą modifikuojantys fermentai – DNR
metiltransferazės yra atsakingos už epigenetinių metilo žymių uždėjimą ant specifinių DNR molekulės vietų, kurios būtinos anksčiau minėtai genų aktyvumo reguliacijai.
Kita fermentų grupė – RNR metiltransferazės – uždeda metilo žymes ant reikiamų RNR molekulių ir taip palaiko jų stabilumą. RNR ląstelėje yra atsakinga už baltymų sintezę ir šio proceso reguliavimą, taip pat gali katalizuoti chemines reakcijas. RNR visuma sudaro transkriptomą, kurio funkcionavimą regu -
liuoja epitranskriptominiai veiksniai, tokie kaip metilo grupės. Baltymus modifikuojančios metiltransferazės gali turėti įtakos genų nuskaitymo efektyvumui ar baltymų veikimui ir stabilumui ląstelėse. Metiltransferazės atlieka gyvybiškai svarbų vaidmenį palaikant ląstelės funkcijas, todėl, sutrikus šių fermentų veiklai organizme, suardomas biologinių procesų reguliavimas, o tai gali sukelti įvairius sveikatos sutrikimus, pavyzdžiui, vėžinius susirgimus, neurodegeneracines ar imunodefi -
citines ligas. Būtent „click“ reakcijų pritaikymas leistų geriau suprasti ligų etiologiją ir padėtų kuriant ankstyvesnio ligų aptikimo metodus. Tokius epigenetinius, epitranskriptominius ir RNR tyrimus, grindžiamus „click“ metodo pritaikymu, Vilniaus universitete vykdo prof. Viktoro Masevičiaus ir prof. Giedriaus Vilkaičio vadovaujama jungtinė chemikų ir biologų komanda, į kurią, be minėtų mokslininkų, dar įeina dr. Gražina Petraitytė, dokt. Martynas Malikėnas ir dokt. Bernadeta Masiulionytė.

1 pav. Supaprastintas „click“ tipo reakcijos modelis (A). Azidų ir alkinų „click“ reakcija ir jos pritaikymo ląstelėse pavyzdys (B). Tetrazinų „click“ tipo reakcijos pritaikymas nukleorūgščių žymėjimo technologijose (C). Dokt. Martyno Malikėno iliustracija
„Click“
reakcijų pritaikymas leistų geriau suprasti ligų etiologiją ir padėtų kuriant ankstyvesnio ligų aptikimo metodus.

2 pav. Natūraliai aptinkamas S-adenozil-L-metionino kofaktorius (kairėje) ir jo sintetinis analogas (dešinėje), taikomas metiltransferazių katalizuojamose reakcijose. Dokt. Martyno Malikėno schema
Tyrimai leidžia geriau suprasti ligų atsiradimo priežastis
Postūmį pradėti epigenetinius ir epitranskriptominius tyrimus Vilniaus universitete davė prof. Sauliaus Klimašausko ir Elmaro Weinholdo idėjos, pasiūlytos prieš du dešimtmečius. Ypač domimasi fermentais metiltransferazėmis, kurios uždeda žymes specifinėse makromolekulių, tokių kaip DNR, RNR ar baltymai, vietose, svarbiose jų atliekamoms funkcijoms. Natūraliai metiltransferazės perneša nedidelę metilo grupę, kuri yra sudaryta iš vieno anglies ir trijų vandenilio atomų. Chemiškai ši žymė nėra aktyvi, todėl dažnai netinka epigenetiniams signalams profiliuoti ar epigenetiniams procesams tirti. Todėl Vilniaus universitete vykdomas platus tyrimas, kuriuo siekiama praplėsti gamtos nulemtas fermentų veikimo ribas, kad jie galėtų ant tiriamų biomolekulių pernešti ilgas ir chemiškai aktyvias funkcines grupes. Tokias grupes metiltransferazės paima nuo sudėtingų cheminių junginių, vadinamų kofaktoriais (2 pav.). Kadangi daugumą jų yra sudėtinga ar net neįmanoma sintetinti cheminiais metodais, Vilniaus universiteto mokslininkai pritaikė chemofermentinį būdą, kai reikia -
mas kofaktorius yra sukuriamas naudojant fermentą, sujungiantį du paprastesnius, chemiškai susintetintus junginius. Naujų kofaktorių, kurie turi chemiškai aktyvias grupes, naudojimas metiltransferazių reakcijose atvėrė galimybę specifinėse genomo vietose pažymėti DNR ar RNR molekules ir praplėsti epigenetikos srityje naudojamų metodų spektrą. Pavyzdžiui, prie funkcinės azido ar tetrazino grupės „click“ chemijos būdu galime prijungti fluorescuojančias medžiagas. Dėl tokių šviečiančių junginių lengvai galime vizualizuoti ir stebėti ląstelėje esančių DNR ar RNR makromolekulių lokalizaciją (1C pav.). Be to, taikydami šiuos molekulinius įrankius galime tiksliau įvertinti epigenetinių ir epitranskriptominių signalų pokyčius ir geriau suprasti ligų atsiradimo priežastis ar svarbių biologinių procesų eigą.
Taigi sujungdami biologinius ir cheminius metodus ir pasitelkdami fermentus, gebančius sintetinti reikiamus substratus su ilgesnėmis žymėmis, prof. V. Masevičiaus ir prof. G. Vilkaičio grupės nariai tikisi dar labiau praplėsti metiltransferazių panaudojimą biologiniuose ir medicininiuose tyrimuose.
Tomas Karpavičius
Vilniaus universiteto Ekonomikos ir verslo administravimo fakultetas
Pastaraisiais metais mikromobilumo, t. y. dviračių, elektrinių paspirtukų, riedžių ir kitų panašių transporto priemonių naudojimo, banga apėmė kone visus didmiesčius visame pasaulyje. Ši mikromobilumo revoliucija ne tik
keičia mūsų kasdienio judėjimo įpročius, bet ir turi reikšmingą poveikį miestų ekonomikai, transporto sistemoms, aplinkai bei miestų gyventojų sveikatai.

Kas yra mikromobilumas?
Mikromobilumo terminą pirmasis pavartojo ir pristatė Horace'as Dediu 2017 m., o 2018 m. pasaulinė standartų kūrimo ir profesinė asociacija „SAE International“ (Society of Automotive Engineers) standartizavo mikromobilumo apibrėžimą: jis apima mažas, lengvas, judėjimui žmogaus jėgą arba elektrą naudojančias transporto priemones, skirtas neilgoms kelionėms, t. y. paprastus ir elektrinius dviračius, paspirtukus, riedlentes, riedžius. Nustatyta, kad šios transporto priemonės neturi turėti vidaus degimo variklių ir negali viršyti maksimalaus 45 km/h greičio. Jos leidžia greitai ir lengvai keliauti mieste, išvengti spūsčių ir labiau rūpintis aplinkos taršos mažinimu.
Vienas iš pagrindinių mikromobilumo privalumų yra lankstumas. Šios transporto priemonės yra lengvai saugomos, pasiekiamos ir gali būti naudojamos bet kuriuo paros metu nekeldamos didelio triukšmo. Dėl savo kompaktiško dydžio jos gali lengvai manevruoti miestų gatvėmis, išvengdamos kamščių ir taupydamos laiką. Be to, daugelis mikromobilumo priemonių yra elektrinės, todėl jos mažiau teršia aplinką nei tradiciniai automobiliai.
Mikromobilumo pradžia siejama su dviračiais
Mikromobilumas pasaulyje pirmiausia yra siejamas su dviračių dalijimosi paslaugų atsiradimu. Šių paslaugų istorija apima keturis etapus. Pirmojo visuotinių mikromobilumo paslaugų diegimo etapo pradžia – 1965 m. Amsterdame įgyvendinta 50 baltų dviračių programa, kuri nesiekė pelno ir buvo skirta miesto gyventojų skaičiaus didėjimo ir miesto plėtimosi problemoms spręsti. Tačiau ši iniciatyva susidūrė su didelėmis problemomis, tokiomis kaip dviračių vagystės ir jų negrąžinimas laiku.
Antrasis etapas prasidėjo JAV Teksaso ir Viskonsino valstijose, Norvegijoje (1996), Suomijoje (2000), Danijoje (2005). Atsirado labiau organizuoti, pelno siekiantys dviračių dalijimosi verslo modeliai su transporto priemonių prijungimo stotelėmis, užstatais ir užraktais, kurie pagerino saugumą, bet neišsprendė dviračių priežiūros, gedimų ir taisymo problemų.
Trečiojo etapo pradžia – 2005 m. Prancūzijoje, kai kompanija „Vélo‘v“ gyventojams pasiūlė naudotis 1500 dviračių. Ji taikė pažangias stebėjimo, rezervavimo, klientų autentifikavimo ir elektroninių mokėjimų technologi-
jas, kurios padidino dviračių dalijimosi paslaugų populiarumą visame pasaulyje iki rekordinių 100 paslaugų teikėjų 125 miestuose, 4 žemynuose.
Ketvirtajame etape buvo toliau integruojamos naujausios technologijos ir patogesnės klientų paskyrų ir dviračių stotelių sąsajos. Kanados įmonė BIXI rinkai pristatė elektrinius dviračius ir netrukus tapo didžiausia šio sektoriaus žaidėja Šiaurės Amerikos žemyne ir mikromobilumo inovacijų lydere pasaulyje.
Ekonominė nauda miestams, verslams, žmonėms
Mikromobilumo sprendimų integravimas gali turėti didelį teigiamą tiesioginį ir netiesioginį poveikį vietos ekonomikai ir miestų gyventojams.
Mikromobilumo paslaugos kuria naujas verslo galimybes ir naujas darbo vietas. Pavyzdžiui, tokie elektrinių paspirtukų nuomos paslaugų teikėjai kaip „Bolt“ ar „CityBee“ kuria darbo vietas tiek tiesiogiai (aptarnaujantis ir techninės priežiūros personalas), tiek netiesiogiai (IT paslaugos, rinkodara, administravimas, paspirtukų gamintojai) ir moka mokesčius. Be to, mikromobilumo sprendimai skatina vietos verslą, nes žmonės gali

pasaulyje pirmiausia yra siejamas su dviračių dalijimosi paslaugų atsiradimu.
lengviau ir greičiau pasiekti įvairias miesto vietas, taip pat ir mažesnes parduotuves bei restoranus. Tai ypač naudinga smulkiesiems verslininkams, kurie nori, kad klientai juos pasiektų lengvai ir greitai.
Turizmas taip pat daro didelę įtaką miestų ekonomikai. Miestai su gerai išplėtota mikromobilumo infrastruktūra pritraukia daugiau turistų, o tai padeda papildyti miestų biudžetus ir skatina vietos verslų – nuo restoranų iki viešbučių – klestėjimą. Paryžius, Londonas, Barselona ir kiti populiarūs turistiniai miestai paprastai turi gerai išplėtotą mikromobilumo infrastruktūrą.
Kyla klausimas, ar mikromobilumo paslaugos teikia ekonominę naudą žmogui. Visų pirma, mikromobilumas gali sumažinti kelionių mieste išlaidas. Pavyzdžiui, kelionė elektriniu paspirtuku kainuoja apie 0,15–0,20 euro už kilometrą, o automobilio eksploatacija – apie 0,50 euro už kilometrą. Be to, paspirtuko draudimo ir pastatymo išlaidos yra daug mažesnės nei automobilio, todėl bendras kainų skirtumas dar didesnis.
Dar vienas pavyzdys, kur būtų galima sutaupyti naudojantis mikromobilumo paslaugomis – tai infrastruktūra. Mikromobilumo priemonės sumažina brangios automobilių infrastruktūros (kelių, magistralių, apšvietimo, stovėjimo aikštelių) poreikį. Pavyzdžiui, vieno kilometro dviračių tako įrengimas gali kainuoti nuo 50 tūkst. iki 250 tūkst. eurų, tuo tarpu kelių tiesimo sąnaudos – apie 1,5 mln. eurų už kilometrą.
Mikromobilumo paslaugos turi realią ekonominę naudą ir sveikatos priežiūros srityje. Mažiau taršos ir daugiau fizinio aktyvumo, pavyzdžiui, važiavimo dviračiu, sumažina sveikatos priežiūros išlaidas, o sveika visuomenė yra produktyvesnė. Europos Komisijos duomenimis, sumažinus oro taršą ES galima sutaupyti mažiausiai 3 mlrd. eurų sveikatos priežiūros išlaidų per metus. Elektriniai paspirtukai ir dviračiai išmeta daug mažiau CO 2 nei automobiliai: paspirtukai – tik 33,7 g CO2/km, o benzininiai automobiliai –200–350 g CO2/km.
Be to, naudojimasis dviračiais ir paspirtukais padeda sumažinti automobilių skaičių gatvėse, o tai sumažina spūstis ir kelionės laiką. Mažiau automobilių reiškia ir mažesnį stovėjimo vietų poreikį, todėl miestai šias vietas gali panaudoti kitoms reikmėms, pavyzdžiui, žaliosioms, sporto ar viešosioms erdvėms.
Poveikis miestų transporto sistemai
Amsterdamo, Kopenhagos ir San Francisko pavyzdžiai rodo, kad mikromobilumo sprendimai gali būti veiksmingai integruoti į miestų transporto sistemas. Šie miestai skatina naudotis dviračiais ir paspirtukais, kurdami tinkamą infrastruktūrą ir teikdami prieinamas mikromobilumo paslaugas.
Amsterdamas yra žinomas kaip dviratininkų rojus. Čia dviratis yra pagrindinė susisiekimo priemonė, o miestas labai daug investuoja į saugius ir patogius dviračių takus ir švietimą. „McKinsey & Company“ duomenimis, dviračių ir kitų mikromobilumo priemonių naudojimas Amsterdame eismo spūstis per pastaruosius 5 metus sumažino 10 proc., o išmetamųjų teršalų kiekį – 12 proc. Be to, dviračių pramonė mieste sukuria apie 19 000 darbo vietų. Kopenhaga – dar vienas Europos miestas, žinomas dėl meilės dviračiams. Miestas skatina dviračių kultūrą įvairiomis iniciatyvomis ir yra vienas pirmųjų miestų pasaulyje, kuriuose dviratininkams įdiegtos „žaliosios bangos“ sistemos, leidžiančios sklandžiai, nesustojus, pravažiuoti pro šviesoforus. Pasak „McKinsey & Company“, dviračių naudojimas Kopenhagoje per pastaruosius 5 metus sumažino eismo spūstis 15 proc., o oro taršą – 20 proc. Dviračių pramonė čia generuoja apie 22 milijonus eurų metinių pajamų.
Nepaisant kalvoto reljefo, San Franciske taip pat tapo populiaru naudotis elektriniais paspirtukais ir dviračiais. Miestas įgyvendino jais naudotis skatinančias iniciatyvas, pavyzdžiui, įkūrė specialias stovėjimo vietas ir patvirtino saugumo taisykles. „Boston Consulting Group“ duomenimis, per pastaruosius 4 metus dėl mikromobi-
lumo sprendimų eismo spūstys mieste sumažėjo 8 proc., išmetamų teršalų kiekis – 5 proc., o pajamos iš turizmo padidėjo 3 proc.
Vilniaus pavyzdys
Pirmieji Vilniaus miesto žingsniai mikromobilumo srityje žengti dar 2001 m., kai meras Artūras Zuokas pradėjo dalijimosi dviračiais projektą, kurio metu buvo galima nemokamai naudotis 500 oranžinių dviračių. Deja, iniciatyva greitai žlugo, nes dauguma dviračių buvo pavogti arba sugadinti, savivaldybė patyrė finansinių nuostolių, o meras užsitikrino politinių oponentų pašaipas dar ilgiems metams. Vis dėlto Vilnius nieko blogo nepadarė –Vakarų Europoje tokios dviračių dalijimosi paslaugos veikė jau nuo 1960-inių. Reikia pripažinti, kad mums tiesiog trūko tokio dalijimosi modelio įdiegimo žinių, technologinių sprendimų, teisinės bazės, visuomenės supratimo ir palaikymo.
Prabėgus keliems dešimtmečiams turime visiškai kitokią situaciją. 2023 m. Vilniuje naudojimasis dviračiais ir elektriniais paspirtukais smarkiai išaugo.
Vilniaus miesto savivaldybės duomenimis, dviračių takų ilgis mieste padidėjo iki 150 kilometrų, o tai yra 20 proc. daugiau, nei buvo 2020 m., ir 120 kilometrų daugiau, nei buvo 2016 m. Dėl šios infrastruktūros plėtros naudojimasis dviračiais išaugo 35 proc., o elektriniais paspirtukais – net 52 proc. Miestas toliau investuoja į saugių dviračių takų plėtrą ir viešųjų erdvių pritaikymą elektriniams paspirtukams.
Vilniuje veikia nemažai įmonių, kurios siūlo įvairius mikromobilumo sprendimus: „Cyclocity“ (300 dviračių), „Bolt“ (apie 1500 paspirtukų ir apie 500 elektrinių dviračių), „Ride Mobility“ (apie 400 elektrinių dviračių). Visos šios įmonės prisideda tiek prie mikromobilumo skatinimo, spūsčių mažinimo, mažesnio transporto priemonių skaičiaus, mažesnio automobilių stovėjimo aikštelių poreikio, tiek – ir tai turbūt svarbiausia – prie miesto gyventojų sveikatos gerinimo.
Vilnius įgyvendina įvairias mikromobilumo skatinimo iniciatyvas. Bendradarbiaujama su paslaugų teikėjais siekiant užtikrinti patogumą vartotojams, organizuojamos edukaci -
nės kampanijos apie mikromobilumo privalumus ir saugumą. Šios pastangos duoda rezultatų: daugėja žaliųjų zonų, per metus CO2 emisija sumažėja apie 1000 tonų, o spūstys – apie 10 proc. Šie veiksniai ir Žaliosios bangos iniciatyva lėmė, kad Vilnius 2025 m. tapo Europos žaliąja sostine. Vilniaus miesto savivaldybė planuoja ir toliau investuoti į mikromobilumo infrastruktūros tobulinimą ir plėtrą. Dviračių takų tinklą planuojama išplėsti dar 35 proc., o elektriniams paspirtukams numatyta daugiau saugesnių pastatymo vietų.
Tyrimo dalyviai iš keturių pasaulio miestų
Siekiant dar geriau suprasti mikromobilumo mastą ir reikšmę, Amsterdame, Kopenhagoje, San Franciske ir Vilniuje buvo atliktos gyventojų apklausos. Kiekviename mieste 1000 gyventojų buvo prašoma atsakyti į 20 su mikromobilumu susijusių klausimų.
Visuose miestuose, išskyrus Kopenhagą, mikromobilumo sprendimai populiaresni tarp vyrų. Populiariau -



3 pav. Ankstyvosios stadijos rizikos kapitalo investicijų į elektrinių dviračių ir triračių transporto priemonių startuolius vertė visame pasaulyje 2010–2022 m. Sudarė autorius, remdamasis Statista.com duomenimis
sios mikromobilumo paslaugos yra Amsterdame (42 proc. respondentų jomis naudojasi kasdien), Kopenhagoje (39 proc.), o mažiausiai populiarios – Vilniuje (20 proc. respondentų naudojasi kelis kartus per mėnesį) (1 pav.). Mikromobilumo priemonės kaip pagrindinės transporto priemonės daugiausia naudojamos Amsterdame (63 proc.). Kopenhagoje (82 proc.) ir San Franciske (72 proc.) tai yra priemonės nuvažiuoti iki darbo ar mokyklos. O Vilniuje (41 proc.) jos dažniausiai naudojamos laisvalaikiui ir sportui. Naudodami mikromobilumo priemones vietoje automobilio ar taksi,
Amsterdamo (83 proc.) ir Kopenhagos (77 proc.) gyventojai per mėnesį dažniausiai sutaupo daugiau nei 200 eurų, o vilniečiai – mažiau nei 20 eurų. Tokie rezultatai nelabai stebina, nes mikromobilumo priemonės, kurios jau seniai įsitvirtinusios Vakarų Europos miestuose, pas mus dar tik skinasi kelią į įprastą vilniečių judėjimo rutiną.
Investicijos į mikromobilumo rinką auga
Pasaulinė mikromobilumo rinka, pasak „McKinsey & Company“, 2022 m. buvo vertinama 150 milijardų eurų ir 2030 m.
turėtų pasiekti įspūdingus 320 milijardų eurų. Čia išsiskiria startuolis „Lyft“, kuris savo veiklą pradėjo 2012 m. ir šiuo metu turi apie 3000 darbuotojų (2 pav.).
Dėl mikromobilumo populiarumo ir teigiamo visuomenės požiūrio investicijos į šią sritį nuolat didėja. Didžiausias augimas užfiksuotas 2019 m., tačiau per COVID-19 pandemiją jis sumažėjo. 2022 m. investicijos vėl pradėjo augti (3 pav.). Vis dėlto tai tik ankstyvosios stadijos investicijos – pridėję vėlesnes investicijas gautume dvigubai ar net trigubai didesnius skaičius.
DIRBTINIO INTELEKTO REGULIAVIMAS
Dr. Neringa Gaubienė Emilė Ieva Šapkauskaitė
Vilniaus universiteto
Teisės fakultetas
Europos Sąjunga parodė lyderystę dirbtinio intelekto (DI) reguliavimo srityje ir siekia nustatyti pagrindines taisykles DI ir jo kūrėjams, kad naujosios technologijos nepradėtų daugiau kenkti negu tarnauti žmonėms. Toks susirūpinimas kilo dėl galimo plataus visuomeninio DI poveikio, kuris turėtų įtakos asmenų teisei į darbą, sveikatos apsaugą, saugią aplinką, privatumą, duomenų apsaugą ir t. t.
Pripažįstama, kad technologijas, nestabdant jų pažangos, reguliuoti būtina ir kad svarbu kurti bei diegti tokias DI sistemas, kurios neprasilenktų su žmogiškosiomis vertybėmis, teisėmis ir gerove. Todėl pagrindinis reikalavimas, kuris bus keliamas DI – gerbti žmogaus teises. DI kūrėjai turės užtikrinti, kad jis būtų veiksmingas, humaniškas ir etiškas, o jo reguliavimas – grindžiamas pagarba žmogaus teisėms.


Kokias grėsmes kelia DI?
Su DI sistemų naudojimu dažnai siejamos tokios grėsmės kaip šališkumas, sąžiningumo, skaidrumo ir atskaitomybės stoka, darbo vietų praradimas, etikos standartų neatitinkantis naudojimas ir sprendimų priėmimas, žalingas poveikis aplinkai ir t. t.
Be išvardytų, kyla ir kita didelė grėsmė – kad DI naudojimas gali būti paremtas netinkamomis praktikomis, sudarančiomis galimybę rinkti didelius duomenų kiekius, tarp kurių būtų ir asmeninė informacija, surinkta be šių duomenų savininko sutikimo. DI taip pat gali turėti platų visuomeninį poveikį, kuris darytų įtaką asmenų teisei į darbą, sveikatos apsaugą ar saugią aplinką. Pavyzdžiui, integruojant DI į įvairias pramonės šakas gali būti pakeista daug darbo vietų, nes automatizuotos sistemos efektyviau atliks rutinines užduotis, kurias anksčiau atlikdavo žmonės. Teisinėmis priemonėmis ir atsakingu planavimu būtų galima užtikrinti, kad nekiltų visuotinis nedarbas. Vienas iš galimų variantų – investicijos į perkvalifikavimo programas, kurios padėtų darbuotojams perprasti technologijas ir pereiti prie naujų veiklų.
Todėl labai svarbu užtikrinti, kad DI išliktų kontroliuojamas ir tinkamai prižiūrimas. Norint subalansuoti DI veikimą ir žmogaus kontrolę bei priežiūrą, reikia užtikrinti, kad būtų išvengta nepageidaujamų padarinių ir DI kūrimas bei diegimas atitiktų visuomenės vertybes ir gerovę. Naudojant DI pagrindu veikiančias sistemas turi būti išsaugoma pagarba žmogaus teisėms, nepažeidžiamas asmens privatumas, užkertamas kelias šališkumui ir diskriminacinei praktikai įsigalėti. O tam reikalingi patikimi teisiniai mechanizmai.
DI reguliavimo gaires siūlo įvairios organizacijos
Pagrindiniai DI reguliavimo principai –tai skaidrumas, atskaitomybė ir teisingumas. DI sistemų kūrimas ir veikimas turi būti skaidrūs, o sprendimų priėmimo procesai turi būti atskleidžiami tam, kad galėtų būti patikrinami ir suprantami DI vartotojams. Tačiau atkreiptinas dėmesys, kad reikia subtiliai derinti skaidrumo poreikį ir komercinių paslapčių bei intelektinės nuosavybės teisių apsaugą. Taip pat labai svarbu apibrėžti aiškius atskaitomybės reguliavimo kriterijus, pagal
Svarbu suderinti DI kūrimą su žmogaus teisių, skaidrumo ir atskaitomybės principais.
kuriuos būtų nustatoma, kas yra atsakingas, kai DI sistemos padaro žalą ar pažeidžia kitų asmenų teisėtus interesus. Be to, DI turėtų būti kuriamas taip, kad būtų išvengta šališkumo ir diskriminacijos naudojant įvairius duomenų rinkinius.
Tarptautinės organizacijos jau inicijavo svarbius veiksmus šia kryptimi. Etikos gairės, parengtos įvairių tarptautinių organizacijų, atliko lemiamą vaidmenį formuojant teisinius reguliavimo principus DI srityje. Iš esmės visose gairėse pabrėžiama, kad svarbu suderinti DI kūrimą su žmogaus teisių, skaidrumo ir atskaitomybės principais. Ekonominio bendradarbiavimo
ir plėtros organizacija 2019 m. pristatė DI principus, kurie atspindi į žmogų orientuotą požiūrį. UNESCO 2021 m. patvirtino Rekomendaciją dėl dirbtinio intelekto etikos, kurioje pažymėjo, kad žmogaus teisių ir orumo apsauga yra kertinis akmuo, grindžiamas pagrindinių principų, tokių kaip skaidrumas ir teisingumas, plėtojimu, niekada nepamirštant žmogiškosios DI sistemų priežiūros svarbos. Be to, 2019 m. Europos Komisija paskelbė Patikimo DI etikos gaires, kuriomis siekiama brėžti į žmogų orientuotas ir žmogaus teises saugančias DI kūrimo kryptis.
2023 m. pabaigoje Jungtinės Tautos sušaukė aukšto lygio patariamąją
instituciją DI klausimais, kuri paskelbė tarpinę ataskaitą „DI valdymas žmonijos labui“. Be to, per Didžiojo septyneto (G7) aukščiausiojo lygio susitikimą, kuriam pirmininkavo Japonija, buvo inicijuotas Hirosimos DI procesas, kurio tikslas – Tarptautinis pažangias DI sistemas kuriančių organizacijų elgesio kodeksas.
Svarbiausi į žmogų orientuoto DI reguliavimo principai
Kadangi moralinių aspektų vertinimas yra labai sudėtingas, bandant nuspręsti, kuriais etikos principais yra svarbiausia vadovautis kuriant DI,

Būtina sukurti patikimą DI valdymo sistemą, nestabdant naujovių ir technologijos pažangos.
nuomonės išsiskiria. Pavyzdžiui, pagal Europos Komisijos parengtas Patikimo DI etikos gaires svarbiausia yra pagarba žmogaus autonomijai, žalos prevencija, teisingumas ir paaiškinamumas.
Norint sustiprinti vartotojų pasitikėjimą ir skatinti kritinį požiūrį, kai naudojamasi DI sistemomis, itin svarbus yra jų paaiškinamumas. DI veikimo procesai turėtų būti skaidrūs, o sugeneruoti sprendimai pakankamai suprantamai paaiškinami vartotojams.
Galiausiai į žmogų orientuotų principų integravimas į teisines ir reguliavimo sistemas, reglamentuojančias DI, bus labai svarbus siekiant įgyvendinti šios technologijos transformacinį potencialą, o kartu užtikrinant pagrindines asmenų ir visos visuomenės teises ir gerovę.
Iš esmės į žmogų orientuotas DI reiškia kūrimą ir diegimą DI sistemų, kuriose svarbiausia yra žmonių poreikiai ir gerovė. Šis požiūris pabrėžia skaidrumą, atskaitomybę, sąžiningumą ir įtraukumą, o kartu siekia užtikrinti, kad DI atitiktų pagrindines žmogaus teises ir etikos principus.
Europos Komisijos parengtose Patikimo DI etikos gairėse pateikiama išsami sistema, kurią sudaro pagrindiniai principai, tarp jų pagarba žmogaus autonomijai, žalos prevencija, teisingumas ir paaiškinamumas.
DI padeda spręsti opias problemas
Bėgant metams, atsirado daugybė produktus ir programinės įrangos sprendimus siūlančių kompanijų, teigiančių, kad DI įtrauktas į jų pasiūlymus ir garantuoja didžiulį proveržį įvairiose srityse. Ypač plačiai paplito interneto svetainėse naudojami automatizuoti atsakikliai klientams, paremti DI technologija, taip pat grafinio dizaino paslaugos. Daugybė įmonių drąsiai skelbia apie DI panaudojimą, investuoja į DI produktų kūrimą ir diskutuoja apie galimą DI poveikį visuomenei.
Dėl DI pažangos atsirado galimybių kurti inovatyvias priemones ir metodus, kurie padėtų spręsti kai kurias opias pasaulio problemas, tokias kaip,
pavyzdžiui, ankstyva ligų diagnostika, maisto sauga ir tvarus ūkininkavimas, asmeniniams poreikiams pritaikytas mokymasis ir švietimo prieinamumas, ir taip prisidėtų prie visuomenės gerovės, atitinkančios Jungtinių Tautų 17 darnaus vystymosi tikslų. Dar viena aktuali iniciatyva yra „DI socialinei gerovei“ („AI for Social Good“, AI4SG).
Šia iniciatyva siekiama kurti tarpdalykines partnerystes, orientuotas į DI taikymą, kurios padėtų įgyvendinti minėtus darnaus vystymosi tikslus, taip pat skatinti sėkmingą ilgalaikį DI tyrėjų ir įvairių taikymo sričių ekspertų bendradarbiavimą.
Dauguma vyriausybių pasisako už atsakingą ir etišką DI kūrimą bei taikymą, pripažindamos, kad būtina sukurti patikimą DI valdymo sistemą, nestabdant naujovių ir technologijos pažangos.
Europos Sąjunga parodė lyderystę ir ryžtingai ėmėsi reguliuoti DI taikymą, pirmenybę teikdama privalomoms taisyklėms. Priimtas DI aktas, kuriuo siekiama sukurti išsamią reguliavimo sistemą, užtikrinančią saugų ir etišką DI sistemų diegimą ir naudojimą Europos Sąjungoje. Ši teisinio reguliavimo iniciatyva yra labai svarbi apsaugant žmogaus teises ir skatinant atsakomybę DI srityje.
Nacionaliniu lygmeniu daugiausia dėmesio skiriama gairėms įgyvendinti ir priežiūros bei patariamiesiems organams steigti: JAV vyriausybė įsteigė Nacionalinį DI patariamąjį komitetą, Kanada įgyvendino įvairias priemones, pavyzdžiui, algoritminio poveikio vertinimą ir gaires dėl paslaugų ir skaitmeninių technologijų, o Japonija rengia su DI susijusias rekomendacijas bendrovėms.
Kas atsakys už DI padarytą žalą?
Sukurti veiksmingą ir į žmogų orientuotą DI reguliavimo metodą yra sudėtingas uždavinys. Būtina galimos šių technologijų naudos, rizikos sumažinimo poreikio ir visuomenės gerovės pusiausvyra. Politikai, pramonės lyderiai ir pilietinė visuomenė turi bendradarbiauti, kad nustatytų aiškias gaires, priežiūros mecha-

nizmus ir atskaitomybės priemones, užtikrinančias, kad DI būtų kuriamas ir diegiamas atsakingai ir etiškai.
Nors ateities kelias gali būti nelengvas, būtinybė plėtoti į žmogų orientuotą požiūrį ir DI reguliavimą yra aiški. To nepadarius kyla pavojus, kad DI gali padidinti visuomenės nelygybę, pakenkti demokratinėms vertybėms ir pažeisti pagrindines žmogaus teises. Vadovaudamiesi bendradarbiavimu grindžiamu daugelio suinteresuotųjų šalių požiūriu į DI valdymą, galime siekti, kad būtų įgyvendintas šių transformuojančių technologijų pažadas, o kartu būtų laikomasi į žmogų orientuotų vertybinių principų ir darnaus vystymosi tikslų.
Vienas pagrindinių iššūkių šioje srityje yra nustatyti, kas turėtų būti laikomas
atsakingu, kai naudojant DI sistemas padaroma žala. Ar tai turėtų būti DI technologijų kūrėjai, ar savininkai, ar vartotojai? Šis klausimas ne tik yra esminis su DI susijusiai teisinei ir etinei sistemai, bet ir turi didelę reikšmę tolesniam DI technologijų plėtojimui.
Europos Parlamentas ir Taryba parengė Direktyvos dėl nesutartinės civilinės atsakomybės taisyklių pritaikymo DI (Atsakomybės už DI direktyva) projektą. Ši direktyva galėtų būti puiki priemonė, padedanti spręsti sudėtingas atsakomybės už DI sistemų padarytą žalą nustatymo problemas. Siūlomoje direktyvoje siekiama patobulinti teisinę sistemą, kad ieškovams būtų lengviau reikalauti atlyginti DI sistemos padarytą žalą. Direktyvoje vadovaujamasi minimalaus suderi -
nimo principu, taigi valstybės narės gali integruoti į savo galiojančias civilinės atsakomybės sistemas direktyvos nuostatas su savo papildymais. Taip būtų galima suderinti atsakomybės taisykles visoje Europos Sąjungoje. Kol ši direktyva nepriimta, aiškių taisyklių dėl DI sistemų sukeltos žalos neturime ir belieka vadovautis galiojančiais teisės aktais, kuriuose bendrai aprašoma deliktinė atsakomybė ir jos taikymas.
Mindaugas Linkaitis
Vilniaus universiteto Gyvybės mokslų centras
Mokslininkai pastaruoju metu vis dažniau ir intensyviau tyrinėja žmogaus mikrobiotą ir vis geriau supranta jos įtaką žmogaus sveikatai. Bene labiausiai pažengę yra žarnyno ir odos mikrobiotos tyrimai, tad ir žinių apie jas turime daugiausia. Ar gali būti, kad plaučių ir kvėpavimo takų sveikatą taip pat smarkiai lemia jų mikrobiota? Ar paveikus ją būtų galima išgydyti tam tikras plaučių ligas? Apie tai pasakoja kvėpavimo takų mikrobiotą tyrinėjantys
Vilniaus universiteto Gyvybės mokslų centro mokslininkai dr. Julija Armalytė, dr. Aleksandras Konovalovas ir Inovatyvios medicinos centro mokslininkė dr. Rūta Aldonytė.

Sveiki plaučiai – sterilūs?
Mokslininkai
dirba ieškodami konkrečių mikrobiomo
sudėčių, kurios galėtų būti diagnostinis
įrankis ir tapti taikiniais gydant.
Smalsu, kodėl pastaruoju metu vis daugiau kalbama apie žarnyno mikrobiotą – ne tik mokslinėje literatūroje, bet ir žiniasklaidoje, apie tai savo vaizdo įrašuose ėmė kalbėti net įtakotukai, o štai kvėpavimo takų, ypač apatinės dalies – plaučių, mikrobiotos tema – reta. Dr. J. Armalytė visų pirma siūlo plačiau pažvegti į mikrobiotos, tam tikroje erdvėje gyvenančios tarpusavyje susijusių mikroorganizmų visumos, kontekstą. Mikrobiotos sudėtis ir įvairovė įprastai nustatoma nuskaičius visų mikroorganizmų genetinę medžiagą, ir tada ji jau vadinama mikrobiomu, t. y. visų mikroorganizmų genų visuma toje organizmo vietoje. Pasak mokslininkės, žarnyno mikrobiota gausiai tiriama dėl dviejų priežasčių: dėl jos svarbos (virškinamajame trakte gyvenantys mikroorganizmai labai svarbūs žmogaus sveikatai, maisto medžiagų metabolizavimui, vitaminų gamybai, imuniniam atsakui ir kt.) ir mikroorganizmų, randamų žarnyne, kiekio – tai gausiausia žmogaus kūno mikrobiota. Žarnyne gyvena šimtai ar net tūkstančiai mikroorganizmų rūšių, o bendras mikroorganizmų skaičius netgi viršija visų žmogaus ląstelių skaičių. Kitų žmogaus kūno dalių mikrobiotos savi-
tos, atlieka ir savitas funkcijas, tačiau jos ne tokios gausios ir sunkiau tiriamos dėl grynai techninių priežasčių. Dr. J. Armalytė atkreipia dėmesį, kad smarkiai pasistūmėta visų su žmogumi susijusių mikrobiomų tyrimuose: jų metu atskleista, kiek daug ir kokių įvairių mikroorganizmų randama žmogaus kūno paviršiuje ir ertmėse. „Mokslininkai jau kurį laiką dirba ieškodami konkrečių mikrobiomo sudėčių, kurios galėtų būti diagnostinis įrankis ir tapti taikiniais gydant. Prie šių tyrimų prisidedame ir mes. Įdomu tai, kad plaučiai – vienas paskutinių organų, kurių mikrobiotą imta tyrinėti žmogaus mikrobiomo tyrimų metu. Iš dalies tai susiję su dar ne taip seniai paneigtu įsitikinimu, kad sveiki plaučiai yra sterilūs. Ilgai manyta, kad juose negyvena mikroorganizmai ir tik ligos atveju ten įsikuria ir pradeda daugintis bakterijos“, – pasakoja Gyvybės mokslų centro mokslininkė. Ji aiškina taip atsitikus todėl, kad pirmieji mikroorganizmų įvairovės tyrimai buvo atliekami klasikiniais mikrobiologiniais metodais, t. y. mėginius sėjant ant mitybinės terpės. Dabar jau žinoma, kad šiais metodais galima aptikti tik apie 1 proc. mikroorganizmų, nes dauguma jų nepasiduoda kultivuojami laboratorijos sąlygomis.
Tobulėjant tyrimo metodams, atsirandant masiniams genų sekoskaitos tyrimams (kurie skirti visai mikrobiotos sudėčiai nustatyti ir įvertinti), tapo įmanoma aptikti ir sunkiai kultivuojamus mikroorganizmus. Pasirodė, kad ir sveikuose plaučiuose nuolat gyvena mikroorganizmai, nors jų gausa ir įvairovė daug mažesnė nei viršutiniuose kvėpavimo takuose (pvz., nosyje, burnos ertmėje).
Mokslininkai aprašė su ligomis siejamus specifinius mikrobiomus
Gyvybės mokslų centro mokslininkas dr. A. Konovalovas teigia, kad kvėpavimo organuose gyvenančių mikroorganizmų tyrimus riboja kiek sudėtingesnės nei kitur aplinkybės: sunku pasiekti atokesnes kvėpavimo sistemos dalis, sėkmingai (neužteršus iš kitų organizmo vietų) paimti mėginius, mikroorganizmų bendruomenės yra negausios ir dažnai besikeičiančios, nėra standartizuotų testų. Nepaisant trukdžių, mokslininkams pavyko aprašyti su ligomis siejamus specifinius mikrobiomus, įvertinti ne tik prokariotinių organizmų (bakterijų), bet ir rečiau analizuojamą grybelių įtaką. Taip atsirado sąvokos bronchinės astmos mikrobiomas, lėtinės obstrukcinės plaučių ligos mikrobiomas, cistinės fibrozės mikrobiomas ir t. t. Kiekvienas iš jų gali suteikti informacijos apie kvėpavimo organų būklę, sveikatą ar ligos pažangą, padėti numatyti ligos suvaldymo perspektyvas.
Dr. R. Aldonytė atkreipia dėmesį, kad galimi sergamumo plaučių ligomis skirtumai gali atsirasti dėl skirtingos gyvenamosios vietos – genetinių skirtingose pasaulio dalyse gyvenančių žmonių skirtumų, gyvenimo būdo
ypatybių ar aplinkos sąlygų. Taigi, pvz., Didžiosios Britanijos ir Kinijos gyventojų kvėpavimo organų mikrobiomų sudėtis gali būti labai skirtinga. Be to, viršutinių kvėpavimo takų, ypač nosies, mikrobiomas yra labai nepastovus, o tai daro tyrimą dar sudėtingesnį. Mikrobiomo sudėties ir įvairovės įtaka tyrinėjama daugelio kvėpavimo ligų kontekste, tačiau aiškių priežastinių ryšių kol kas nerasta ir mikrobiomo sudėtis tebėra menkai ištirta ligų diagnostikos tikslais.
Žmogaus mikrobiomos tyrimų metu Vilniaus universiteto mokslininkai tyrė apatinių ir viršutinių kvėpavimo takų mikrobiomo sudėtį sveikų ir sergančių bronchektazine liga žmonių mėginiuose. Viena iš apatinių kvėpavimo takų tyrimo problemų – reikalinga invazyvi mėginio paėmimo procedūra. Kadangi, kaip minėta, į plaučius mikroorganizmai patenka per viršutinius kvėpavimo takus, dalis mikroorganizmų tarp viršutinių ir apatinių kvėpavimo takų gali sutapti. Palyginus mikroorganizmų įvairovę, pvz., nosyje ar nosiaryklėje (iš šių vietų mėginiai paimami nesunkiai, procedūra neinvazyvi), su jų įvairove plaučiuose ir suradus tam tikrą ryšį, galima tikėtis sukurti mažiau invazyvius kvėpavimo takų sveikatos stebėjimo įrankius. Be to, buvo tiriami ryšiai tarp mikrobiomo sudėties ir uždegimo rodiklių tyrimo dalyvių kraujo serume bei seilėse. Šiame klinikiniame tyrime, gavus Lietuvos regioninio bioetikos komiteto leidimą, dalyvaujantys savanoriai buvo apklausiami ir dėl jų gyvenamosios vietos, žalingų įpročių, profesijos ir darbovietės, augintinių namuose ir kitų poveikių. Visos šios aplinkybės gali turėti įtakos mikrobiomo sudėčiai.
„Mes tyrėme pacientų, sergančių bronchektazine liga, mikrobiomą. Tai labai glaudžiai su bakterine infekcija susijusi liga, gydoma antibiotikais. Mūsų radiniai leidžia teigti, kad apatinių kvėpavimo takų ir plaučių mikrobiomai, kuriuose įsivyrauja viena bakterijų rūšis (dažnai aptinkamos Pseudomonas arba Haemophilus), tampa ligos raidos varikliais, o dėl bakterijų turimo ar įgyjamo atsparumo antibiotikams reikia vis galingesnių antibiotikų ligos paūmėjimams suvaldyti. Kartu pastebėjome, kad lengvesni ir mažiau pažengę (ir mažiau antibiotikais gydyti) ligos atvejai dar turi sąlyginai pakankamą, sveikų asmenų mikrobiomą primenančią mikroorganizmų įvairovę apatiniuose kvėpavimo takuose ir plaučiuose. Mes darome išvadą, kad išlaikyti įvairų, ne vieno mikroorganizmo dominuojamą apatinių kvėpavimo takų ir plaučių mikrobiomą yra labai svarbu ligos eigai ir prognozei, todėl antibiotikai turi būti skiriami ypač atsargiai“, – apibendrina mokslininkė dr. J. Armalytė.
Kuo naudinga plaučiuose gyvenančių mikroorganizmų įvairovė?
Mokslininkai sutaria, kad, nustačius kvėpavimo takų mikrobiomo sudėtį, įvairovę, potencialius patogenus, galima nustatyti ir kokią įtaką jis daro kvėpavimo organų bei viso organizmo sveikatai. Suprantama, kad išsiaiškinus, kokia yra kvėpavimo takų mikrobiota, galima nustatyti ir kokią naudą ji teikia kvėpavimo takams bei visam žmogaus organizmui.
Pirmiausia pakalbėkime apie mikrobiotos naudą kvėpavimo sistemai. Žinoma, kad gausi ir įvairi mikrobiota neleidžia įsivyrauti patogenams. Kaip ir kitose kūno vietose, kvėpavimo
organuose pirmiau įsikūrusių mikroorganizmų užimta niša tampa nepasiekiama patogenams, ir atvirkščiai –laisva, tuščia erdvė skatina nepalankių ar pavojingų rūšių įsivyravimą.
Be to, mikroorganizmai išskiria daugybę veiksnių ir moduliuoja vietinius imuninius atsakus, epitelio ir endotelio pralaidumą ir daugybę kitų procesų, pavyzdžiui, veikia anatominį kvėpavimo organų formavimąsi. Tirtoms pelėms, augintoms su steriliais kvėpavimo takais, nepakankamai vystėsi plaučiai ir susidarė mažiau veikiančių alveolių, o įterpus komensalinių bakterijų (mikroorganizmų, nuolat gyvenančių šeimininko organizme ir mintančių jo maisto medžiagų likučiais) – alveolių vystymasis normalizavosi. Panašiai nuo bakterijų buvimo priklauso ir viršutinius kvėpavimo takus supančių limfoidinių organų (tonzilių) formavimasis, taigi po gimimo įkvėpti ir kvėpavimo takus kolonizavę mikroorganizmai yra labai svarbūs žmogaus kvėpavimo organų anatomijai ir funkcijoms susiformuoti per pirmuosius trejus gyvenimo metus.
Mikrobiota aktyviai dalyvauja formuojantis kvėpavimo takų aukštams, kur kartu su anatominiais ir fiziologiniais gradientais (nosis, nosiaryklė, burnaryklė, gerklos, trachėja,
bronchai, plaučiai) susidaro ir mikrobiotos gradientai. Tai specifinės mikroorganizmų bendruomenės (nišos), kurios, prisitaikiusios prie vietinių pH, drėgmės, deguonies, anglies dioksido ir temperatūros gradientų, formuoja papildomus barjerus taršai bei patogenams ir saugo „vartus“ link plaučių. Į viršutinius kvėpavimo takus bakterijos, virusai ir grybeliai nuolat patenka iš aplinkos, o apatinių kvėpavimo takų mikrobiota mikroorganizmais pasipildo iš viršutinių takų. Dalis mikroorganizmų gali atkeliauti iš aplinkos tiesiai į apatinius kvėpavimo takus ant mažiausių oro taršos dalelių – tai ypač aktualu didesnės taršos regionuose. Vienaip ar kitaip kvėpavimo takus pasiekiantys ir juose besikuriantys mikroorganizmai formuoja savitas nišas su sudėtingais tarpusavio santykiais ir hierarchija, o jų sudėtis ir įvairovė daro poveikį šeimininko sveikatai.
Mikroorganizmų įvairovės mažėjimas lems sunkesnę ligos eigą
Pasak dr. J. Armalytės, su šeimininko sistemomis kvėpavimo takų ir plaučių mikrobiota bendrauja per vietines imunines ląsteles ir epitelį. Per kontaktus su mikroorganizmais
Išlaikyti įvairų, ne vieno mikroorganizmo dominuojamą apatinių kvėpavimo takų ir plaučių mikrobiomą yra labai svarbu ligos eigai.


Žmogaus mikroorganizmai.
Jovilės Raudoniūtės iliutracija
formuojasi imuninės sistemos tolerancija – žmogaus imuninė sistema „nepuola“ draugiškų ir naudingų mikroorganizmų. Anksti patekę įvairūs mikroorganizmai labai svarbūs ilgalaikei tolerancijai susidaryti, o tolerantiškoje aplinkoje formuojasi visavertės mikroorganizmų bendruomenės.
Kaip mikrobiotą galima panaudoti gydant ligas?
Pasak dr. R. Aldonytės, remdamiesi vis gausesniais duomenimis ir įrodymais, daugelis medicinos ir mokslo bendruomenės atstovų siekia mikrobiomo tyrimus įdiegti į klinikinę praktiką – ne tik diagnostikai, bet ir ligoms gydyti.
Keičiant mikrobiotą jau gydomi sunkaus infekcinio viduriavimo epizodai, siekiama pagerinti opinio kolito pacientų būklę, pakeisti autizmo klinikinę eigą ir vėžio pacientų terapines galimybes.
„Pakankamai įvairių mikroorganizmų anksti patekus į bręstančius kvėpavimo takus padedami pamatai kvėpavimo organų ir mikrobiotos nišų sveikatai ateityje. Normalios mikrobiotos sudėties pasikeitimas (disbiozė), atsirandantis dėl antibiotikų vartojimo ir kitų situacijų, suardo šią pusiausvyrą ir tai dažnai lemia ilgalaikius ir nesuvaldomus infekcinių susirgimų protrūkius, lėtinių kvėpavimo organų ligų paūmėjimus, alergines reakcijas. Vis dėlto visoms šioms ligoms gydyti ir jų prevencijai iki šiol nėra pasitelkiama priemonių ir strategijų, kurios spręstų mikrobiotos atkūrimo problemas“, – pažymi dr. J. Armalytė. Be to, kalbant apie lėtinės obstrukcinės plaučių ligos, cistinės fibrozės ar bronchinės astmos mikrobiomų tyrimus, mokslininkams vis dar stinga vienodos vertinimo sistemos, t. y. naudojami skirtingi tiriamosios medžiagos paėmimo metodai, analizės metodikos. Tačiau, dr. A. Konovalovo teigimu, mikroorganizmų įvairovės mažėjimas ir tam tikros rūšies bakterijų gausėjimas lemia sunkesnę ligos eigą, dažnesnius ir sunkesnius paūmėjimus, be to, turi įtakos ir plaučių funkcijai. Dažniausia to priežastis – vienų bakterijų (Proteobacteria, Actinobacteria ) įsivyravimas ir kitų (Firmicutes, Bacteroidetes) nykimas, neretai lydimas su oportunistinėmis ligomis susijusių bakterijų ( Staphylococcus , Moraxella , Haemophilus rūšių) gausėjimo ir sveikai mikrobiotai priskiriamų bakterijų ( Lactobacillus , Streptococcus , Veillonella , Prevotella , Alloprevotella , Porphyromonas) nykimo. Įvairios plaučių ligos gali pasižymėti specifine mikrobiomo sudėtimi, tačiau tvirtiems priežasties ir padarinio ryšiams nustatyti šiuo metu sukauptų mokslinių tyrimų duomenų dar nepakanka.
Mokslininkės teigimu, keičiant mikrobiotą jau gydomi sunkaus infekcinio viduriavimo epizodai, siekiama pagerinti opinio kolito pacientų būklę, pakeisti autizmo klinikinę eigą ir vėžio pacientų terapines galimybes. Kai kurie iš šių gydymo būdų jau yra patvirtinti JAV Maisto ir vaistų administracijos ir Europos vaistų agentūros, kiti – dar pakeliui. O daugybė kitų panaudojimo sričių kol kas išbandomos klinikiniuose ir ikiklinikiniuose tyrimuose. Vis dėlto absoliučia dauguma šių būdų siekiama koreguoti žarnyno mikrobiotą, keletas taikomi odos mikrobiotai ir kitoms sritims. Kvėpavimo takams ar plaučiams skirtų realių mikrobiomo tyrimo panaudojimo strategijų iki šiol nėra – nei diagnostikai, nei terapijai, nei profilaktikai. „Mes vykdėme savo tyrimus siekdami priartinti mokslines žinias ir patirtis prie klinikinio panaudojimo. Spėjame, kad ateityje nosies ar bronchų nuoplovų mikrobiomo tyrimai bus naudojami ligų diagnostikai ir kad atsiras probiotikų kvėpavimo takams, kurie papildytų ir pagerintų dažnai niokojamą (oro tarša, tabako produktais, antibiotikais, vaistais ir t. t.) kvėpavimo organų mikrobiotą. Tai būtų reikalinga intervencija daugeliui šiuolaikinių miestiečių, dažnai virusinėmis infekcijomis sergantiems vaikams ir kai kurių specifinių profesijų atstovams. Be to, remiantis mūsų tyrimų rezultatais, galima teigti, kad žmonės, kvėpuojantys oru, kuriame gausu augalinės kilmės mikroorganizmų (o augalai irgi turi savo mikrobiomus), turi įvairesnę nosies mikrobiotą. Ir tai leidžia kelti hipotezę, kad miško terapija ar panašios intervencijos greta kitų veiksnių gali turėti teigiamą praturtinantį poveikį kvėpavimo takų mikrobiotai“, – mikrobiomo tyrimų perspektyvas atskleidžia dr. R. Aldonytė.
SPECTRUM, 2024 rugsėjis, Nr. 2 (40)
Žurnalą leidžia Vilniaus universiteto Komunikacijos ir rinkodaros skyrius
Turinio redaktorė Liudmila Januškevičienė
Kalbos redaktorė Ilma Dunderienė
Dizaineriai Tadas Razmas, Agnė Legeckaitė
Fotografas Ugnius Bagdonavičius
Iliustratorė Ūla Šveikauskaitė
Viršelyje vaizduojama, kaip Vilniaus universiteto mokslininkai tiriamųjų kraujyje ieško specifinių biožymenų, galinčių ateityje padėti identifikuoti žmones, linkusius į savižudybę. Ūlos Šveikauskaitės iliustracija
Adresas: SPECTRUM, Vilniaus universitetas, Komunikacijos ir rinkodaros skyrius, Universiteto g. 3, LT-01513 Vilnius
Tel. (8 5) 236 6053, http://naujienos.vu.lt/spectrum
Dėl publikacijų žurnale kreiptis el. paštu spectrum@cr.vu.lt
Leidinys platinamas nemokamai
Spausdino uždaroji dizaino ir leidybos akcinė bendrovė „KOPA“
Tiražas 1000 egz. ISSN 2783-8226
© VILNIAUS UNIVERSITETAS, 2024
Platinant šio leidinio informaciją nuoroda į SPECTRUM būtina
